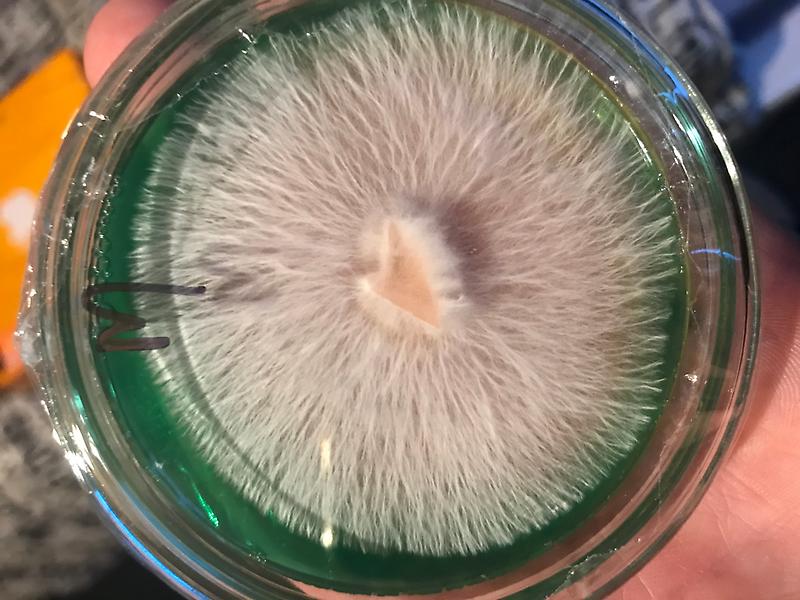

chat
send private message
SmorganWeedman
send


message sent

joined oct 2019
share SmorganWeedman and generate bitcoin with reference codes.
9 topics on SmorganWeedman
15 posts
+31 votes
£200 down the drain

£200 down the drain
£200 down the drain with Drugs Inc UK, got sent unsmokable shit weed, week later got a reship that was worst than the first one, tastes like soap, burn jet black nasty ash, zero high,
Now over 48hrs with no response from vendor, should i dispute?
Now over 48hrs with no response from vendor, should i dispute?

Yeah ive basically thrown more of my money away here too. They might send out reships but 1. Thats not the weed we paid for and 2. We pay transaction fees to both buy and send the btc ....thats not coming back to us...i have 2 jars of their bad weed, ready for the bin. And preparing for another. Great.

Just to update, received reship within 2 days, worse quality than the dog shit if you can believe that, anyway got a refund so count your blessings aye, still gagging for a proper spliff >.>

The white Tahoe cookies burns clean and is a creeper. I smoked 2 fat ones thinking this ain't up to much. Then the next thing it was 4 hours later and I'm wielded to the couch! Lol. I got the Banana coming really hope it isn't like the pic of the black ash joint....ahhhh

Any more thoughts on the White Tahoe? Was thinking of picking some up... everything I’ve had in the last 2 months on here has been shit, like proper shit so been buying locally but always had good smoke off of DI and white Tahoe was deffo somthing that I was looking forward to smoking... so a bit meh then?

I'm gonna cry if its shit, there's like a whole page of info on how nice this crop and strain is! so I'll be wanting my money back of it's not clean! Unclean weed or smoke with black ash should not be sold, irrespective of price, you can't polish a turd.. and the price was for premium bud

Wow from DI? Surprising, I’ve had one bad smoke off them so far but it was pretty bad the rest has been some of the best I’ve had on here...
What was the weed if you don’t mind sharing?
What was the weed if you don’t mind sharing?

5 posts
+12 votes
Decarb bud before smoking?

Decarb bud before smoking?
Does converting the thca to thc by decarbing before smoking have any benifit? could the thc being pre converted before the ignition result in more thc in the inhale?

Unless you roll particularly skinny joints, the burning cherry/embers will be heating unburned bud further down the spliff - effectively decarbing it before it ignites. I think you'd just lose terps/flavour rather than gain any benefit.

Found this on a site showing how temp vs time can make the weed stronger for edibles, the strain they used had around 15% thc content.

2 posts
+3 votes
Bitcoin price

Bitcoin price

$ amount not matching the crypto price, what do? dont wanna feel like im getting ripped off.

5 posts
+17 votes
Neural link on the horizon

Neural link on the horizon


Plug me in daddy elon! sooner i can live full time in virtual reality the better.

Elon is genuinely one of those people that I just cannot put my finger on. No denying the man is a genius but half the shit he does (like tanking his stock through tweets or naming his daughter a fucking maths equation) I feel he does on purpose, just because he is bored of the real world.
Maybe we all just live in his simulation and he controls us like Sims? Maybe I'm too high?.....or not high enough.....
Sorry, I'm not sure how I feel about Neural link available to the masses but Elon does make me giggle. The brilliant square-headed little weirdo
Maybe we all just live in his simulation and he controls us like Sims? Maybe I'm too high?.....or not high enough.....
Sorry, I'm not sure how I feel about Neural link available to the masses but Elon does make me giggle. The brilliant square-headed little weirdo

I thought we were in it lol
Seen a clip of that today about him explaining the potential of this neural link....mad
Seen a clip of that today about him explaining the potential of this neural link....mad

14 posts
+35 votes
Stolen trichomes?

Stolen trichomes?
Are vendors dry sifting there buds before selling? a recent order had zero pollen on the outside, like it was literally striped clean, dident leave a single speck in the bag, thats not natural.
What are yall thoughts on this?
What are yall thoughts on this?

If its half decent weed you should be able to squish it between your fingers and it sticks them together. If your fingers are not sticky afterwards then it's either poor weed or its been messed with.

Its either really dry the thc has come of or its been squashed in the post they would effect the thc i dont think you can drysift buds unless its dust but you can get blasted weed where its been made for shatter then the leftover weed is resold

Any exposed surface area will inevitably lose its trichomes.
This is why i like the big buds cause of all the trichomea inside untouched
I would guess the answer is no as it wouldnt really be getting much...now on the other hand like dust/shake could easily be stripped and sold on
This is why i like the big buds cause of all the trichomea inside untouched
I would guess the answer is no as it wouldnt really be getting much...now on the other hand like dust/shake could easily be stripped and sold on

That is the what happens
Not saying this is your case...whats wrong with you, i was only being friendly
Outside trichomes can be knocked of easily if handled alot or the bud is dry...its a well known fact
Not saying this is your case...whats wrong with you, i was only being friendly
Outside trichomes can be knocked of easily if handled alot or the bud is dry...its a well known fact

Hypothetically, if your bud had been sifted before being sold to you and you knew beyond doubt because it was done infront of you, how would you feel about it?

Would be interested to know where you found best bud was on here mate or is it simply have to pay double price for Cali import to feel it hit me in the face? Cheers man

As in have you found some fire bud for a normal price on here? Like I've had a couple small orders and the weeds looked and tasted nice but not really done much else for me. Like I haven't had that feeling like you get from a joint in Dam for a long time now you know what I mean? Might try JJ not tried him yet

I have seen blasted bud on here before.. so you aren't wrong. even low grade bud will have at least a small amount of visible trichomes.

23 posts
+51 votes
i seen it all

i seen it all
if its worth watching i seen it, tv shows movies, go ahead try me
now i have nothing to binge watch i must face sad reality again :(
now i have nothing to binge watch i must face sad reality again :(

I've just downloaded a show called Oz to re-watch.
Class American Prison Drama
If I ever get myself a Zombie Stick I might try Coronation Street on catch up Season 1 Episode 1 :-)
Class American Prison Drama
If I ever get myself a Zombie Stick I might try Coronation Street on catch up Season 1 Episode 1 :-)

Oh wow Oz looks very watchable thanks :D
You gotta have a screw loose to watch those soaps mate, imo
You gotta have a screw loose to watch those soaps mate, imo

Definitely give Oz and the Wire a look, well worth it and tons of episodes of both to get lost in. Also Twin Peaks!

https://m.imdb.com/title/tt2397535/
Predestination. Good sci-fi mystery mindfuck movie.
Predestination. Good sci-fi mystery mindfuck movie.

I watched the first few episodes and couldn't get into it, might have to give it a second look.

There are 5 series of Merlin on BBC iplayer. It is addictive. For the last month I have been watching 1 or 2 episodes before going to bed. Watched the last one two days ago.

That show really dident appeal to me at first glance but since you recommend it so highly ill give it a chance after Oz and Godless, thanks :)

It is difficult to recommend something. We are all different.You either love or hate series like that :-)

Treme - is usually a series nobody has heard of but I really enjoyed :)
Southland - also a good series that went under the radar
Recently - really liked Doom Patrol
Southland - also a good series that went under the radar
Recently - really liked Doom Patrol

face reality my friend, it's more fantastical than the watered down film versions of us :)

8 posts
+17 votes
Ruined by Rud?

Ruined by Rud?
In the last 20 years there has been an explosion of Ruderalis cross strains AKA autoflowers, its clear to see why this has taken place as it gives bigger yields and faster grow times.
My question is have the classic strains lost something from being crossed with the woody and heavy indica Ruderalis?
and further more are there any pure classics left?
My question is have the classic strains lost something from being crossed with the woody and heavy indica Ruderalis?
and further more are there any pure classics left?

https://therealseedcompany.com/ apparently these lot sell genuine landrace seeds. Was thinking of hiding some in the fridge for when the world sorts out it views in growing

Not just autos, feminised seeds have destroyed thousands and thousands of possible phenotypes. Stabilised seeds being taken to the hash cultivars across the world have led to landrace types being almost wiped out in some places. The stand out strains from the past all come from finding one stand out phenotype and then stabilising for sale. Imagine what wonders could be uncovered if people around the world hunted phenos, not just a few seed banks, who then sell genetics to the rest to rename.

There's been alot of work going on in back crossing to get the goodness back in as I say :) give it another year or two and your get all your old strains back with the bad ruderalis side taken out.

I dont know man, how can something that grows for 6 months in both night and day be the same as something that grows in 1 month in all day and no night?

Yeah i think ruduralis has muddied the genetic pool
Autos grow faster but bigger yield??
Have you ever noticed these tiny minute seed like things in weed these days...i wana say immature seeds but these are brown not green and they definitely taint the smoke
Autos grow faster but bigger yield??
Have you ever noticed these tiny minute seed like things in weed these days...i wana say immature seeds but these are brown not green and they definitely taint the smoke

5 posts
+9.2 votes
Yeast produced thc

Yeast produced thc


whats the recipe for this stuff? i hear it involves enzyme Prenyltransferases.
would love to try smoking some of it.
would love to try smoking some of it.

Dont know man I’ll stick to as natural as possible, i went through the synthetic cannabinoids and back to old faithful

11 posts
+21 votes
Pure sativa?
Stardawgs 90/10. You definitely get some indica come through though. Super silver haze is 80/20 and as Barbel Hunter said, the super strawberry haze is superb. UK 420 stocks a good selection of sativas that are worth looking at as well.

But im bias, i just really dont feel dawg. Think ive only ever had 1 heavilySativa leaning pheno

I know exactly what you mean mate. I never used to see what the hype was with star dawg for years. I’ve had a few Sativa dominant pheno’s now though and it’s definitely in my top 5.

Also very keen for a pure sativa. Closest at the moment might by UK 420s gipsy haze. I'm not long back from the Dam and sampled some Dr. Grinspoon. My favourite pure sativa ever. Will try and get some pics up of some of the same stuff that happened to arrive in the post just after I got back....what a coincidence!

I'm on a similar hunt right now, one of the best percentage splist I have seen is the White Haze (Dutch import) from seller UK 420 (about 80/20 sativa indicia I think) - I've just ordered some so not sure what it's like yet but I had some pineapple express off them previously and it was lovely!

Update, this stuff arrived and it's tasty as fuck! Nice solid head high, definitely one I'll be buying again. Recommend!

Hello mate
Its not a pure sativa , buy not far off based on genetics i should imagine but whatever the ratios its a dam good haze-Drugs inc Super Silver Strawberry Haze.
BH
Its not a pure sativa , buy not far off based on genetics i should imagine but whatever the ratios its a dam good haze-Drugs inc Super Silver Strawberry Haze.
BH

Sadly nothing pure Sativa or even 90% at the mo. Best is about 70/30 im afraid, but ive always got my eye out

64 posts by SmorganWeedman
1 post
+6 votes

on
{shade}
Is the Internet Making Freedom Impossible?
Its only a matter of time before we are all bar-coded, neatly organised and uploaded to the cloud and sooner the better i say.

on
{shade}
Is the Internet Making Freedom Impossible?
Nearly your entire life is controlled by the tech oligarchs. Everything we read, watch, buy, and eat is provided by them. And that's for those of us that don't also work for them.
They in turn are bullied by massively armed governments willing to steal or harm anyone that doesn't pay protection money.
We are surrounded by exploiters that also happen to own the network. And our best and brightest built it for them.
I'm really looking forward to ai doing the same thing to them.
They in turn are bullied by massively armed governments willing to steal or harm anyone that doesn't pay protection money.
We are surrounded by exploiters that also happen to own the network. And our best and brightest built it for them.
I'm really looking forward to ai doing the same thing to them.

But on the brightside we are connected globally. Humanity is making huge strides with science and medicine. Hope shines brightest in the dark guys!
(Plus we have LB, BTC and access to premium chronic)
(Plus we have LB, BTC and access to premium chronic)

How many of the poor does humanity include ? Doubt they care too much about the cutting edge science

Its only a matter of time before we are all bar-coded, neatly organised and uploaded to the cloud and sooner the better i say.

Ok but there's clouds and there's clouds. I don't mind a harp or 2 but then I got a pipe in some of the good shit from downstairs.

Huh? You wrote this on an anonymous board that uses bitcoin to pay for goods. iv never felt more free than today. Remote working enables me to work from anyway and do almost Anything that isn’t physical labour
All your communication is encrypted so no one can hijack the signal and read your messages. Same with audio and video,
Technology gives us freedom
All your communication is encrypted so no one can hijack the signal and read your messages. Same with audio and video,
Technology gives us freedom

Good piece kumo
If the sheep woke up all the parasite world leaders would be fucked , I’m hoping the internet in the end will help expose the darkness we live under & help the 2million + children who go missing every year to enslavement & blood harvesting .
If the sheep woke up all the parasite world leaders would be fucked , I’m hoping the internet in the end will help expose the darkness we live under & help the 2million + children who go missing every year to enslavement & blood harvesting .

I think it's impossible already , i think free internet was from the 80s towards 2000's post that it changed , we said nothing , we like the conveniences and now we cry all our info is everywhere , what's done is done and now we have to live with the consequences to be honest , unless a new Network internet type comes along that we can access with 0 censorship( we have TOR , but Onion Links not sustainable).
Right now even having a normal social media account is a hinderance , the world is so brainwashed that you cannot have your own opinion, 50 dumbasses will jump on your comments to convince you to think like them.
We need a time travel machine , i miss Yahoo messenger , MIRC , msn ,Yahoo news .
The only good thing is now we are all connected so now it's time for all of us to be informed to be able to filter out the bullshit.
Right now even having a normal social media account is a hinderance , the world is so brainwashed that you cannot have your own opinion, 50 dumbasses will jump on your comments to convince you to think like them.
We need a time travel machine , i miss Yahoo messenger , MIRC , msn ,Yahoo news .
The only good thing is now we are all connected so now it's time for all of us to be informed to be able to filter out the bullshit.

Depends how you define freedom.
We are by nature communal and social creatures.
We are constrained by the freedoms of others.
The illusion of hyper individualism and unrestrained libertarianism tells us that we can have unfettered personal freedom, economic freedom, even moral freedom.
But we can't and never could.
It's setting up a "prisoners dilemma" where the incentive is always to screw the other person over for your own freedoms. https://en.wikipedia.org/wiki/Prisoner%27s_dilemma
We are by nature communal and social creatures.
We are constrained by the freedoms of others.
The illusion of hyper individualism and unrestrained libertarianism tells us that we can have unfettered personal freedom, economic freedom, even moral freedom.
But we can't and never could.
It's setting up a "prisoners dilemma" where the incentive is always to screw the other person over for your own freedoms. https://en.wikipedia.org/wiki/Prisoner%27s_dilemma

The only true freedom would be when the soul leaves this disposable shield, after all no one is truly free from the duties of this world, where you can of course opt out whenever you like.
The AI would only make their(big tech,gov,etc) job easy to control this world only to be control by AI later down the line like the tech was suppose to do for others.
The AI would only make their(big tech,gov,etc) job easy to control this world only to be control by AI later down the line like the tech was suppose to do for others.

If he did. and I suspect he did and am awaiting confirmation of this, then I am happy for him to have his freedom removed.

Frankly, I consider myself a victim of Tate for having to know who he is and for having listened to him talk.

3 posts
+8 votes
Just started watching 'Spaced' again.
I'm 40 now so it is my generation, but it's really good!
(yup showing my age)
It's on all4. Along with Peep Show (which yeah i like too!)
Don't judge me!
Haha
Cheers BB
I'm 40 now so it is my generation, but it's really good!
(yup showing my age)
It's on all4. Along with Peep Show (which yeah i like too!)
Don't judge me!
Haha
Cheers BB

I'm in the middle of re-watching Spaced and felt like I had to scroll for hours to find somebody who finally mentioned it! xD

Thank you - you just reminded me I need to re-watch spaced again!
I was too old for it even back then, but the clever references still tickle me all these years later..
I was too old for it even back then, but the clever references still tickle me all these years later..

Well I’ll judge you... if I could give 2 upvotes I would, agree with you totally, 2 of my fave ever shows, making me think of hitting Spaced up again...

The Wire
The Ozark
Altered Carbon
Arrested Developement
People Just Do Nothing
Peep Show
Trailer Park Boys
Big Mouth
Fargo
Life On Mars
Dark Tourist
The Wolves Of Yellowstone
Utopia
It's Always Sunny In Philidelphia
Homeland
The Killing
Punisher
The End Of The Fucking World
This is what I can think of right now; definitely more to add. If anyone wants a little review/opinon or rundown on any of these shows let me know, more than happy. Also let me know what you're in the mood for, or usually like to watch and I can fire back with recommendations
The Ozark
Altered Carbon
Arrested Developement
People Just Do Nothing
Peep Show
Trailer Park Boys
Big Mouth
Fargo
Life On Mars
Dark Tourist
The Wolves Of Yellowstone
Utopia
It's Always Sunny In Philidelphia
Homeland
The Killing
Punisher
The End Of The Fucking World
This is what I can think of right now; definitely more to add. If anyone wants a little review/opinon or rundown on any of these shows let me know, more than happy. Also let me know what you're in the mood for, or usually like to watch and I can fire back with recommendations

Ah fuck it, nothing better to do, haha
The Wire - best thing ever written. Slow burner due to complication of story, but it is relatable as the war on drugs does not have a start or end to it, and street dealing doesn't just start, therefore you are immediately immersed in the story without even realising. Only figured that out the second time watching it. Also some great visual metaphors throughout. Also note there is no cue music to instigate feelings. All music is from source, i.e. car radio, night club. Only cue music is when Avon enters the lowrisers for the first time
The Ozark - Although breaking bad is good, it's not worth the hype. This is the older cooler brother of breaking bad. Calculated and intense at times. Story is always moving forward with real character progression
Altered Carbon - Absolutely fantastic sci-fi with great visuals and a great story line. Really left me itching to read the book, and I'm not a sci-fi fan
Arrested Development - Intelligent comedy with so much layered jokes you can watch this five times and still find punch lines you never noticed before
People Just Do Nothing - Threw this on not expecting much which is perhaps why I found it to be so good. Off the wall characters made completely believable by the actors playing the parts. Excellent idea, excellent execution.
Peep Show - This is a classic, you need to watch this
Trailer Park Boys - Another classic everyone here should be able to relate to
Big Mouth - Great for a background watch, but really funny and does take you back to your teenage years at times, haha
Fargo - Beautiful cinematography, great story captured very close to the original film. Billy Bob absolutely shines in this role in season one
Life On Mars - Made in early naughties, but just as relevant as today
Dark Tourist - good short run of a different kind of travel show. The kind of travel I like too
The Wolves Of Yellowstone - Nature documentary that has a story line Walt Disney would be proud of. Really makes you realise the balance of nature
Utopia - Such an underrated British TV series
It's Always Sunny In Philidelphia - Great zany show about dysfunctional friends who live in their own world, and drink in their own pub causing all kinds of ridiculous antics
Homeland - Great series that will always have you wondering what, or who is next
The Killing - Only recommend the first seasons. It drags you along on the witch hunt convincing you you know the answer
Punisher - About time they stuck to the gritty comic. Refreshing that this i not aimed at kids and fattening wallets.
The End Of The Fucking World - Two out there teens who decide to adventure together with, maybe, disastrous consequences
The Wire - best thing ever written. Slow burner due to complication of story, but it is relatable as the war on drugs does not have a start or end to it, and street dealing doesn't just start, therefore you are immediately immersed in the story without even realising. Only figured that out the second time watching it. Also some great visual metaphors throughout. Also note there is no cue music to instigate feelings. All music is from source, i.e. car radio, night club. Only cue music is when Avon enters the lowrisers for the first time
The Ozark - Although breaking bad is good, it's not worth the hype. This is the older cooler brother of breaking bad. Calculated and intense at times. Story is always moving forward with real character progression
Altered Carbon - Absolutely fantastic sci-fi with great visuals and a great story line. Really left me itching to read the book, and I'm not a sci-fi fan
Arrested Development - Intelligent comedy with so much layered jokes you can watch this five times and still find punch lines you never noticed before
People Just Do Nothing - Threw this on not expecting much which is perhaps why I found it to be so good. Off the wall characters made completely believable by the actors playing the parts. Excellent idea, excellent execution.
Peep Show - This is a classic, you need to watch this
Trailer Park Boys - Another classic everyone here should be able to relate to
Big Mouth - Great for a background watch, but really funny and does take you back to your teenage years at times, haha
Fargo - Beautiful cinematography, great story captured very close to the original film. Billy Bob absolutely shines in this role in season one
Life On Mars - Made in early naughties, but just as relevant as today
Dark Tourist - good short run of a different kind of travel show. The kind of travel I like too
The Wolves Of Yellowstone - Nature documentary that has a story line Walt Disney would be proud of. Really makes you realise the balance of nature
Utopia - Such an underrated British TV series
It's Always Sunny In Philidelphia - Great zany show about dysfunctional friends who live in their own world, and drink in their own pub causing all kinds of ridiculous antics
Homeland - Great series that will always have you wondering what, or who is next
The Killing - Only recommend the first seasons. It drags you along on the witch hunt convincing you you know the answer
Punisher - About time they stuck to the gritty comic. Refreshing that this i not aimed at kids and fattening wallets.
The End Of The Fucking World - Two out there teens who decide to adventure together with, maybe, disastrous consequences

Peep show one of my all time favs and can't to wrong with arrested development what a classic

Sad that they never manager to run the show normally... And probably we won't se another season ever :( love arrested development

Currently halfway through the first series of Altered Carbon after reading this thread and seeing your recommendation. I'm a PhilipKDick fan and I'm really enjoying it, cheers 👍

Oh my god its been years since I've watched utopia and now I'm all excited to dive into the twisted wacky world of 90's conspiracies that now seem quick mundane as they are basically happening now

Dark on Netflix. German show about time travel set in a village where kids keep going missing every 33 years. Stunning production values, really intricately plotted, three series, all ties together. Loved it. Has an English dub but the German audio with subtitles is best.

100% but do you think you could watch them the other way round and it’s all still as good? As I really do, integrated them amazingly well.

Yeah I agree, I liked BB a lot but I came to it a bit late and like UKgrower hearing the hype maybe expected too much. Better call Saul I didn’t expect much of at all, didn’t think it’d get past Series 1 but now I think it’s better than BB.

If you enjoyed Breaking Bad, then give Better Call Saul a go. I always thought he stole every scene he was in during Breaking Bad.

End of the fucking world is really good. Strange and offbeat which I like. With some characters that don’t give a fuck. And it’s British and very relatable (even though it’s about a lad that thinks he’s a psychopath haha).

Literally just finished watching brassic 2 and Save me Too. Both class. Surely everyone on here has watched Brassic.....!!!?

I do, doesn't quite hit the levels that Shameless did back in the day but still a lot of fun. Plus it's good to hear actual accents on TV instead of just American lol

I'm watching Detectorists at the moment. Really good. Funny and with beautiful scenery. On BBC iPlayer and Netflix.

Shout for detectorists.
Great theme tune btw.
Excellent characters.
Great series about the sackler family’s and there murderous medical misbehaviour ( painkiller )
Starring ferris bueller.
Great theme tune btw.
Excellent characters.
Great series about the sackler family’s and there murderous medical misbehaviour ( painkiller )
Starring ferris bueller.

Some of the things I've enjoyed are:
The Boys
Vikings
100
Only fools and horses
Into the Badlands
Breaking Bad
Picard
Game of Thrones ( Except the last season which I found terrible )
Star Trek The next Generation - Deep Space Nine
Stargate Atlantis
Treadstone
The Boys
Vikings
100
Only fools and horses
Into the Badlands
Breaking Bad
Picard
Game of Thrones ( Except the last season which I found terrible )
Star Trek The next Generation - Deep Space Nine
Stargate Atlantis
Treadstone

*The Queen's Gambit- short series (one season only) but good storyline
*Lie To Me
*The Mentalist
*Sherlock
*Lie To Me
*The Mentalist
*Sherlock

Orphan black! one of my favourites.. the wire.. Russian doll..cynical,funny. end of the fucking world. Money heist.. prison break..cleverly written. Better call Saul if you enjoyed breaking bad.
Rick and Morty and weed is my favourite combination. Snoop dog’s talk show on YouTube is hilarious to watch as-well.
I find American horror story hilarious, but only when I’m high, otherwise it’s pretty terrifying lol.
Films : seven psychopaths is a must watch, requiem for a dream and pulp fiction, all time faves. and I did write a detailed review and much more but it was deleted :/
Rick and Morty and weed is my favourite combination. Snoop dog’s talk show on YouTube is hilarious to watch as-well.
I find American horror story hilarious, but only when I’m high, otherwise it’s pretty terrifying lol.
Films : seven psychopaths is a must watch, requiem for a dream and pulp fiction, all time faves. and I did write a detailed review and much more but it was deleted :/


If you want a Change and a Tons of one line bombs to drop at work or with your mates there is only one place to go
"Letter Kenny" it will almost make you want to live there
10ply/Sally/Hard No and Bonny McMurryyyyyyyyyyyyyy
And if you want some of the best swearing on telly "The Thick of IT" / In The Loop
You will never watch a MP without Laughing again The Thick of it is almost a Documatary
Malcom Tucker is a
Best name calling every "Fuckbob Shitpants"
Sorry about the spelling
I am just dislexick @is there a strain that will help with this???
"Letter Kenny" it will almost make you want to live there
10ply/Sally/Hard No and Bonny McMurryyyyyyyyyyyyyy
And if you want some of the best swearing on telly "The Thick of IT" / In The Loop
You will never watch a MP without Laughing again The Thick of it is almost a Documatary
Malcom Tucker is a
Best name calling every "Fuckbob Shitpants"
Sorry about the spelling
I am just dislexick @is there a strain that will help with this???

yes, they will all help make it worse. on the bright side, since everybody started typing on their phones, dyslexia is hardly noticeable anymore and you really don't have to apologise.

Gomorrah if you dont mind subtitles, its an Italian crime show set in Naples. Simply brilliant.
Murphys law
Stargate universe, SG1, Atlantis
Firefly
The Expanse
Oz
Banshee
Person of interest
The shield
Hetty Wainthropp investigates
Murphys law
Stargate universe, SG1, Atlantis
Firefly
The Expanse
Oz
Banshee
Person of interest
The shield
Hetty Wainthropp investigates

Gomorrah is the shit man, one of my all time favs
Oz is a downer but an awesome show
Ozark
Better call Saul
The wire
Boardwalk empire
Sopranos
Just watched Gangs of London which was banging
Chernobyl was a masterpiece
Oz is a downer but an awesome show
Ozark
Better call Saul
The wire
Boardwalk empire
Sopranos
Just watched Gangs of London which was banging
Chernobyl was a masterpiece

Yean Gomorrah is probably my number 1 show, the setting, actors, story... superb. Cant wait to watch the Ciro Di Marzio movie too.

L'Immortale or the Immortal is the name, was out last year in Italy. Have tried to find out when its out in the UK but no joy yet

Its on sky atlantic now mate, its certainly worth a watch an sets up the next season of Gomorrah nicely

If you like weird? Get baked & watch.
Channel 4
Garth marenghi's dark place ;-)
Robot chicken
Shivering truth
Father ted
The IT crowd
One foot in the grave
What we do in the shadows. Watch the film first.
Sandman - netflix
Red dwarf
Fast show
Inside no 9
The young offenders
The boys
15 stories high - sean lock's first tv series. on youtube but low quality.
Band of brothers
Chernobyl
Firefly
Curb your enthusiasm
Fawlty towers
Black adder
Black mirror
Dexter
Channel 4
Garth marenghi's dark place ;-)
Robot chicken
Shivering truth
Father ted
The IT crowd
One foot in the grave
What we do in the shadows. Watch the film first.
Sandman - netflix
Red dwarf
Fast show
Inside no 9
The young offenders
The boys
15 stories high - sean lock's first tv series. on youtube but low quality.
Band of brothers
Chernobyl
Firefly
Curb your enthusiasm
Fawlty towers
Black adder
Black mirror
Dexter

Respect for Garth Merenghi, everybody should see that.
On that note, throw Mighty Boosh into the mix as well.
Big Train to round off a trio of lesser-known, top quality British comedies.
On that note, throw Mighty Boosh into the mix as well.
Big Train to round off a trio of lesser-known, top quality British comedies.

Have you ever watched Travellers? (if you was a fan of stargate back in the day this will interest you) or if your a sci fi fan, Very good story telling and actors (Canadian)

i liked that a lot more than i thought i would. also, colony on netflix even though it was killed by covid and never finished.

Ifyou seen BB, definitely watch Better Call Saul.
Comedy? The Office US and then Parks n Recreation. Or maybe Shameless US? Little Britain it's always great company.
If you seen Broadwalk E, you probably have seen the sopranos. If not its a MUST! Ive been watching House of Cards and it's quite nice too.
Maybe 6 feet under, Weeds, Dexter, Chuck, My name it's Earl??
Cience? COSMOS!!! A mind blowing and mind opening cience series. Everyone should watch it before they die. Either the original and first with Carl Sagan (it might not have the best visual representations but Carl its Carl) or the new Neil Tyson.
In to some stand ups? George Carlin is a must, the young Carlin to the old political Carlin.
I would also like to give a shout out to my Spanish Fellows on THE Money Heist.
Comedy? The Office US and then Parks n Recreation. Or maybe Shameless US? Little Britain it's always great company.
If you seen Broadwalk E, you probably have seen the sopranos. If not its a MUST! Ive been watching House of Cards and it's quite nice too.
Maybe 6 feet under, Weeds, Dexter, Chuck, My name it's Earl??
Cience? COSMOS!!! A mind blowing and mind opening cience series. Everyone should watch it before they die. Either the original and first with Carl Sagan (it might not have the best visual representations but Carl its Carl) or the new Neil Tyson.
In to some stand ups? George Carlin is a must, the young Carlin to the old political Carlin.
I would also like to give a shout out to my Spanish Fellows on THE Money Heist.

Yo UK Grower. I have just discovered Channel Zero on StarZplay, prime add on. It’s a really good horror series, twisted stuff, defo a bit freaky.

To any one who likes comedies don't be put off What We Do in the Shadows, it's vampires but it's not really a "vampire" type show.... it's really funny when high and the second series has just come out on iplayer.

If you're into Sci-fi I'd highly recommend Altered Carbon on Netflix. Really cool story and visuals. I seen somebody recommended Ozark, excellent as well. If you like animation and feel like a laugh give Rick and Morty a watch, The Midnight Gospel is also new to Netflix but really trippy / funny in my opinion. Happy watching!



I almost pissed myself with laughter watching the first episode as I watched the trailer but wasn't really for how out there this really is. A must watch for any sci fi and gaming fan or if you have a sick sense of humour like me :)

Stranger Things Season 1 - 80's themed sci-fi thriller with endearing characters that had me on the edge of my seat throughout.
True Detective Season 1 - Basically an 8 hour movie that oozes quality. Pacing/cinematography/acting/dialogue are all A++ for me.
Trailer Park Boys - Get baked, watch this, laugh your arse off.
Peep Show - Clever and hilarious.
True Detective Season 1 - Basically an 8 hour movie that oozes quality. Pacing/cinematography/acting/dialogue are all A++ for me.
Trailer Park Boys - Get baked, watch this, laugh your arse off.
Peep Show - Clever and hilarious.

Band of Brothers is a masterpiece, great shout! Any recommendations of war films/series that are similar mate?

Give 'The Pacific' a go. Its HBOs follow up to 'Band Of Brothers' set during the allied assault on the Pacific region during WW2

Trailer Park Boys should be perfect for everyone on here, given the enormous amount of smoking and growing throughout!

Dunno if these have been broached, but try some Aussie drama
Pine Gap
Underbelly
The Magician / Mr Inbetween
All great watches but Mr Inbetween tells the story of your everyday underworld enforcer. Ive watched it in full 3 times and regularly watch YouTube clips. Never has the word run hit so hard
Pine Gap
Underbelly
The Magician / Mr Inbetween
All great watches but Mr Inbetween tells the story of your everyday underworld enforcer. Ive watched it in full 3 times and regularly watch YouTube clips. Never has the word run hit so hard


Since it hasn’t been mentioned here , it only proves how massively underrated Wilfred is . Had great laughs :) U.S. version of an Australian cult sitcom about a meek young man and a pot-smoking talking dog named Wilfred (actually actor Jason Gann in a dog suit, whom everyone else sees as just a dog). Won’t spoilt it anymore

Watching Yellowjackets at the moment, pretty good but if you watch the pilot episode don’t be put off as that’s a bit shit, it does get better!
Watched “From” before that, that was pretty good too…
Watched “From” before that, that was pretty good too…

The Start Up, it's on Netflix. 2 series' that I've thoroughly enjoyed. Defo worth a watch!

Gotta be Trailer Park Boys
(still on Netflix atm)
The American office is a good
watch too with many eps
(still on Netflix atm)
The American office is a good
watch too with many eps

The Christmas special of Mortimer and Whitehouse Gone Fishing done in THE most beautiful part of the country North Yorkshire! Great watch when baked as fuck haha :)
The Grand Tour is back as well for anyone in to that, done to death obviously but atleast it's something new to watch lol
The Grand Tour is back as well for anyone in to that, done to death obviously but atleast it's something new to watch lol

Devs.
New Alex Garland (Ex Machina) series on FX & Hulu in the states, not sure where in the UK. Totally brilliant, and the best cinematography I've seen on TV. Ran here in spring 2020 and I'm still thinking about it.
New Alex Garland (Ex Machina) series on FX & Hulu in the states, not sure where in the UK. Totally brilliant, and the best cinematography I've seen on TV. Ran here in spring 2020 and I'm still thinking about it.

just call Saul was better than breaking bad in some ways (last series a bit disappointing tho). Always interested to see if people liked the Midnight Gospel (single series, animation, also Netflix).

If you liked Breaking Bad you might like Better Call Saul... it's slower but the writing and cinematography are actually better imo. Plus by S5 the pace is basically on BB levels.

The Boys or Doom patrol, quality shows right there & the wire If you didnt see it yet,too many to name mate but try them

Undone is good and trippy with the animation style it uses and pretty unique story to boot.
You (season 1). Solid watch but latest series was a waste of time.
You (season 1). Solid watch but latest series was a waste of time.

Fringe is my favorite series of all time!
12 monkeys
Weeds
Already mentioned but some of my favorites -
Westworld, The Magicians, altered carbon & Vikings
With everyones suggestions should keep you going for a couple of lockdowns
12 monkeys
Weeds
Already mentioned but some of my favorites -
Westworld, The Magicians, altered carbon & Vikings
With everyones suggestions should keep you going for a couple of lockdowns

Get the amazon Prime free trial and watch Picard, star trek spin off - it's really good, not what you expect.

also i love disco/history/natgeo... skin walker ranch program on at the mo is interesting. history but avail on catchup bro

Devs
Norsemen
Treadstone
The Expanse
Mindhunter
Watchmen
Badlands (or enter the badlands)
Norsemen
Treadstone
The Expanse
Mindhunter
Watchmen
Badlands (or enter the badlands)

Surprised no one’s mentioned Snowfall.
One of the best series imo.
And it’s free to watch on bbc iplayer
One of the best series imo.
And it’s free to watch on bbc iplayer

The Sopranos, the Wire, The Americans (best ending), boss season 1, the Divide 2014 (hard to find but worth it), true detective 4, xfiles season 4.

I just rewatched 'The Lost Room'
It's a miniseries with 3 90min episodes and it only ever had one proper airing so nobody I've ever mentioned it to has seen it.
Definitely worth a watch though💜💚👊🏻
It's a miniseries with 3 90min episodes and it only ever had one proper airing so nobody I've ever mentioned it to has seen it.
Definitely worth a watch though💜💚👊🏻

Trying to go for some semi-obscure ones here....
Burn notice
We own this city (from the same guy who did the wire)
Tokyo vice
Spartacus blood and sand (all 4 seasons)
Final space
Primal
Goblin slayer (not an anime fan but love this)
15 Storeys high
Burn notice
We own this city (from the same guy who did the wire)
Tokyo vice
Spartacus blood and sand (all 4 seasons)
Final space
Primal
Goblin slayer (not an anime fan but love this)
15 Storeys high

If no one has said it yet, Banshee. A pro thief / seriously tough guy played by Anthony Starr ( Homelander from the boys) rolls into town, assumes the identity of a recently deceased new Sheriff that no one has met yet. Boom, he's now the law in town and is actually very good at stopping crime. Insane realistic violence, Amish gangsters, bikers, native American mafia and lots more, best show I've ever seen

Hi Biggas TEAM
New to here and to the community. Good to meet you all!
Shows to have a watch by me ->
- Suburra
- ZeroZeroZero
- Cocaine Coast
- Narcos
- El Chapo
- Gomorrah
- Ozark
- Top Boy
- McMafia
- Undercover
- Kin ( Really enjoyed that one )
- Quicksand
- Snabba Cash
- Mayor of Kingstown
- Ripley
- Unauthorized Living
- Ganglands
- The Gentlemen
- Mindhunter
- The Fall
- Bodies
- The Sinner
- Criminal: UK
- Hache
Who ever will be watching... just enjoy it.
New to here and to the community. Good to meet you all!
Shows to have a watch by me ->
- Suburra
- ZeroZeroZero
- Cocaine Coast
- Narcos
- El Chapo
- Gomorrah
- Ozark
- Top Boy
- McMafia
- Undercover
- Kin ( Really enjoyed that one )
- Quicksand
- Snabba Cash
- Mayor of Kingstown
- Ripley
- Unauthorized Living
- Ganglands
- The Gentlemen
- Mindhunter
- The Fall
- Bodies
- The Sinner
- Criminal: UK
- Hache
Who ever will be watching... just enjoy it.

On the The Block - Netflix - nice teen vibe and story
Archive 81 - Netflix stranger things vibe , synthwave , 80s , VHs Vibe - captivating story , mysterious
Archive 81 - Netflix stranger things vibe , synthwave , 80s , VHs Vibe - captivating story , mysterious

Loads of top shows already mentioned on this list so trying not to repeat(can't stand repeats). Didn't notice a mention for The Newsroom, absolutely brilliant with super slick dialogue, maybe stick to sativa for that one.
Also the classic stoner sit coms Top Buzzer starring a young Steven Graham and Ideal with Jonny Vegas, they will do for the indica night.
Once the hash and concentrates come out just put Taskmaster on it is the best thing c4 have done for a long time and requires zero brain power to enjoy perfect couch lock fodder
Also the classic stoner sit coms Top Buzzer starring a young Steven Graham and Ideal with Jonny Vegas, they will do for the indica night.
Once the hash and concentrates come out just put Taskmaster on it is the best thing c4 have done for a long time and requires zero brain power to enjoy perfect couch lock fodder

Fargo is probably the best series ever after GOT. Better Call Saul was brilliant too after a slow start. Better than Breaking Bad for me.

All the seasons are good and different stories so don't need to watch in order. All true apparently. The movie's a bit dated now but a great watch too.

Brand New Cherry Flavour if you think you'd find the subject of psychedelic sorcery played out as a fictional horror story interesting

Murder Mountain on Netflix. An oldie but a goodie. All about the emerald triangle in California and how it moved from illegal weed growing into legalisation and the lawless nature of the industry.



Often overlooked, but Mike Judge of Beavis and Butthead fame created this absolute gem....highly reccomend...as smart as it is funny...

15/7.
You could try black mirror.
A selection of engrossing stories some weird and some mind blowing.. spanning 6 seasons between 4 n 6 eps each.
Can’t remember all but loch Henry and demon 79 were fck brilliant from the last season. 🌬️🍀
You could try black mirror.
A selection of engrossing stories some weird and some mind blowing.. spanning 6 seasons between 4 n 6 eps each.
Can’t remember all but loch Henry and demon 79 were fck brilliant from the last season. 🌬️🍀

Ozark
Slow Horses
I-land
Blacklist
Upload
Code 404
Line of Duty
Bosch Legacy
Hanna
Prison Break
Suits
The Capture
Brassic
Hightown
White Lines
Better Call Saul
Power
Weeds
Slow Horses
I-land
Blacklist
Upload
Code 404
Line of Duty
Bosch Legacy
Hanna
Prison Break
Suits
The Capture
Brassic
Hightown
White Lines
Better Call Saul
Power
Weeds

Person of Interest
Jim cavisal and Micheal Emerson proper dark series about artificial intelligence a must watch
Jim cavisal and Micheal Emerson proper dark series about artificial intelligence a must watch

I'm surprised no one suggested Family Business (on Netflix). A great comedy series about a family in Paris who runs a Kosher butchers and end up producing vast amounts of Pastraweed!
Really funny, great actors and all around fun to watch.
A French Breaking Bad without all the stress in a way!
Really funny, great actors and all around fun to watch.
A French Breaking Bad without all the stress in a way!

I never thought I'd see someone mention The Platform. Great film if you've got your stone on! Alice in Borderland is brilliant also it's like a mash-up of The Prisoner and Battle Royale.

I know this is a bit of old news but have you seen Schitts Creek? I just discovered it and it is so funny

The Man in the High Castle is loads of fun, especially if you’re a fan of PKD. Classic UK series that are great: Line of Duty, The Fall, Peep Show, Monty Python’s Flying Circus

New British comedy horror on prime with Simon Pegg and nick frost, only a short one but was enjoyable, there’s this once scene when nick frost thinks he is about to get shanked and it’s hilarious.
It’s called Truth Seekers
It’s called Truth Seekers

Succession is better than you'd think. Punisher is the best out of all the Marvel shows, Daredevil is also very watchable (and Jessica Jones if you're into angry women with PTSD). Umbrella Academy is fun to watch. The Magicians ditto. Also The Boys.

One of my all-time favourites will always be Daria.
I just love that sassy, sarcastic, little oddball in her socially satire highschool world. Sometimes it hits close to home.
Hoops on Netflix is also worth one or two laughs.
Tuca & Berti is also the right amount of strange.
Our Planet is a great background noise, a lot of beautiful scenery overviews.
Not in Netflix, but how about the Kurzgesagt YouTube channel. It's funny, educational, soothing commentary,cute Art style a great variety of topics etc.
I just love that sassy, sarcastic, little oddball in her socially satire highschool world. Sometimes it hits close to home.
Hoops on Netflix is also worth one or two laughs.
Tuca & Berti is also the right amount of strange.
Our Planet is a great background noise, a lot of beautiful scenery overviews.
Not in Netflix, but how about the Kurzgesagt YouTube channel. It's funny, educational, soothing commentary,cute Art style a great variety of topics etc.

Firefly
Battlestar Galactica ( the remake )
Parks and Rec ( but you have to tough out the first two seasons)
West world
Stranger Things
OA
Battlestar Galactica ( the remake )
Parks and Rec ( but you have to tough out the first two seasons)
West world
Stranger Things
OA

Ahh man the OA was fucking amazing, completely different to what I thought it'd be. Can't believe they aren't renewing it!

Hey man some good series I watched recently was:
The Originals
Vikings
Battle star galactica (the remake series)
The man in the high castle
The Magicians
Got a load more but too stoned to list!!!
Hope that helps a little 8)
The Originals
Vikings
Battle star galactica (the remake series)
The man in the high castle
The Magicians
Got a load more but too stoned to list!!!
Hope that helps a little 8)

Blake's 7
On the buses
3rd rock from the sun
It ain't half hot mum
Curry and chips
And my favourite Till death us do part
Them last 3 May not be very PC but still good stuff.
On the buses
3rd rock from the sun
It ain't half hot mum
Curry and chips
And my favourite Till death us do part
Them last 3 May not be very PC but still good stuff.

Black Monday , so off key guaranteed hard core laughing
Legit , so not pc. Jim Jeffries stars
Black Jesus , stonehead Jesus extremely funny
Legit , so not pc. Jim Jeffries stars
Black Jesus , stonehead Jesus extremely funny

Bobs burgers is a laugh when baked
El chapo if you can be bothered reading subs
SWAT
Gangs of London
Sons of anarchy
Mr Pickles - YouTube it
El chapo if you can be bothered reading subs
SWAT
Gangs of London
Sons of anarchy
Mr Pickles - YouTube it

Lots of good suggestions & Sopranos is also great. If you have Netflix then Orange Is The New Black is available & also Weeds from the same writer; both a bit different... ;-)

Braindead (2016)
A government employee learns that the cause for the disputes between two political parties is the insects which are eating their brains.
get ready to laugh
A government employee learns that the cause for the disputes between two political parties is the insects which are eating their brains.
get ready to laugh

Dubbed films used to drive me crackers but given that or the bbc I choose ‘ European crime series’s’
Seem to have them in every country and to be fair they are done well.
Seem to have them in every country and to be fair they are done well.

Truly terrible. Shows how much Pitt & Jolie were needed to make that story work. These two are deathly dull!

Dirk gentleys hollistic detective agency.
Brand new cherry flavor.
Lillehammer.
All on Netflix 👌🏻
Brand new cherry flavor.
Lillehammer.
All on Netflix 👌🏻

1 post
+15.2 votes
what comes after the web?
We bio engineer ourselves into organic super computers, harness the planets electromagnetic field as a server and live as gods in virtual reality.
Decentralisation, rebirth of the concept of governments and banks (stores of value and loans of value), the internet of money, the exchange of favours peer to peer, the recognition of favours, global decentralised online democracy, micro businesses go parabolic, communities become self sufficient, govts lose control. Its happening.

True though. example..I cashed out £3k yesterday just for posting on a crypto sub on reddit for a few years, 3-4 posts a week.. erc20 rewards. I use brave browser which offers free anti tracking, https upgrades, ad free browsing (inc youtube) and it pays as you go with BAT token. It covers my premium netflix monthly subscription and costs nothing.

Elon ain’t what he’s appearing to be.
Anyone involved with those robots needs hanging from a tree.
Anyone involved with those robots needs hanging from a tree.

I've read about this before bud but never decided to do it as I felt it would be too little. Can you explain more about it, i'd love to know with regards of how active you actually were. its a very clever idea. did you pay for brave or was it free? I'll go check it out thanks for sharing :D

We bio engineer ourselves into organic super computers, harness the planets electromagnetic field as a server and live as gods in virtual reality.

but it won't be 'us' providing this world, it'll be engineered and controlled by a select few people who will have total control over everyone

ai has been in control since the 19th century, we are working for the machines, not vice versa

the corporate curated a.i. justified brave new world feed that makes you yearn for the good old days of google

Web 5. Decentralisation of personal data. Anonymity. Buyers Markets. People realise phones arent phones and just tracking chips that post spam in your face all day so we go back to mp3 players that make calls. We reverse the inversion and regain the ability to tell human from computer and truth from fiction again.
Humanity cannot progress or achieve the things we used to while big data has us pinned down with the technology and the mind games, constantly draining every penny we have. We're so busy trying to create money with our bare hands to pay off the debt they are creating that we can't get anywhere and never will.
People are working to take apart that system as we contemplate.
For now at least we have LB.
Humanity cannot progress or achieve the things we used to while big data has us pinned down with the technology and the mind games, constantly draining every penny we have. We're so busy trying to create money with our bare hands to pay off the debt they are creating that we can't get anywhere and never will.
People are working to take apart that system as we contemplate.
For now at least we have LB.

It seems more than ever the Old guard sees the next wave coming and is way more on top of it than previous leaders. this alone makes it interesting

a dildo in the face one in the butt and a fleshlight on the cock, they will convince you you are a real person and you work for onlyfans, but there will be millions of you all stacked up as far as the eye can see.

Cybernetic implants that turn you into a computer then we will go too far and try and turn the planet into a super computer and blow ourselves up again and it will be back to painting on cave walls.

Neural net will likely be next. You will see the net when you want in your own eyes. Real time everything. No screens, no devices except inside you.

When the web is fully developed, all endpoints interconnected and in harmony, I usually walk right into it and get it stuck in my hair.

Reticulum is looking really promising on the privacy decentralized web front, a whole cryptography based network stack:
https://reticulum.network/
Early days, but a lot of bits going on there:
Reticulum > network stack (similar TCP or UDP)
LXMF > message protocol (similar POP or SMTP)
RNode > a long range data radio (similar wifi access point) that you can build easily with $20 hardware and start building a mesh network
Sideband/MeshChat/NomadNetwork > full featured messaging clients
Crap name tho! :) Needs more marketing
https://reticulum.network/
Early days, but a lot of bits going on there:
Reticulum > network stack (similar TCP or UDP)
LXMF > message protocol (similar POP or SMTP)
RNode > a long range data radio (similar wifi access point) that you can build easily with $20 hardware and start building a mesh network
Sideband/MeshChat/NomadNetwork > full featured messaging clients
Crap name tho! :) Needs more marketing

1 post
+3 votes

on
iron jizz
What is the best Science Fiction Anime Series?
Genndy Tartakovsky's Primal
Cowboy Bebop is amazing, beautifully written, drawn, and directed. Don't be turned off by the 1st episode which isn't very sci fi and more like film noir cliche stuff. The future world unfolds over the episodes along with the back story of how it evolved though another great thing is each episode stands independently.

There is supposed to be a live action movie coming out at some point in the future. I thought there would be a third season but l guess l am wrong.

Steins gate is class. Time travel sci fi. Bit of a slow burner but get past the first two episodes it’s quality on Netflix as well.

Steins;Gate is brilliant. Some unique characterisations and a great, but inevitably confusing, take on the time travel concept with a ton of real world references and conspiracies. Solid choice. However, I highly recommend this viewing order: Steins;Gate episodes 01-22 then episode 23β (alternate version of 23), Steins;Gate 0 episodes 01-23 (you can watch somewhere online or on Crunchyroll) then original Steins;Gate series episodes 23-24. Sounds confusing lol but honestly this is the best way to experience the story.

Finished kaiba the other night from this recommendation. Thought it was class, trippy as fuck.

I love the premise here with the mind-body interchange but its really hard for me to get past the drawing. It seems more like something out of Spain in the 1930s than Anime.

Don’t know if this is a mad suggestion or if literally everybody has seen it. But the Animatrix ?
9 (I think) half an hour animated films set within The Matrix universe. All are interesting and well animated, but a few are stellar.
There’s one created by Shinichiro Watanabe, of cowboy beebop and samurai champloo (my personal favourite).
If you haven’t seen it, buy the dvd and watch it; if you have seen it, back me up!
Peace
9 (I think) half an hour animated films set within The Matrix universe. All are interesting and well animated, but a few are stellar.
There’s one created by Shinichiro Watanabe, of cowboy beebop and samurai champloo (my personal favourite).
If you haven’t seen it, buy the dvd and watch it; if you have seen it, back me up!
Peace

back that matrix up, it's awesome.
the back and forth between ghost in the shell and the matrix gets its best iteration right here.
the back and forth between ghost in the shell and the matrix gets its best iteration right here.

dig this thanks
Terraformars (テラフォーマー, Terafōmā) are evolved humanoid cockroaches who live on Mars. They possess physical traits and skills that greatly surpass those of normal humans. They also appear to be somewhat intelligent and have a natural hatred for humans; much like how humans hate cockroaches.
Terraformars (テラフォーマー, Terafōmā) are evolved humanoid cockroaches who live on Mars. They possess physical traits and skills that greatly surpass those of normal humans. They also appear to be somewhat intelligent and have a natural hatred for humans; much like how humans hate cockroaches.

not sure it qualifies as science fiction - but! try to watch it when high when high.
DOROHEDORO
i'd love to hear from you when you do.
DOROHEDORO
i'd love to hear from you when you do.

Dorohedoro is fucking class. Watched the first season twice (high) then read the entire manga.

serial experiment lain!!!, a bit old but still ahead of most anime... and I mean, Evangelion, if you have not seen it!

Was about to say this, superb Anime!!
Also, an oldie but a classic is "The guyver" bio booster armour!!!
Also, an oldie but a classic is "The guyver" bio booster armour!!!

THIS!!!!!!
Absolutely epic, then when you finished hit up mutronics and guyver: dark hero with mark Hamill 👌😂
Absolutely epic, then when you finished hit up mutronics and guyver: dark hero with mark Hamill 👌😂

Deathnote was good, so was One Punch Man. Terror in Residence was really good too. And I quite liked Knights of Sidonia. Or just watch Akira and Ghost in the Shell and be done with it :)

Thanks for the tip. It should be cool just based on the fact that he did Samurai Jack. And Ive found out a movie version was made and even submitted to oscars (fck oscars tho!).. Nice!!

Sci fi anime faves:
Noein (short series based on quantum physics theory),
Gintama (comedy anime partly set in space),
Ergo proxy (short dystopian series in futuristic world),
Inuyashiki (Old man becomes a weaponized cyborg and you follow his story),
Parasyte (High school kid gets infected by an alien parasyte),
And last but not least!
Psycho pass, it has 3 seasons and about 5 movies on the same world. A world which is monitored by an expert crime a.i. program, people get a hue which shows how likely to commit crime you will be, it's hard to explain but definitely my favourite sci fi series for a while.
Noein (short series based on quantum physics theory),
Gintama (comedy anime partly set in space),
Ergo proxy (short dystopian series in futuristic world),
Inuyashiki (Old man becomes a weaponized cyborg and you follow his story),
Parasyte (High school kid gets infected by an alien parasyte),
And last but not least!
Psycho pass, it has 3 seasons and about 5 movies on the same world. A world which is monitored by an expert crime a.i. program, people get a hue which shows how likely to commit crime you will be, it's hard to explain but definitely my favourite sci fi series for a while.

Edens Zero is a new series if you want somthing light hearted and not too heavy ... if you want heavy watch Gantz, Straight jacket, Karas ect.... Brynhildr in the Darkness is not bad ether has a sci-fi take on witches being aliens..

Trigun was one of my favourite highly recommended it. The 7 deadly sins is pretty cool.

Terra formars is one of my all time favorites, parasyte is great but more body horror than sci fi

Think someone has mentioned all of these, but still
gurren lagann, Evangelion, Cowboy bebop, Space Dandy, Legend of the galactic heroes are some of the heavy hitters that everyone should see
Planetes is lesser known and quite low stakes but really good show about a crew who live on a satellite and have to collect trash from earth's orbit
Kaiba is great if you can stomach the art-style and are high enough to understand what's going on
gurren lagann, Evangelion, Cowboy bebop, Space Dandy, Legend of the galactic heroes are some of the heavy hitters that everyone should see
Planetes is lesser known and quite low stakes but really good show about a crew who live on a satellite and have to collect trash from earth's orbit
Kaiba is great if you can stomach the art-style and are high enough to understand what's going on

Steins Gate has to be number 1 it’s one of the best anime's even outside of just the sci fi category, I highly recommend it, it has really interesting plot-lines about time-travel. Parasyte is also another great watch along with cowboy bebop a classic futuristic western like show.

Cowboy Bebop. No qualifying statement required. It's a timeless classic. I wish I could see it for the first time again

Space dandy. Some really good episodes to watch stoned especially the first few.
Love death robots good shout.
Saiki k. Didn't watch stoned but really enjoyed it, might give it another look myself.
Non SciFi recommendation would be Kakegurui, if you haven't watched it watch it stoned it's really good. It's about gambling and girls that leak a lot of fluid.
Also 'close enough' is quite good to watch stoned from the makers of the regular show but for adults.
All should be on Netflix.
Love death robots good shout.
Saiki k. Didn't watch stoned but really enjoyed it, might give it another look myself.
Non SciFi recommendation would be Kakegurui, if you haven't watched it watch it stoned it's really good. It's about gambling and girls that leak a lot of fluid.
Also 'close enough' is quite good to watch stoned from the makers of the regular show but for adults.
All should be on Netflix.

Castlevania on Netflix is awesome! Not really sci-fi but the art style is great and a nice spin on an old tale. I binge watched 3 seasons in like 3days lol

I am going to give a quirky suggestion and say Boogiepop Phantom. Otherwise, Cowboy Bebop.
(But once you are done with Cowboy Bebop, watch Samurai Champloo. It is Cowboy Bebop set in feudal Japan).
(But once you are done with Cowboy Bebop, watch Samurai Champloo. It is Cowboy Bebop set in feudal Japan).

1 post
+2 votes
Does Cannabis work with humans for its own gain?
Animals eat plants and shit the seeds out so yeah i guess.

Does Cannabis work with humans for its own gain?
Sounds weird I know, but do you think that cannabis attracts us to further itself? I mean it's a stationary plant that has very little means of spreading and evolving in the wild. But since we have discovered its usefulness for ourselves we have helped it evolve into what it is today. And In return it makes itself stronger and more controllable for our will. It is well known that plants attract bees and not the other way around so what's to say they aren't doing the same to us?

Love this thought and it reconciles, we are serving cannabis' genetic purpose:
fecundity - more greenhouses every day
fidelity - our buyer reviews maintain integrity
longevity - humans have basically coupled their own survival to cannabis, as long as we are around it's going to be with us.
fecundity - more greenhouses every day
fidelity - our buyer reviews maintain integrity
longevity - humans have basically coupled their own survival to cannabis, as long as we are around it's going to be with us.

I agree, and it applies to almost everything we grow/farm and consume (the exceptions being those we've hunted things to extinction). You can absolutely see it as them exploiting us for their own ends.
I like to see apples and other fruit exploiting animals and birds, who not only distribute their seeds further than the air could carry them, but plant them nicely in a lump of rich fertiliser for them.
By the way, it's e^{i*pi} that's equal to -1 (the exponent is pi times i, not pi divided by i)
I like to see apples and other fruit exploiting animals and birds, who not only distribute their seeds further than the air could carry them, but plant them nicely in a lump of rich fertiliser for them.
By the way, it's e^{i*pi} that's equal to -1 (the exponent is pi times i, not pi divided by i)

Cannabis will also be here after we are gone to be picked up by aliens who wind up getting super smart from it and making this universe and the Circle Continues...

Evolution. There's no thought process behind it all...it just happens. Cannabis evolved to have flowers because birds and animals were eating the cannabis with the nicest flowers and spreading that about. Cannabis doesn't make itself stronger, its selectively bred to be stronger.
Have a look at what normal veg used to look like before selective breeding. Corn looks like a completely different plant than what it used to now.
Have a look at what normal veg used to look like before selective breeding. Corn looks like a completely different plant than what it used to now.

Check out The Botany of Desire by Michael Pollan. It’s a whole book on this exact subject. I can’t recall exactly but I think it looks at apples, cannabis and tulips as examples of how some plant species have thrived by “getting” humans to cultivate them.
He has a few others that are also great, like How to Change Your Mind, which is about psychedelics.
He has a few others that are also great, like How to Change Your Mind, which is about psychedelics.

Bought the book on your rec (thanks!) and I’m reading it now. Lovely read and very credible theories!

Thank you. I think it’s the first time anyone’s bought a book I recommend 🤗
I’ve read a few of his books - love his writing on food (Omnivores dilemma) and psychedelics (how to change your mind)
I’ve read a few of his books - love his writing on food (Omnivores dilemma) and psychedelics (how to change your mind)

I enjoyed his 'How to Change your Mind' videos, and with Polly's recommendation I've just ordered it too. Thanks for posting about it 👍

You’re welcome! I just finished the marijuana section and I think it’s beautifully written. I love the combination of science, literature and experience and he genuinely strives to capture what being “high” actually is and why it matters. How everyday experiences are made banal by our minds to prevent sensory overload but how being high plays with our short term memory reintroducing the “wonder” into the simplest things! I totally get it!
I’m going to look up his other books too! 😍
I’m going to look up his other books too! 😍

One day the plant will reclaim all the money that has ever changed hands in it's name, it will then have enough to take over the world, a bit like A day of the Triffids, the world would smell great.

Shit I've never considered this, just like how bugs are attracted to the bright colorful flowers....
🤯🤯🤯🤯🤯🤯🤯
🤯🤯🤯🤯🤯🤯🤯

It's even more stark if you view flowers in ultraviolet light (the range that insects see in), a whole extra bunch of patterns appear. Orchids are excellent mimics of whole insects, the pollinator thinks it's gonna get a shag out of it! Same applies to some flowers that use small birds (e.g. hummingbirds) to spread their pollen.

Fascinating thought but like other species on this planet we have chosen it to be one that we have removed its natural evolution through selective breeding,we do this with both animals and plants. Most people forget that before the big corporations started the anti-cannabis movement in governments it was widely used in everyday life and not just to smoke it was the basis for many things and also employed lots of people and any half decent apothecary would have cannabis products instead of opium products.
Unfortunately the bad guys won but slowly cannabis is making a comeback from all the lies told about it.
Unfortunately the bad guys won but slowly cannabis is making a comeback from all the lies told about it.

once you transcend darwinian evolution the only thing left is intelligent design. i guess that will take a while

Cannabis is a Master plant like Ayahuasca, Peyote, Mushrooms etc. It has been used for centuries by shamans not only for its healing properties but also for the expanding of consciousness. It is our over use of this plant and our breading of it for higher THC levels that is likely not always the best course of action. Once we go back to a way of using it ceremonialy and respecting it as such is when She can finally work in the way that she has been working since time began. Many are sick from over use these days because we have lost this reverence and respect it needs to be up there with all other psychedelics. It is attracting us like a double edge sword…we either understand and respect her power to obtain the healing we need in this time to be able to evolve with the shift on consciousness or we keep on using and abusing her and in the end it will always only be us that suffer…plants don’t need us and will long survive once we perish …just a thought;-)

Sorry to go all Sheldon Cooper on you but.. it's a no for me.
Cannabis evolved to produce THC as an evolutionary defence mechanism because it is particularly susceptible to pathogens.
It's clear that the consequences of that are of great benefit to some - but I think it is a better question to wonder if all those consequences are a coincidence or by intelligent design in the first place. Given that we have ALOT of cannibinoid receptors - the coincidence seems pretty astounding.
Given this - I do wonder if there is an epigenetic factor to the differences in strength between strains as well as a domestication factor.
Cannabis evolved to produce THC as an evolutionary defence mechanism because it is particularly susceptible to pathogens.
It's clear that the consequences of that are of great benefit to some - but I think it is a better question to wonder if all those consequences are a coincidence or by intelligent design in the first place. Given that we have ALOT of cannibinoid receptors - the coincidence seems pretty astounding.
Given this - I do wonder if there is an epigenetic factor to the differences in strength between strains as well as a domestication factor.

1 post
+1 votes

on
BuxomHobbit
Has anyone else noticed how many anti-depressants make it harder to get high on weed? Dose anyone know how and/or why?
Sure they are anit-depressants and not anit-psychotics prescribed as anit-depressants?
Give me some names.

on
BuxomHobbit
Has anyone else noticed how many anti-depressants make it harder to get high on weed? Dose anyone know how and/or why?


Personally, my SSRIs never caused any issues with weed, only psychedelics. Here's a useful chart

Just like weed itself, any drug affects people differently. Anti-depressants are no different. I always have the opinion of them being useless as all they do is numb what you are feeling rather than "getting rid" I guess is the best way of saying it. I was noticing myself feeling empty, not feeling sad nor happy, just nothing. I'd rather be miserable than that however in your instance it could help you a lot more than it does with me. I'd always say to only take them when you really feel it's needed. Don't try and stay on them for as long as you can and treat it like an "alternative" because you'll start having problems elsewhere before you know it.

I can corroborate this though as pointed out every body is different. For me, getting high took less effort after I stopped taking them but comes with its own set of drawbacks. You should speak to your doctor if they're not working for you as they might be able to switch you to something else. Weed is good at treating the symptoms but not the underlying cause.

Weed certain doesn’t have your mrs thinking you’ve gone off her/cheating on her because your sex drive totally disappears. Guaranteed every time. I asked a Dr and was told I would not find one that doesn’t affect labido.
I’ve seen someone that didn’t have their meds like that for a day and half—NOT PRETTY ATALL.
Good luck.
I’ve seen someone that didn’t have their meds like that for a day and half—NOT PRETTY ATALL.
Good luck.

Redeyejedi25 puts it brilliantly.
Such pharmaceuticals fuck with the neurotransmitters and receptors in the brain, often blocking them, leading to hypersensitivity when you stop, which can cause a whole host of terrible problems.
Please see this audiobook 'Niacin: the real story' on Amazon:
https://www.amazon.co.uk/Niacin-Story-Wonderful-Healing-Properties/dp/1591202752
It details how Niacin has been used in orthomolecular medicine in treating mental health issues with nothing short of astonishing results.
And if of interest, see this study on the protective qualities of Manganese bisgylcinate during cessation of certain pharmaceuticals, published in the journal of orthomolecular medicine.
https://isom.ca/wp-content/uploads/2020/01/JOM_1976_05_1_02_Manganese_and_Niacin_in_the_Treatment_of_Drug-.pdf
Both of these are naturally occurring nutritional substances that the body already uses and collects via food.
See this wonderful fella's bitchute channel:
https://www.bitchute.com/channel/BSeb5zNYuBZj/
🙏
Such pharmaceuticals fuck with the neurotransmitters and receptors in the brain, often blocking them, leading to hypersensitivity when you stop, which can cause a whole host of terrible problems.
Please see this audiobook 'Niacin: the real story' on Amazon:
https://www.amazon.co.uk/Niacin-Story-Wonderful-Healing-Properties/dp/1591202752
It details how Niacin has been used in orthomolecular medicine in treating mental health issues with nothing short of astonishing results.
And if of interest, see this study on the protective qualities of Manganese bisgylcinate during cessation of certain pharmaceuticals, published in the journal of orthomolecular medicine.
https://isom.ca/wp-content/uploads/2020/01/JOM_1976_05_1_02_Manganese_and_Niacin_in_the_Treatment_of_Drug-.pdf
Both of these are naturally occurring nutritional substances that the body already uses and collects via food.
See this wonderful fella's bitchute channel:
https://www.bitchute.com/channel/BSeb5zNYuBZj/
🙏

Ssri's inhibit the reuptake of serotonin, Cannabis also interfaces with serotonin in some ways so the ssri could be blocking the serotonin being affected by cannabis.
Maoi's interrupt neurotransmitters which would also alter or inhibit the effects cannabis has on neurotransmitters.
Most if not all antidepressants interact with serotonin, dopamine or other neurotransmitters and hormones effected by cannabinoids and terpenes.
For most depression cases I think choosing either antidepressants or cannabis is most effective as using both can leave a lot of people in a limbo state. There are lots of effective ways to manage your dopamine/serotonin that don't involve medicine, and a lot of them are great to combine with weed.
I manage my depression through dopamine detoxes, natural supplements, meditation and other techniques so that I can smoke weed without antidepressants and it works pretty well for me.
All the best
Maoi's interrupt neurotransmitters which would also alter or inhibit the effects cannabis has on neurotransmitters.
Most if not all antidepressants interact with serotonin, dopamine or other neurotransmitters and hormones effected by cannabinoids and terpenes.
For most depression cases I think choosing either antidepressants or cannabis is most effective as using both can leave a lot of people in a limbo state. There are lots of effective ways to manage your dopamine/serotonin that don't involve medicine, and a lot of them are great to combine with weed.
I manage my depression through dopamine detoxes, natural supplements, meditation and other techniques so that I can smoke weed without antidepressants and it works pretty well for me.
All the best

Sorry Hobbit - its not been an issue for my wife.
We've been daily users of hash for 35 years and my wife has been medicated for 20 of these years, but has no issue getting high at all weather smoking vaping or edibles.
Her medication has changed a few times over the years but there been no effect on her high regardless of which med shes been on.
Really sorry to hear your meds effect you like this, and I'm only sharing my experiences to let you know its not a definite effect for everyone.
I do hope you find the med/ gear combination that will work for you - take care.
We've been daily users of hash for 35 years and my wife has been medicated for 20 of these years, but has no issue getting high at all weather smoking vaping or edibles.
Her medication has changed a few times over the years but there been no effect on her high regardless of which med shes been on.
Really sorry to hear your meds effect you like this, and I'm only sharing my experiences to let you know its not a definite effect for everyone.
I do hope you find the med/ gear combination that will work for you - take care.

SSRI.....the acceptable way to cull the population?? ...eugenics ?? kinda easy to make people with issues to take a pill that basically makes them sterile....hey who the fuck wants more fucked up people being born right?? sorry i am a little wasted

Its just like if you take amphetamines you cant get stoned like you want to no matter how much you smoke.

Sure they are anit-depressants and not anit-psychotics prescribed as anit-depressants?
Give me some names.
Give me some names.

I take an MAOI antidepessant called Nardil, mood stabilizer Lamictal, Ativan, and a small dose of Vraylar.
No impact on getting high from hashish or flower. Impacts the high of psilocybin mushrooms, requiring larger dose.
Try to stay the hell away from Nardil or any MAOI med. Way too many drug and food interactions, even though it is an effective antidepressant. But so is psilocybin combined with psychedelic therapy.
No impact on getting high from hashish or flower. Impacts the high of psilocybin mushrooms, requiring larger dose.
Try to stay the hell away from Nardil or any MAOI med. Way too many drug and food interactions, even though it is an effective antidepressant. But so is psilocybin combined with psychedelic therapy.

Sometimes i think they prescribe stuff like Nardil and Lamictal just to keep you addicted.
My brother is bi polar and for years they were prescribing him all sorts of crap until one day he broke down in front of me about what he was taking, i told him all about the evil drugs he was taking well he stopped taking them and is now clean and healthier than he has been in decades and most importantly he is no longer suicidal.
My brother is bi polar and for years they were prescribing him all sorts of crap until one day he broke down in front of me about what he was taking, i told him all about the evil drugs he was taking well he stopped taking them and is now clean and healthier than he has been in decades and most importantly he is no longer suicidal.

How long have you been on Nardil? most docs stopped prescribing MAOI's in the 1980's or are you in the US?

Indicas can exacerbate depression, as can sativas in certain circumstances. Advice like that should be avoided. Everyone is different and each strain can have a different effect on a different person. Consumption method is also relevant. Don't believe anything anyone tells you (including me), except for a qualified medical professional with experience in using THC for treating depression.

true this but that pro would still not be able to predict the effects of cannabis for a particular patient. small trial and error with safe substances seems a much better bet especially when you consider the corruptions inherent to medical systems all over the world.

doctors are like naive kids parented by the insurance companies or state medical systems. they wind up imitating their parents.

My doctor told me that the mushrooms and THC would help my depression and to crack on. I wonder what his parents were like!

If you want to use any cannabis as an antidepressant you have to combine it with other techniques to manage your mental health, weed alone can't manage it for a lot of people.

Agreed. I combine with a healthy diet, cardio, weight lifting, and hill walking. I'll still a miserable bastard, but enjoying life more!

Id be on the sofa all day if I was on Indica all day. If I could afford all the bud necessary I would. The sativa or highbrid mixes suit me best. The more uplifting cerebral high is unparalleled for anxiety disorders

Dunno about you But here the British NHS prescribe stupid amounts of them in a variety of types for multiple multiple issues.
If you mean on here, I'v not seen any.
If you mean on here, I'v not seen any.

Just a matter of time before cannabis becomes a government racket too, hang in there cowboy.

I have a low immune system and quite often get a cold, headache etc for just a day and if I smoke then I very rarely get stoned.
A few times in the best ive smoked weed just after taking sleeping tablets and it tripped me out and haven't gone to sleep for ages.
A few times in the best ive smoked weed just after taking sleeping tablets and it tripped me out and haven't gone to sleep for ages.

Think about fermented foods for the low immune system. Kefir, probiotic yoghurts, and stuff like kimchi or sauerkraut. A healthy microbiome will heavily increase your immune powers!

1 post
+3 votes

on
{nations}
is the coronavirus bio warfare?
Undoubtedly the powers that be have concocted this virus to thin the herd of the weak and terrify the populace into obedience.

on
{nations}
is the coronavirus bio warfare?
if there is a simple effective way to win the economy back from china this it. the technology is there, the motive and so is the will in the american government.

You lot having been hitting the ganja too hard! It’s simple biology that caused this outbreak. When living things breed their dna is copied but this isn’t a perfect process and sometimes errors in this process causes mutations. Where viral generations can be a matter of minutes rather than years microbial life is much more susceptible to mutations such as becoming more virulent and resistant to existing medicine. Or as is suspected in this outbreak a type of virus may live happily in a certain species of animal without causing harm but a mutation allows it to cross the species barrier and infect humans, but where humans aren’t it’s usual host it can cause harm. Unfortunately this is more common in areas where bush meat is traded because your going to get a range of different animal diseases that may cross the species barrier and there’s no biohazard control like you would get in an abattoir. Seriously, linking Coronavirus with 5g and the royals!? Why not throw in reptilians for good measure? Posts like this make me weep for humanity.

Is it a coincidence that the only level 4 biological research in China is in Wuhan, was studying Coronaviruses and the Harvard professor paid by the Chinese govt to set the lab up has been arrested by the USA recently?
Just like Jimmy Savile, procurer of children for the elite was best friends with Prince Charles and Jeffery Epstein, procurer of children for the elite was best friends with Prince Andrew. All a coincidence, nothing to see.
No reptiles required.
Just like Jimmy Savile, procurer of children for the elite was best friends with Prince Charles and Jeffery Epstein, procurer of children for the elite was best friends with Prince Andrew. All a coincidence, nothing to see.
No reptiles required.

i checked your lab comment and it is verifiable. way way too strange that the only lab in china is in wuhan.
"The facility, known as the Wuhan National Biosafety Laboratory, is housed within the Chinese Academy of Sciences and was specifically designed to help Chinese scientists "prepare for and respond to future infectious disease outbreaks,"
It was created after SARS, you gotta wonder just how they were "preparing" at this lab. You don't need anything sinister for this theory, you just need incompetence at the lab.
"The facility, known as the Wuhan National Biosafety Laboratory, is housed within the Chinese Academy of Sciences and was specifically designed to help Chinese scientists "prepare for and respond to future infectious disease outbreaks,"
It was created after SARS, you gotta wonder just how they were "preparing" at this lab. You don't need anything sinister for this theory, you just need incompetence at the lab.

The conditions of this lab were investigated a few years ago by the American government, during the time that the lab was advertising jobs for coronavirus researchers. The conditions were extremely poor.

What makes me weep for humanity is those with room-temperature IQs who took obvious lies at face value, rolled up their sleeves, and now try pretending they have no idea why 1500 athletes have died in two years etc etc.

Myocarditis and sudden heart attacks or even deaths are at an all time high atm and might even continue to surge. Yesterday we had a "new unknown" sickness in the media Tell-A-Vision outlets called "ME/CFS" basically all the symptoms of vaccination damage. Its devastatingly shocking to see that many athletes die while active a game of whatever they professionay play.
Heads up to Novak Djokoviç btw for speaking out against the vaccines.
Heads up to Novak Djokoviç btw for speaking out against the vaccines.

I was an anti vaxer so didn’t willingly roll up my sleeve till I caught Covid and spent the next 3 weeks hooked up to machines in ICU. It’s kinda fucked me up in the long run too. During my recovery I spoke to a dr who was an expert on biology and had done a thesis on viruses in university. He explained to me how it works and how it has mutated and most likely jumped from species to species. As humanity continues to expand across the globe at a rapid rate pandemics will happen. We will most likely get another in the next 30 years. Why the vaccine was created so quickly was it had been worked on for years. Since the SARS outbreak in Asia in the early 2000s. As coronavirus is a type of SARS or is very closely related (on this I’m not sure) it wasn’t really created quickly. Doctors and scientists just had to adapt their work slightly. It wasn’t an easy process by any means but so many people will involved in its creation. I respect everyone’s rights and opinions on vaccines but really they are a GREAT thing. Much peace and love.

Corona virus and SARS are completely different…also the vaccine was being worked on for years…a number of years ago. It failed trials as a cancer treatment drug because of respitpry problems. All this information was easily searchable on Google the day the vaccine was announced, since it has been buried by propaganda.
In regards to the doctor (of medicine, not viruses) he is contradicting the professionals who have been studying the coronavirus in bats for years. As it was the virus was nowhere near “jumping species” in its evolution. The wet market theory was debunked a little while ago also..
The mad thing is all the information Elon Musk released in his Twitter Files where he found collusion between govornment and all social media platforms to only promote their plan and to silence (or deplatform) anyone (including professionals in virus and pandemics) that strayed from the government’s stance. They even silenced the pandemic professionals who advised against vaccinating during an active plandemic as it would induce mutations and variants of the virus…odd what happened next.
Back to the original question? No, it wasn’t biological warfare, it was a psychological experiment in societal control…all over the world and 99% of people rolled over…this is all my own opinion which was gleamed with massive research.
In regards to the doctor (of medicine, not viruses) he is contradicting the professionals who have been studying the coronavirus in bats for years. As it was the virus was nowhere near “jumping species” in its evolution. The wet market theory was debunked a little while ago also..
The mad thing is all the information Elon Musk released in his Twitter Files where he found collusion between govornment and all social media platforms to only promote their plan and to silence (or deplatform) anyone (including professionals in virus and pandemics) that strayed from the government’s stance. They even silenced the pandemic professionals who advised against vaccinating during an active plandemic as it would induce mutations and variants of the virus…odd what happened next.
Back to the original question? No, it wasn’t biological warfare, it was a psychological experiment in societal control…all over the world and 99% of people rolled over…this is all my own opinion which was gleamed with massive research.

Don't you feel dumb for believing all the lies though?
And even dumber for trying to gaslight others as "hitting the ganja too hard"?
Or are you still hidden under a rock with your fingers in your ears screaming "lalalalala I CANT HEAR YOU".
And even dumber for trying to gaslight others as "hitting the ganja too hard"?
Or are you still hidden under a rock with your fingers in your ears screaming "lalalalala I CANT HEAR YOU".

Coronavirus doesn’t have DNA, it’s not even really alive. It’s just a code of RNA
Like a computer virus it can only “live” and replicate inside a host
Like a computer virus it can only “live” and replicate inside a host

You should get out of that confi barrel of yours and start researching things for yourself than listening to the mainstream media. There was a paper published by a Uni don't remember which one as I read this 2 years ago but they researched the COVID virus and guess what parts of the virus does not occur in nature thus man made. Furthermore a virologist came out and said the same thing. As he did that they tried to cancel him. It's a good time to wake up buddy

You seen the Twitter Files yet?
They deplatformed some pandemic professional who was saying vaccinating during a pandemic would invoke variants and mutations of the virus…he was so right…but you know, we smoke too much ganja and it’s all a coincidence 🤷♂️
They deplatformed some pandemic professional who was saying vaccinating during a pandemic would invoke variants and mutations of the virus…he was so right…but you know, we smoke too much ganja and it’s all a coincidence 🤷♂️

I respect your opinion dude but you need to be able to back your source up. Not just say it was a paper you read from a university you can’t remember the name of.

Oh the source bashing lameness... this isn't arguing...lol...
All sources are fallible, and nowadays the more "verified" the less true....
All sources are fallible, and nowadays the more "verified" the less true....

All what I wanted to say is once you start doing some digging it becomes clear that all this COVID plandemic was one very fishy business. I don't think that's a secret anymore. Sorry but I don't have time to search all these papers up again you will have to do it yourself.

It’s a good time to get a proper scientific education and learn how to weigh up multiple peer reviewed studies rather than relying on that one thing you read somewhere once.

Some comments have not aged well.
Hope you have called your conspiracy theory friends and apologised?
Hope you have called your conspiracy theory friends and apologised?

But speaking scientifically, here is an article form TheScientist in 2015 discussing how the sars coronavirus cross, created in a lab, by Ralph Baric, is a bad thing. Ralph argues otherwise.
https://www.the-scientist.com/news-opinion/lab-made-coronavirus-triggers-debate-34502
conspiracy my arse, its a coup. the greatest transfer of wealth in history.
https://www.the-scientist.com/news-opinion/lab-made-coronavirus-triggers-debate-34502
conspiracy my arse, its a coup. the greatest transfer of wealth in history.

You know it was man made in a lab tho don’t you? And probably released on purpose? The amount of civil unrest in the world, the obscene amounts of money that lots of people have made from it, the control back in the hands of the governments of the world?
The mRNA vaccine has been around for about a decade. They’d been trying to get funding to test it uni a human population but no one wanted to fund it. They were just about to have to give up on years of hard work and money, then coincidentally, everyone got Covid and special laws were passed that meant they could administer it without the proper research done on it. And now they’ve made a shit tonne of money.
It’s not all coincidental and it wasn’t an accident.
The mRNA vaccine has been around for about a decade. They’d been trying to get funding to test it uni a human population but no one wanted to fund it. They were just about to have to give up on years of hard work and money, then coincidentally, everyone got Covid and special laws were passed that meant they could administer it without the proper research done on it. And now they’ve made a shit tonne of money.
It’s not all coincidental and it wasn’t an accident.

I thought the same at the time. But there are genetic markers in coronavirus that couldn't have got in there naturally.
The current most plausible theory is that there was an accidental leak from the lab, caused by lax bio-security that had been highlighted in the past.
Check out John Sudworth's BBC podcast "Fever: The Hunt for Covid's Origin"
The current most plausible theory is that there was an accidental leak from the lab, caused by lax bio-security that had been highlighted in the past.
Check out John Sudworth's BBC podcast "Fever: The Hunt for Covid's Origin"

this describes everyone here (without regard to planetary origin) the trick dear biggaz is to see all sides and remain open until a conclusion is actually required.

…
If you actually look at 5g you will see that over 130 thousand 5g towers were put in china in 2019 in the bid to win this stupid 5g race.
November to be exact is when it all started with the mass 5g installations and yet thats also when the first case of coronavirus was confirmed.
With over 10 thousand being installed in wuhan alone.
You look at side effects from emf frequencies and a lot of it could well be linked. It does have the potential to mutate things.
America has approximately 10 thousand 5g antennas throughout the whole country to put it into perspective.
Look at the amount of emf related complaints in america alone.
Recently near me they turned on 5g and 200 birds fell out of the sky. The news tried to say oh must of been a bird of prey ? things arent always black and white. Coronavirus is just another virus they are using to fear monger. Then there will be a vaccine for it.
Every year its the same. Sars. Bird flu. Swine flu. Ebola. The normal flu. Same shit every year . People just got to open their eyes.
November to be exact is when it all started with the mass 5g installations and yet thats also when the first case of coronavirus was confirmed.
With over 10 thousand being installed in wuhan alone.
You look at side effects from emf frequencies and a lot of it could well be linked. It does have the potential to mutate things.
America has approximately 10 thousand 5g antennas throughout the whole country to put it into perspective.
Look at the amount of emf related complaints in america alone.
Recently near me they turned on 5g and 200 birds fell out of the sky. The news tried to say oh must of been a bird of prey ? things arent always black and white. Coronavirus is just another virus they are using to fear monger. Then there will be a vaccine for it.
Every year its the same. Sars. Bird flu. Swine flu. Ebola. The normal flu. Same shit every year . People just got to open their eyes.

I personally feel mass 5g installations are causing a lot of side effects . Pneumonia is even a side effect of emf frequencies so really does make you wonder.

bio warfare/public health research fuck up
or
malicious shit dropped w cover of lab?
when you cant trust government to not kill people anyway does it matter?
or
malicious shit dropped w cover of lab?
when you cant trust government to not kill people anyway does it matter?

I’ll play the tinfoil hat card in that case:
The level 4 bio lab in wuhan was funded by the Americans and traces back to non other than Jeffery Epstein/Harvard university (see YouTube: Shaun Attwood’s Jeffery Epstein playlist vids).
The idea is in the short term to undermine the Asian economy (working well) and in the long term to assist in the Committee of 300/Black Monarchy plan to reduce the global population by 50% by 2050. Big Pharmaceutical companies will make huge profits also which all go back to the 300.
See ‘The Committee of 300 by Dr. John Coleman’ in YouTube. This will show the truth to those with eyes to see.
It is just 1 small thread.
5g will make many of us infertile in the short term and cause cancer in the longer term. The weaponised aspect with full coverage will make protest or revolt near on impossible.
The goal is 1 world government with the masses easily managed.
Lots of us are waking up. We can stop this. I am not the masses, I am an individual.
The elite nonces want total power. Let’s stand up and say no. Join your local ‘no 5g’ group and get up and protest. For your kids sake. As the lyrics say if you tolerate this then your children will be next. Take 5 mins and look at the vids. Look at Prince Andrew’s victim Virginia Giuffre’s twitter page. She provides documents from California courts claiming Donald Trump raped a 13 year old child. Why was the case dropped? Why don’t we hear about it? Why do the elites (Clinton, trump, Heath, the royals, etc etc) all nonce? The truth is in plain sight.
Jimmy Savile was prince Charles best mate and gave marriage counciling to Diana. She wrote about it in her autobiography.
Charles best mate: Savile. Andrews best mates: Epstein and maxwell. If you read this far then peace and love.
We are waking up.
The level 4 bio lab in wuhan was funded by the Americans and traces back to non other than Jeffery Epstein/Harvard university (see YouTube: Shaun Attwood’s Jeffery Epstein playlist vids).
The idea is in the short term to undermine the Asian economy (working well) and in the long term to assist in the Committee of 300/Black Monarchy plan to reduce the global population by 50% by 2050. Big Pharmaceutical companies will make huge profits also which all go back to the 300.
See ‘The Committee of 300 by Dr. John Coleman’ in YouTube. This will show the truth to those with eyes to see.
It is just 1 small thread.
5g will make many of us infertile in the short term and cause cancer in the longer term. The weaponised aspect with full coverage will make protest or revolt near on impossible.
The goal is 1 world government with the masses easily managed.
Lots of us are waking up. We can stop this. I am not the masses, I am an individual.
The elite nonces want total power. Let’s stand up and say no. Join your local ‘no 5g’ group and get up and protest. For your kids sake. As the lyrics say if you tolerate this then your children will be next. Take 5 mins and look at the vids. Look at Prince Andrew’s victim Virginia Giuffre’s twitter page. She provides documents from California courts claiming Donald Trump raped a 13 year old child. Why was the case dropped? Why don’t we hear about it? Why do the elites (Clinton, trump, Heath, the royals, etc etc) all nonce? The truth is in plain sight.
Jimmy Savile was prince Charles best mate and gave marriage counciling to Diana. She wrote about it in her autobiography.
Charles best mate: Savile. Andrews best mates: Epstein and maxwell. If you read this far then peace and love.
We are waking up.

ridiculous, if the us engineered something like this wouldn't they first go after their #1 enemy, the iranian governement?
wait a sec...
wait a sec...

Not my opinion but Il play the other card, for the purpose of debate.
China did this to themselves, intentionally. What better way to elevate your economy than to release pathogen which will breeze over the healthy, yet kill sick and old people. Minimising/removing welfare and health costs and leaving behind an entire working populous. What a way to beat the tariffs...wanna bet the cure comes from china too?
FWIW I despise conspiracy theories, they are based in fear and ignorance, all are entitled to their own thoughts though!
As I said this is not my opinion, but we live in a world where all things must be considered, even the things which at times seem impossible are more often than not, just improbable.
Peace x
China did this to themselves, intentionally. What better way to elevate your economy than to release pathogen which will breeze over the healthy, yet kill sick and old people. Minimising/removing welfare and health costs and leaving behind an entire working populous. What a way to beat the tariffs...wanna bet the cure comes from china too?
FWIW I despise conspiracy theories, they are based in fear and ignorance, all are entitled to their own thoughts though!
As I said this is not my opinion, but we live in a world where all things must be considered, even the things which at times seem impossible are more often than not, just improbable.
Peace x

population control lol
If them riots had spread to mainland China how much would that affect the economy
Just throwing some stuff out there
If them riots had spread to mainland China how much would that affect the economy
Just throwing some stuff out there


you wanna corona virus conspiracy eh? well, just ask yourself who profits here

New world order.
Goal - population under 500,00,000
Time frame - 100 yrs
How to achieve?
Release a virus that scares the world into hiding.
Wait until it spreads globally, killing the elderly and sick in wave one.
Produce a vaccine within a year, that offers people hope of a return to normality, without fear!
Vaccine designed to sterilize 80% of population.
In the mean time, allow virus to reach up to 8 waves before population has been completely vaccinated.
I mean....if i was to theorize.... ;)
Goal - population under 500,00,000
Time frame - 100 yrs
How to achieve?
Release a virus that scares the world into hiding.
Wait until it spreads globally, killing the elderly and sick in wave one.
Produce a vaccine within a year, that offers people hope of a return to normality, without fear!
Vaccine designed to sterilize 80% of population.
In the mean time, allow virus to reach up to 8 waves before population has been completely vaccinated.
I mean....if i was to theorize.... ;)

I certainly wont have any vaccination for sure. I wager though the governments will make it passive aggressive mandatory. What i mean by that is they probably wont make the jab law, but ibet eventually those that decline the jab will be forbidden from foreign travel or something similar. I guess covid is their way of stopping global warming.

I got the vaccine because it’s specifically for COVID-19, I don’t get the flu jab because that really is some one picking 5 strains at random for the pharms Xmas bonus

Funny how you say two contrary things within one statement. You got the vaccine for Covid-19, but not the flu shot because there are so many new flu mutated strains every year. Actually that is the contrary thing in your statement, why you might ask?
A breef overview of many (not all) Covid-19 mutations/strains:
https://www.cdc.gov/coronavirus/2019-ncov/variants/variant-classifications.html#anchor_1679059484954
So you are telling me that this would not be close to the case of the flu shots which are just moneymaking for Pharma as you mentioned earlier. Of course not all covid strains still roam around but it certainly is not only one single mutation that is infecting in waves, there are always multiple strains of Covid-19 circulating in populations. Today they stilm vaccinate people with the first vaccine for that very firsr Covid-19 strain. Now we have hundreds of covid strains and many subtypes. Lmao
A breef overview of many (not all) Covid-19 mutations/strains:
https://www.cdc.gov/coronavirus/2019-ncov/variants/variant-classifications.html#anchor_1679059484954
So you are telling me that this would not be close to the case of the flu shots which are just moneymaking for Pharma as you mentioned earlier. Of course not all covid strains still roam around but it certainly is not only one single mutation that is infecting in waves, there are always multiple strains of Covid-19 circulating in populations. Today they stilm vaccinate people with the first vaccine for that very firsr Covid-19 strain. Now we have hundreds of covid strains and many subtypes. Lmao

Well as a frontline worker I was vaccinated first before most of these variants happened. I don’t get vaccinated now due to what you have stated.

I commented before, but this time i'll just add some links.
They've been doing hella lot of research on corona viruses and enhancing potency of the viruses. Their research was US funded.
All the information is there is you look.
They've been isolating bat corona and seeing the infectiousness since 2000!
They also mention that the ageing population would be most affected.
And all of these studies are from 5 years ago.
It is a financial plan and a way to change civil liberty.
Period.
They've been doing hella lot of research on corona viruses and enhancing potency of the viruses. Their research was US funded.
All the information is there is you look.
They've been isolating bat corona and seeing the infectiousness since 2000!
They also mention that the ageing population would be most affected.
And all of these studies are from 5 years ago.
It is a financial plan and a way to change civil liberty.
Period.

Will add my long, angry 2 cents.
If you really honestly think all this was a natural incidence and don't see that there is provably a new agenda to restrict and control individuals freedoms with multiple prongs since this farce, then you are a stupid, stupid, gullible cunt that deserves to be a digital slave imprisoned in your own home..
It is unfathomable right now that you don't get it.
The gullibility and endless trust in convicted fellons with criminal records and legal indemnity is the only thing anybody should be weeping for humanity for.
Unless you are burying your gullible head in the sand, because you were shamefully cruel to others not as gullible as you, pick up your phone and apologise to your friends that you called insane fringe lunatics because of a medical procedure they didn't want.
How did the whole free world turn into conformity bullies? Some of the comments have aged like a 1 year old salmon. Do any of you feel dumb for buying this and shaming others who were skeptical?
Noam chomsky, Neil Young. All of em sold out, along with the average person..
What you are seeing on this thread by the people who refuse to see anything untoward is simply the old "easier to fool somebody than convince them they were fooled".
Idiots.
If you really honestly think all this was a natural incidence and don't see that there is provably a new agenda to restrict and control individuals freedoms with multiple prongs since this farce, then you are a stupid, stupid, gullible cunt that deserves to be a digital slave imprisoned in your own home..
It is unfathomable right now that you don't get it.
The gullibility and endless trust in convicted fellons with criminal records and legal indemnity is the only thing anybody should be weeping for humanity for.
Unless you are burying your gullible head in the sand, because you were shamefully cruel to others not as gullible as you, pick up your phone and apologise to your friends that you called insane fringe lunatics because of a medical procedure they didn't want.
How did the whole free world turn into conformity bullies? Some of the comments have aged like a 1 year old salmon. Do any of you feel dumb for buying this and shaming others who were skeptical?
Noam chomsky, Neil Young. All of em sold out, along with the average person..
What you are seeing on this thread by the people who refuse to see anything untoward is simply the old "easier to fool somebody than convince them they were fooled".
Idiots.

Such a fantastic comment this, i agree with everything you've said and i very much feel your anger
not a day goes by in my entire adult life where i haven't seen blatant reprehensible corruption at all levels of politics, science, medicine and academics all over the world, and of course nothing ever changes, nobody ever gets held accountable and even if the story gets aired in the mainstream it's quickly forgotten because come the next day you're already being bombarded with utter distracting nonsense
i've always noticed how incapable of critical thinking the average person is, unfortunately most of my friends and family are this way and since the pandemic, it's really taught me that most people are actually incapable of thinking, they're basically just organic robots with programmed social affinity executing genetic code, even their ability to talk is just a matter of repetition, they have absolutely no original thoughts and their alleged values and morality are born out of mimicking the words and behaviors of either actual people or media consensus
i've spent so many years working alongside these actual NPC's, engage these people in conversation and you will see that all of the things the average human “thinks” are either what the media or the tribe has told them to believe or what they repeat from real people, not things they've actually thought and considered (because they don't have that ability)
Stupid, stupid gullible cunts.
not a day goes by in my entire adult life where i haven't seen blatant reprehensible corruption at all levels of politics, science, medicine and academics all over the world, and of course nothing ever changes, nobody ever gets held accountable and even if the story gets aired in the mainstream it's quickly forgotten because come the next day you're already being bombarded with utter distracting nonsense
i've always noticed how incapable of critical thinking the average person is, unfortunately most of my friends and family are this way and since the pandemic, it's really taught me that most people are actually incapable of thinking, they're basically just organic robots with programmed social affinity executing genetic code, even their ability to talk is just a matter of repetition, they have absolutely no original thoughts and their alleged values and morality are born out of mimicking the words and behaviors of either actual people or media consensus
i've spent so many years working alongside these actual NPC's, engage these people in conversation and you will see that all of the things the average human “thinks” are either what the media or the tribe has told them to believe or what they repeat from real people, not things they've actually thought and considered (because they don't have that ability)
Stupid, stupid gullible cunts.

Yes, it seems like believing that individual rights (like bodily autonomy) are not negotiable makes you crazy, fringe and anything else negative nowadays.
The subtle conditioning makes progressives point at any libertarian (whether left or right leaning) and make a flurry of outrageous accusations just by the virtue they believe in strong individual and property rights instead of focusing on group rights.
The same people used the same bodily autonomy argument they rejected during covid to show their disgust at the repeal of Roe v Wade (which was a backwards step for America in my opinion).
Individual rights bad, group rights good... that was widespread. I lost count how many times somebody tried to say it was different because you can't transmit pregnancy. Most insane thing I ever heard.
It's ridiculous that anybody has to be persuaded to care about their freedom. To the point I have given up trying.
I don't believe in unrealistic or far fetched stories about satanism, flag earth or shape-shifting reptilian from the lower fourth dimension.
But this was clear - a small cabal of rich people and scientists in prominent positions hijacked science for their own purpose and that is an irrefutable fact after recent leaks.
What good does clinging onto the ghost of the wuhan fish market bat shit do anybody?
Anyway, nice to hear from somebody like minded and angry 🤣
The subtle conditioning makes progressives point at any libertarian (whether left or right leaning) and make a flurry of outrageous accusations just by the virtue they believe in strong individual and property rights instead of focusing on group rights.
The same people used the same bodily autonomy argument they rejected during covid to show their disgust at the repeal of Roe v Wade (which was a backwards step for America in my opinion).
Individual rights bad, group rights good... that was widespread. I lost count how many times somebody tried to say it was different because you can't transmit pregnancy. Most insane thing I ever heard.
It's ridiculous that anybody has to be persuaded to care about their freedom. To the point I have given up trying.
I don't believe in unrealistic or far fetched stories about satanism, flag earth or shape-shifting reptilian from the lower fourth dimension.
But this was clear - a small cabal of rich people and scientists in prominent positions hijacked science for their own purpose and that is an irrefutable fact after recent leaks.
What good does clinging onto the ghost of the wuhan fish market bat shit do anybody?
Anyway, nice to hear from somebody like minded and angry 🤣

i think youre having fun with this but if not how would such a secret ever be kept? it goes strongly against the most instinctive of human instincts to do this and keep quite about it.

The ways we receive our information are controlled.
A handful of major companies own the media.
Information is compartmentalised.
Silence is gained through money, threats/blackmail or killing/suiciding.
Check out the ‘Clinton body count’ and see how many of his close personal friends and bodyguards have died in light aircraft accidents or committed suicide. It’s not hidden, but a well constructed narrative that makes this sound silly protects it very well. An open mind is all that one needs. Much love.
A handful of major companies own the media.
Information is compartmentalised.
Silence is gained through money, threats/blackmail or killing/suiciding.
Check out the ‘Clinton body count’ and see how many of his close personal friends and bodyguards have died in light aircraft accidents or committed suicide. It’s not hidden, but a well constructed narrative that makes this sound silly protects it very well. An open mind is all that one needs. Much love.

if it were true this story could never break with corporate media. they all run their government's take on anything remotely like this.

Yes I think the hunter Biden laptop story has put pay to this "secrets can't be kept by humans" rubbish. Just a repeated fallacy that has no truth.
If the entire media industry can keep Philip Schofield's homosexuality secret for 30 odd years whilst he was appearing to live a straight, married life, they can hide something much more important to the public for at least as long.
It's a crude comparison, but one cannot deny the media is brutal. Remember them going after Keith Vaz so brutally whilst he was still married and an MP? How unfair was that on his family?
They can protect whoever and whatever they want to...
If the entire media industry can keep Philip Schofield's homosexuality secret for 30 odd years whilst he was appearing to live a straight, married life, they can hide something much more important to the public for at least as long.
It's a crude comparison, but one cannot deny the media is brutal. Remember them going after Keith Vaz so brutally whilst he was still married and an MP? How unfair was that on his family?
They can protect whoever and whatever they want to...

Spooks have protocols for this shit it usually means killing the researchers or holding something over them.

Well Fauci did admit after a 2 year stretch that now the likelihood of the virus is from a Lab
The wuhan lab was funded by the USA. It was carrying out gain of function research
The Vaccines have been the most profitable venture in human history
What is the reason of carrying out gain of function research?
The wuhan lab was funded by the USA. It was carrying out gain of function research
The Vaccines have been the most profitable venture in human history
What is the reason of carrying out gain of function research?

This explains a lot!
https://www.statnews.com/2020/03/31/covid-19-overcoming-testing-challenges/?fbclid=IwAR1ikMtfYusDqZ0Gmideh1d4C5fTMbSjvMuKlS1MpN0yf6ZGJq6ogaPXhUE
https://www.statnews.com/2020/03/31/covid-19-overcoming-testing-challenges/?fbclid=IwAR1ikMtfYusDqZ0Gmideh1d4C5fTMbSjvMuKlS1MpN0yf6ZGJq6ogaPXhUE

It would make sense for the Americans to start it off in china and overplay the number of deaths added to the fear and isolation and every person in the west is ready to boycott china or even war. Makes you think when all the countries suffering most deaths are usa, uk, italy, spain and france. They have never fought together before ?.. someone dies of a heart attack in the uk, do you think they will waste their very rare tests. Just write it as corona, Helps in multiple ways. Politicians are nuts. You never know! All I know is I only barely scraped through secondary school and I was saying shut down all flights from china to any country weeks before they even started reporting about what was happening in China on tv. It was all over twitter for months before. Just like trump said china cant hit the hong kong protesters and it was all over our tvs but macrons goons were beating the feck out of decent french people and our tvs showed nothing. Thank fuck we have weed in this crazy world


https://www.nature.com/news/engineered-bat-virus-stirs-debate-over-risky-research-1.18787
I’m sure it’s just a coincidence...
I’m sure it’s just a coincidence...

This spring would have had more protests than the 1960s. The Chinese government had a lot to lose with Hong Kong protests starting to spread to Guangdong province.
Is there anything they could keep them home as effectively as this?
Is there anything they could keep them home as effectively as this?

Undoubtedly the powers that be have concocted this virus to thin the herd of the weak and terrify the populace into obedience.

Of course. Why wouldn't US do this to Russia. Because they know that next day Russians will wave a tiny vial on TV saying they've cured it. And retaliate beyond repair.
Why not Iran? They have nothing to gain. But an economic 'war' with China. One has to make them look ugly and not appealing to deal with.
Same story is with so many African nations.
As a matter of fact, the italian man who was diagnosted with coronavirus walked out of a swiss hospital already. Cured. LOL.
Why not Iran? They have nothing to gain. But an economic 'war' with China. One has to make them look ugly and not appealing to deal with.
Same story is with so many African nations.
As a matter of fact, the italian man who was diagnosted with coronavirus walked out of a swiss hospital already. Cured. LOL.

You wouldn't put a virus like that out there to destroy another economy especially one where it effectives old people.

Sure, on Vulcan. But humans don't need able bodies people to die they only need to be scared. And that's what happened.
A virus with a bark bigger than it's bite is optimal for economic destruction and rather Trumpian if you ask me.
That said yeah of course this is just nature at work :)
A virus with a bark bigger than it's bite is optimal for economic destruction and rather Trumpian if you ask me.
That said yeah of course this is just nature at work :)

There’s a very interesting book written by Dean Koontz in 1981 The Eyes Of Darkness, that mentions a virus created in a lab just outside wuhan in labs called Wuhan-400, and he’s prediction is that it will affect humanity around 2020! Wether it’s genuine everyone can make up their own mind, interesting he mentions it though!

But yeah I can believe it was at least being developed or researched in a lab, and it got out. Maybe Russia were in on it too. After all they caused problems in Salisbury and they clearly don't adhere to international agreements. Germ / bacterial/ viral warfare on a global scale is the next best thing to nukes. At least the earth wouldn't be scorched -- but then the virus would kill the perpetrators too, so fuck knows.
Its a very clever and organically advanced virus too, affecting human lungs. I know "Mother Nature" is clever but ....this virus is quite advanced. Scary shit man.
But I never thought I would be so bored having to stay at home.
Aarrrgghhhh!!!!!!
Its a very clever and organically advanced virus too, affecting human lungs. I know "Mother Nature" is clever but ....this virus is quite advanced. Scary shit man.
But I never thought I would be so bored having to stay at home.
Aarrrgghhhh!!!!!!

the lamestream mediocres and corrupt WHO have been warning about a second wave. Now there are new cases springing up in Beijing.
Globally, the first wave is petering out, but the election is not until November.
Makes me wonder if we're being groomed for a second nonsensical lockdown. That history has already shown the first to be bullshit will I assume have no bearing if this is indeed what's coming down the pipe.
If there were some politically motivated opportunist mass gatherings orchestrated, then presumably the spread (of the second wave) could be pinned on these
Globally, the first wave is petering out, but the election is not until November.
Makes me wonder if we're being groomed for a second nonsensical lockdown. That history has already shown the first to be bullshit will I assume have no bearing if this is indeed what's coming down the pipe.
If there were some politically motivated opportunist mass gatherings orchestrated, then presumably the spread (of the second wave) could be pinned on these

Sooooo many NPC's on this thread. I hope you read through your old comments and cringe you gullible fucks.



It's 56min long but found it interesting as it was uploaded 12 years ago and he talks about a flu like virus released on China.

My opinion on matters like this are not worth 5p, but the timing of covid being in similar time frame to the UK leaving the EU does seem convenient. Seems like the East trying to destabilize the west. Im sure it would be in Chinas interest for the whole EU to collapse. Also UK and London being the financial capital and the UK suffering worse economical damage than any other EU country shortly after agreeing to leave the EU just seems incredible timing. Couldve randomly occured 6.4 years ago, but randomly occured shortly after the beginning of the EU starting to dissolve. And again nobody is disputing this virus came from china and its timing is so outrageously perfect as to is its target. Dont know anything, just smells a bit fishy.

Please stay safe people. This is really scary!! Would recommend flattenthecurve.com for some
Good advice.
Good advice.

I would like to think, that if I made a bio weapon it would a bit more potent than a sore throat and a cough

If you were to release it on the world, what other way would you make sure
a. It doesn't kill YOUR family
b. It doesn't kill off the whole workforce of the economy that actually make the priveleged class possible?
a. It doesn't kill YOUR family
b. It doesn't kill off the whole workforce of the economy that actually make the priveleged class possible?

The virus came from China, nobody is disputing that, China wouldn't hurt their own economy like that intentionally. Plenty of lies and shady dealings around covid but this ain't it chief.

some of the comments here are so cliche stoner, it makes me embarrassed to consider myself one.
we'll never know the truth and i'm not getting pointless angry until the facts are laid out and undeniable. these kind of coronaviruses exist in nature, and we know that governments also fuck around with experiments. that's all we know for a fact.
some of you sound like you believe 5G turns people into gay frogs. wait for the undeniable facts and in the meanwhile, smoke lots of weed but not so much that you believe anything you read on Facebook.
we'll never know the truth and i'm not getting pointless angry until the facts are laid out and undeniable. these kind of coronaviruses exist in nature, and we know that governments also fuck around with experiments. that's all we know for a fact.
some of you sound like you believe 5G turns people into gay frogs. wait for the undeniable facts and in the meanwhile, smoke lots of weed but not so much that you believe anything you read on Facebook.

depends... if djt is re-elected then yes. if Biden/democratx then no. democrats love chinas money. sell-out central.
china has been open about wanting to be the supreme world superpower. they pay-off everyone, in every facet.
national self-sufficiency is the base line. trade is the gravy. those are the foundations of stability. it's common sense.
bio-warfare is available as we've experienced. c19 is lab-derived corona rna with hiv sequences inserted and affinity enabled. if this was originally an accident then it was certainly weaponised. the good and the bad of biowar is that it is essentially nuclear-level as at today.
china has been open about wanting to be the supreme world superpower. they pay-off everyone, in every facet.
national self-sufficiency is the base line. trade is the gravy. those are the foundations of stability. it's common sense.
bio-warfare is available as we've experienced. c19 is lab-derived corona rna with hiv sequences inserted and affinity enabled. if this was originally an accident then it was certainly weaponised. the good and the bad of biowar is that it is essentially nuclear-level as at today.

1 post
+2 votes
Aubrey De Grey: Can We And Should We Give Ourselves Indefinite Youth? Oh Yes
I'll take the blue pill, plug me in already

Aubrey De Grey: Can We And Should We Give Ourselves Indefinite Youth? Oh Yes
"Most biomedical gerontologists now agree that we are approaching a time of sharply accelerated progress in extending healthy lifespan."

Because not everyone will have the money for it. The rich will use it and put a price on it to make it unavailable for us normal people. The rich will the feel superior after a drug like that and we all remember what happened in the world of star trek. The eugenics war is something that will unfortunately happen on this planet one day because of them sort of drugs. I must point out I'm not against this sort of thing as science is not good or evil it's how it's used but this sort of thing is are downfall.

Surely this is an issue but most innovations are available to the rich first. What would you think of a world without cars, air travel or computers? Let the rich be our guinea pigs.
That said yeah, downfall for sure.
That said yeah, downfall for sure.

Socialism makes sense or something to insure diversity because if we have douches getting thawed 1st they might not want to thaw the rest of us after.

2 posts
+12 votes
Ancient Aliens
I think its more likely that there was an ancient civilisation that was as advanced as us if not more so.
+ 2 more
I think its more likely that there was an ancient civilisation that was as advanced as us if not more so.

Its a good shout. I'm open to both sides being alien influenced and developing the skills ourselves...
If they had no outside influences maybe they were just differently advanced to us.. We have gone down the tech route but maybe they had something else..
Whatever that is (accessing or opening parts of the brain/consciousness etc etc) They were able to move, mold, drill and create huge structures 12,000 years plus ago... which still blows our minds troday!
If they had no outside influences maybe they were just differently advanced to us.. We have gone down the tech route but maybe they had something else..
Whatever that is (accessing or opening parts of the brain/consciousness etc etc) They were able to move, mold, drill and create huge structures 12,000 years plus ago... which still blows our minds troday!

The fact that we didn't even have the technology or understanding 100 years ago to measure some of the precision granite boxes in egypt to the degree of accuracy in which they were built thousands of years ago, just makes it even more laughable that we're still being sold this outdated story of history... but yeah copper chisels and slaves? absolute embarrassment that this is still being taught / believed
i believe the beings that left these structures and artifacts behind and the purpose behind them will always be outside our realm of comprehension
we like to think we're an advanced intelligent species but the reality is so far from that, 99% of the earths population is just unthinking egotistical monkeys gorping at smartphones looking for the next tyrant to ironically venerate! fucking failing species.
i believe the beings that left these structures and artifacts behind and the purpose behind them will always be outside our realm of comprehension
we like to think we're an advanced intelligent species but the reality is so far from that, 99% of the earths population is just unthinking egotistical monkeys gorping at smartphones looking for the next tyrant to ironically venerate! fucking failing species.

Read some of Graham Hancock’s work or furthermore listen to the book of Enoch (the watchers), it’s not for everyone but a fascinating listen all the same. I have also been looking at the Megalithic masonry it’s mind boggling, Puzzle!

Graham Hancock's books are amazing! There are some great vids on YouTube as well!.. Randall Carlson and Dr Robert Schoch are also worth a look as well.
Ancient Aliens has some good bits... and frustrating bits... but more of a fun watch than serious information.. lol.
Also, another good channel to watch on Youtube is Bright Insight: https://www.youtube.com/c/BrightInsight
Ancient Aliens has some good bits... and frustrating bits... but more of a fun watch than serious information.. lol.
Also, another good channel to watch on Youtube is Bright Insight: https://www.youtube.com/c/BrightInsight

I do have believe in ancient aliens especially in regards to The Pyramids construction.
I do like a bit of conspiracy too... lies buried in a library of History... Or His Story
I do like a bit of conspiracy too... lies buried in a library of History... Or His Story

The Pyramids are very cool!
How today are we still being taught that things like the Sphinx were built by Pharaoh Khufu.. The erosion alone is enough to show its far far older than this plus the fact there isn't one document or hieroglyph to confirm its.. All that comes from some graffiti of his name found on some walls...
But to be fair... I believe kids are still taught that Christopher Columbus Discovered America.lol haha
How today are we still being taught that things like the Sphinx were built by Pharaoh Khufu.. The erosion alone is enough to show its far far older than this plus the fact there isn't one document or hieroglyph to confirm its.. All that comes from some graffiti of his name found on some walls...
But to be fair... I believe kids are still taught that Christopher Columbus Discovered America.lol haha

There is a pod cast with Joe Rogan and Bob Lazar. Bob had mentioned that the craft he was working on was dug out of the ground. Speculating it had been buried for hundreds of thousands of years.
It was a very compelling pod cast.
It was a very compelling pod cast.

Early man has been around for over 3 million years. Homosapiens around 300,000 years. And yet the earliest academically accepted signs of structured society is around 9000 years. Calling BS there. I believe the reset button was hit on society during the Dryas period (series of meteors that caused cataclysmic events) around 13,000 years ago. If we want to find many of the old cities we would have to look under water.
As for what tech could move blocks of stone weighing 80 tons up a mountain, I believe the answer lies in acoustic levitation. Many of the stories passed down by tribes talk of noises akin to large trumpets lifting stones. It's believed the Tibetan monks still retain this ability. In my opinion N. Tesla had also discovered the secrets of acoustics.
Not even got to the aliens bits yet. Apologies if this reads garbled, I'm writing it with covid and trying to articulate many thoughts at once.
As for what tech could move blocks of stone weighing 80 tons up a mountain, I believe the answer lies in acoustic levitation. Many of the stories passed down by tribes talk of noises akin to large trumpets lifting stones. It's believed the Tibetan monks still retain this ability. In my opinion N. Tesla had also discovered the secrets of acoustics.
Not even got to the aliens bits yet. Apologies if this reads garbled, I'm writing it with covid and trying to articulate many thoughts at once.

Also I believe the Sahara has a lot of things waiting to be excavated as well as the oceans 👍

My view is to look up and watch “ ancient aliens debunked “
https://topdocumentaryfilms.com/ancient-aliens-debunked/
It makes great imaginative materials for people who don’t know any better.
That includes me by the way;)
https://topdocumentaryfilms.com/ancient-aliens-debunked/
It makes great imaginative materials for people who don’t know any better.
That includes me by the way;)

I really don't know. I've watched documentaries on the theory but haven't made my mind up. I love hearing about alternative views though so I'm going to try Joe Rogan's podcasts mentioned in the conversation. It's kind of fun presenting theories like that to people you know are staunch nonbelievers. I like the reactions you get. I guess I'm open minded about that kind of thing until I get a first hand experience that confirms or denies it.

I'm sure if I was some ancient alien leaving buildings on some other planet I'd be back to check on them. What's the reasoning for these aliens just leaving little hints around the place?
I think the simplest answer is most likely the truth, there wasn't any aliens. People built stuff that looks odd because people are odd.
I think the simplest answer is most likely the truth, there wasn't any aliens. People built stuff that looks odd because people are odd.

Ancient people didnt just build odd stuff, they built intricately designed structures with mathematical precision

This is what make me think there was never aliens but a previous global civilisation that were more technologically advanced than the history books tell us. The evidence they left behind is to real.

We aren’t devolving, that would mean our genome is going back in time;). We are just evolving to a less intelligent, less independent state of being;)

Maybe they were just really good at maths paired with having a real sense of pride and discipline in their work😂😂, our advancements have brought us technology but their advancements gave them skill and intellect , plenty of ancient Greek mathematicians, who's to say the Egyptians didn't do it better ? 😂
Merry Christmas 2023 all !!
Merry Christmas 2023 all !!

The evidence is everywhere. See the religious texts and reference to ships of light, fairy folklore Etc All the same phenomena but through different lenses in my opinion. Look for the books by Jacques Vallee. Unacknowledged on Netflix is worth a watch too.

You're taking text from 3000 years ago, and using that as your "evidence."
What about the bible, that must all be true too?
What about the bible, that must all be true too?

Agreed the bible is not something to take literally.lol. but we need to learn to read in between the lines. Try to put yourself back thousands of years ago.. how would we describe a flying saucer (if it happened) without knowing such things or materials existed... Giant bird in the sky? etc..
I'm not religious at all... but what i found interesting is most religions/cultures describe a great flood happening around the same time, which we now have physical evidence for.. So yes, we cannot rely on all the ancient text, but who knows.. some of it may have some interesting clues...
I believe something has had to have happened.. Either we have been given all this knowledge by an external source... or there were very advanced civilzations in a part of history that has been forgotten or hidden...
To put into perspective Gobekli Tepe is dated as far back as 12000 years ago yet people were only supposed to still be hunter gathers at this time.. (strange)
Also, Cleopatra was closer to the invention of the iphone than the building of that site..... Mad when you think about it.. so what we classify as ancient e.g. Romans etc. might not be as old as we think!!
The main problem is that non of us was there.lol. So I cant say for sure either way if it was Aliens or not... All I know is that its mystery and i love getting baked and watching vids on it. hahaha
I'm not religious at all... but what i found interesting is most religions/cultures describe a great flood happening around the same time, which we now have physical evidence for.. So yes, we cannot rely on all the ancient text, but who knows.. some of it may have some interesting clues...
I believe something has had to have happened.. Either we have been given all this knowledge by an external source... or there were very advanced civilzations in a part of history that has been forgotten or hidden...
To put into perspective Gobekli Tepe is dated as far back as 12000 years ago yet people were only supposed to still be hunter gathers at this time.. (strange)
Also, Cleopatra was closer to the invention of the iphone than the building of that site..... Mad when you think about it.. so what we classify as ancient e.g. Romans etc. might not be as old as we think!!
The main problem is that non of us was there.lol. So I cant say for sure either way if it was Aliens or not... All I know is that its mystery and i love getting baked and watching vids on it. hahaha

Okay perhaps the term ‘evidence’ is too strong when referring to old texts. just offering my opinion on this phenomena which may or may not be ‘aliens’.
Check out the recent videos released by the US Navy I.e. tic tac and Gimbal. Also the many reports with multiple credible witnesses.
Check out the recent videos released by the US Navy I.e. tic tac and Gimbal. Also the many reports with multiple credible witnesses.

Party pooper time, apologies in advance haha - there is no evidence for any ancient aliens or any ancient advanced/unknown civilisation. Not a single person with relevant qualifications believes so. Graham Hancock is a (really bad) journalist and snake oil salesman, real anthropology is more interesting than any of this fictional nonsense. Merry Christmas 😊.

Bah humbug lol 😉💚
To say Graham Hancock is snake oil salesman though is a bit over the top. IMO lol.. 😜
Is he right, who knows lol. But What’s wrong with talking about possible reasons for things that haven’t been figured out yet.. e.g. who made these things, how were they made and why? Especially when we have no idea ourselves how these certain things came to be..
Also, I think it’s healthy to have such discussions, instead of being told that’s the way things are and don’t ask questions.. when we actually have no idea..
Goblekli Tepe is a good start for evidence of a lost civilisation.. Before it was discovered and properly dated, we thought there were nothing but hunter gathers around at that time… We were told these people lived a very simple life with no means or evidence of being able to create such things.. yet here they are..
To say so confidently that there was no other ancient civilisation is an educated guess but… Who knows! Especially after discovering the major cataclysmic event 12000 odd years ago which flooded and destroyed a lot of the planet (for a long ass time!)
There are a number of places, structures and pottery which we would struggle to make today, even with the use of modern tech.., so there has to be something we are missing…
Also, to say we know everything already though just shows how arrogant the human race has become… Things change with time and new evidence comes to light over the years… so why not be open minded about things.. 🤷♂️
https://youtu.be/QzFMDS6dkWU?si=sI1f3Dce-0qR0aTm
If any one is interested I would recommend checking out uncharted x (link above to one of his vids) His channel has some great in depth looks at all these crazy stone/granite blocks and the insane precision or mind baffling moulding that went on.
To say Graham Hancock is snake oil salesman though is a bit over the top. IMO lol.. 😜
Is he right, who knows lol. But What’s wrong with talking about possible reasons for things that haven’t been figured out yet.. e.g. who made these things, how were they made and why? Especially when we have no idea ourselves how these certain things came to be..
Also, I think it’s healthy to have such discussions, instead of being told that’s the way things are and don’t ask questions.. when we actually have no idea..
Goblekli Tepe is a good start for evidence of a lost civilisation.. Before it was discovered and properly dated, we thought there were nothing but hunter gathers around at that time… We were told these people lived a very simple life with no means or evidence of being able to create such things.. yet here they are..
To say so confidently that there was no other ancient civilisation is an educated guess but… Who knows! Especially after discovering the major cataclysmic event 12000 odd years ago which flooded and destroyed a lot of the planet (for a long ass time!)
There are a number of places, structures and pottery which we would struggle to make today, even with the use of modern tech.., so there has to be something we are missing…
Also, to say we know everything already though just shows how arrogant the human race has become… Things change with time and new evidence comes to light over the years… so why not be open minded about things.. 🤷♂️
https://youtu.be/QzFMDS6dkWU?si=sI1f3Dce-0qR0aTm
If any one is interested I would recommend checking out uncharted x (link above to one of his vids) His channel has some great in depth looks at all these crazy stone/granite blocks and the insane precision or mind baffling moulding that went on.

It’s a fun discussion man, and a really cool idea. Believe me I’m a want to believer haha.
Göbekli Tepe is super interesting, but it is essentially just an arrangement of carved stones right? Aye the arrangement might be celestial in nature and it’s really cool, and there was a little bit of settlement, but that doesn’t scream advanced civilisation to me. These guys had a lot of time on their hands to watch the sky and learn how to work stone. What you’d want to see is cities, human remains, advanced tools and weapons. The same goes for the pyramids and stone henge, there are no real mysteries here I’m afraid. How these structures were built is pretty well understood other than a couple of relatively minor elements of the building process (like the upper ramp system for the great pyramid for example). For some reason people keep buying the ancient mystery ticket, and frauds like Hancock milk it. His catchphrase is “things keep getting older”, and he’s right, it’s super interesting. That’s where the hard facts end and the twisted ones begin. Check out the MANY debunking videos on the yootubes.
It might seem harmless but it undermines the actual science man, to me the truth is better than fiction. If this shit interests you, check out what’s going on with Homo Naledi atm, way cooler than any “what ifs?” Imo.
I’m a big JRE fan btw haha, I want to like these theories but I just can’t. I think it’s almost entirely woowoo.
Göbekli Tepe is super interesting, but it is essentially just an arrangement of carved stones right? Aye the arrangement might be celestial in nature and it’s really cool, and there was a little bit of settlement, but that doesn’t scream advanced civilisation to me. These guys had a lot of time on their hands to watch the sky and learn how to work stone. What you’d want to see is cities, human remains, advanced tools and weapons. The same goes for the pyramids and stone henge, there are no real mysteries here I’m afraid. How these structures were built is pretty well understood other than a couple of relatively minor elements of the building process (like the upper ramp system for the great pyramid for example). For some reason people keep buying the ancient mystery ticket, and frauds like Hancock milk it. His catchphrase is “things keep getting older”, and he’s right, it’s super interesting. That’s where the hard facts end and the twisted ones begin. Check out the MANY debunking videos on the yootubes.
It might seem harmless but it undermines the actual science man, to me the truth is better than fiction. If this shit interests you, check out what’s going on with Homo Naledi atm, way cooler than any “what ifs?” Imo.
I’m a big JRE fan btw haha, I want to like these theories but I just can’t. I think it’s almost entirely woowoo.


It is a fun discussion buddy and it’s nice to be able to chat about all theories and beliefs! No matter which side you fall on 🙂
That’s right Göbekli Tepe is made up of many stone megaliths weighing up to 50 tons and 16ft high! But this is just a small proportion of the site. LIDAR has discovered multiple much larger version surrounding it, which would be amazing to look at! And make it a giant site!! But sadly it’s not allowed to be excavated..
Some of these giant megaliths also have 3D like sculptures of animals protruding from them. The crazy thing is they aren’t stuck on.. rather carved from the actual megalith. Which in its self is a great feat of knowledge and skill! Especially with the tools available at the time and the very limited knowledge these hunter gathers had on stone masonry.. So who made and moved all these of many many stones?
Has the pyramid mystery been figured out? To be able to move (from far distances) and hoist 100 plus ton support blocks is crazy! Let alone the rest of the build lol. If a ramp was used it would have to of been miles n miles n miles nmiles long lol. Or the way they say the stone blocks were cut for example. That method has been tested and it took them days I think to just get X amount of millimetres deep!
I don’t think Egyptians said anything about them building them either. No writings or descriptions in any way have been found except some graffiti.. which I believe was found crudely etched into it the walls which had King Khufu s name.
Also it would of taken a crazy crazy amount of slaves.. but where are all the tools and waste etc that they would of left behind.. don’t think it’s been found…
There was never any kings or queens discovered there either (even though it’s called the kings chamber etc)
There are a few other mysteries in Egypt like the giant granite sarcophagus’s. They somehow managed to get them deep underground, make them perfectly smooth and symmetrical weighing tens of tons! Mind blowing.🤯
Or the granite or solid hard stone vases I linked in my last post. These have been tested in a lab using lasers to measure them and they are almost perfect in every way! Which at the time would of been impossible to do due to strength of the stone and the tools available wouldn’t of been able to be that accurate or smooth..
There are also giant statues etc where the feet alone are bigger than a human, or giant obelisks… or even potential machining marks!
Could keep going but I’m boring myself right now lol. Plus I find it hard to write long form after too much Christmas food n drink 😂
Thanks for posting those links 👍 will check them out as always open to new theories I’ve not discovered yet 👊💚
That’s right Göbekli Tepe is made up of many stone megaliths weighing up to 50 tons and 16ft high! But this is just a small proportion of the site. LIDAR has discovered multiple much larger version surrounding it, which would be amazing to look at! And make it a giant site!! But sadly it’s not allowed to be excavated..
Some of these giant megaliths also have 3D like sculptures of animals protruding from them. The crazy thing is they aren’t stuck on.. rather carved from the actual megalith. Which in its self is a great feat of knowledge and skill! Especially with the tools available at the time and the very limited knowledge these hunter gathers had on stone masonry.. So who made and moved all these of many many stones?
Has the pyramid mystery been figured out? To be able to move (from far distances) and hoist 100 plus ton support blocks is crazy! Let alone the rest of the build lol. If a ramp was used it would have to of been miles n miles n miles nmiles long lol. Or the way they say the stone blocks were cut for example. That method has been tested and it took them days I think to just get X amount of millimetres deep!
I don’t think Egyptians said anything about them building them either. No writings or descriptions in any way have been found except some graffiti.. which I believe was found crudely etched into it the walls which had King Khufu s name.
Also it would of taken a crazy crazy amount of slaves.. but where are all the tools and waste etc that they would of left behind.. don’t think it’s been found…
There was never any kings or queens discovered there either (even though it’s called the kings chamber etc)
There are a few other mysteries in Egypt like the giant granite sarcophagus’s. They somehow managed to get them deep underground, make them perfectly smooth and symmetrical weighing tens of tons! Mind blowing.🤯
Or the granite or solid hard stone vases I linked in my last post. These have been tested in a lab using lasers to measure them and they are almost perfect in every way! Which at the time would of been impossible to do due to strength of the stone and the tools available wouldn’t of been able to be that accurate or smooth..
There are also giant statues etc where the feet alone are bigger than a human, or giant obelisks… or even potential machining marks!
Could keep going but I’m boring myself right now lol. Plus I find it hard to write long form after too much Christmas food n drink 😂
Thanks for posting those links 👍 will check them out as always open to new theories I’ve not discovered yet 👊💚

Yo man, hope you had a good Christmas.
Yeah I share your enthusiasm for this stuff for sure, we clearly have a common interest and it’s cool that we can discuss it in a friendly way.
It’ll probably not shock you to find out that I’m not an archaeologist or a structural engineer haha. But, there are many videos etc made by archaeologists and structural engineers explaining exactly how the pyramids were built, it’s just that Hancock and Co conveniently ignore them. They’re out there for you to look at man, no mysteries (or very few). Same goes for the writings about the pyramids, I think there are quite a few and they (at least once) referred to the great pyramid as the “Horizon of Khufu”, which is pretty cool imo. Again, I’ve never heard Hancock and Co reference these examples.
On Gobekli Tepe, I did not mean to downplay its importance to real anthropology/archeology. It definitely pushes the envelope back a bit, and many real anthropologists think the envelope will be pushed back further. But we’re not talking about some truly breathtaking advances here. They could clearly work stone and clearly had a strong enough community for such a structure to be built or even wanted in the first place. It clearly had significance to them and was added to over centuries etc etc. None of this was expected given the age of the site, which is exciting. A semi nomadic group or groups of hunter gatherers could work stone pretty well and form core belief structures and shit, that’s cool af as it is! What more could be discovered at that site? What other sites are there out there? Genuinely exciting shit. But we don’t need Hancock and his fantastical ramblings in order to understand it all bro.
Who do you really trust? The completely unqualified journalist (sociology degree, close-ish but no cigar), who has written as much self proclaimed fiction as he has “non-fiction”, who completely misrepresents the evidence and directly ignores anything he doesn’t like. Or, the centuries old network of experts and educational institutions dedicated to the study of ancient civilisations, made up of thousands of free thinking individuals who’d all love to reveal the scoop of the century and rake in the big bucks?
Yeah I share your enthusiasm for this stuff for sure, we clearly have a common interest and it’s cool that we can discuss it in a friendly way.
It’ll probably not shock you to find out that I’m not an archaeologist or a structural engineer haha. But, there are many videos etc made by archaeologists and structural engineers explaining exactly how the pyramids were built, it’s just that Hancock and Co conveniently ignore them. They’re out there for you to look at man, no mysteries (or very few). Same goes for the writings about the pyramids, I think there are quite a few and they (at least once) referred to the great pyramid as the “Horizon of Khufu”, which is pretty cool imo. Again, I’ve never heard Hancock and Co reference these examples.
On Gobekli Tepe, I did not mean to downplay its importance to real anthropology/archeology. It definitely pushes the envelope back a bit, and many real anthropologists think the envelope will be pushed back further. But we’re not talking about some truly breathtaking advances here. They could clearly work stone and clearly had a strong enough community for such a structure to be built or even wanted in the first place. It clearly had significance to them and was added to over centuries etc etc. None of this was expected given the age of the site, which is exciting. A semi nomadic group or groups of hunter gatherers could work stone pretty well and form core belief structures and shit, that’s cool af as it is! What more could be discovered at that site? What other sites are there out there? Genuinely exciting shit. But we don’t need Hancock and his fantastical ramblings in order to understand it all bro.
Who do you really trust? The completely unqualified journalist (sociology degree, close-ish but no cigar), who has written as much self proclaimed fiction as he has “non-fiction”, who completely misrepresents the evidence and directly ignores anything he doesn’t like. Or, the centuries old network of experts and educational institutions dedicated to the study of ancient civilisations, made up of thousands of free thinking individuals who’d all love to reveal the scoop of the century and rake in the big bucks?

Yo dude. Had. A lovely one thanks hope you did too 💚
Any theory on how the pyramids were built are just that… a theory. We have nothing to go from except educated guesses. But these guesses still don’t explain how they raised 100 plus ton blocks as supporting megaliths, how they managed to get blocks or megaliths to join with not even a millimetre gap (which you can’t even fit a piece of paper in) or mould SOLID granite megaliths into curves, create vases so accurately symmetrical that the only way to do this now is using tech, those giant granite sarcophagus, etc etc etc..
With Gobekli tepe they are now having to re write history.. Before this discovery we thought hunter gathers had no idea how to do such things… but we still have no evidence they could.. The animal sculptures haven’t been properly explained, and saying oh, well, they must of been more advanced than we thought then.. still doesn’t explain anything..
Whether it’s aliens, lost cultures or something else… I have no idea…😂 but what we do know is there are mysteries out there that have not been solved! And there are gaps,, and just saying they could have just done it like this etc without testing such things is just a guess.
Would love to see modern people using only the tools provided back then create these things again.. (look how far they got with trying to cut the stone using old methods)
Also other mainstream geologist are coming out and saying that due to weathering a lot of these places are far older than we ever thought.. 🤯
I’m open to all ideas as non of it can be completely proved.. but to say we know confidently how all this is done IMO isn’t correct.
👊
Any theory on how the pyramids were built are just that… a theory. We have nothing to go from except educated guesses. But these guesses still don’t explain how they raised 100 plus ton blocks as supporting megaliths, how they managed to get blocks or megaliths to join with not even a millimetre gap (which you can’t even fit a piece of paper in) or mould SOLID granite megaliths into curves, create vases so accurately symmetrical that the only way to do this now is using tech, those giant granite sarcophagus, etc etc etc..
With Gobekli tepe they are now having to re write history.. Before this discovery we thought hunter gathers had no idea how to do such things… but we still have no evidence they could.. The animal sculptures haven’t been properly explained, and saying oh, well, they must of been more advanced than we thought then.. still doesn’t explain anything..
Whether it’s aliens, lost cultures or something else… I have no idea…😂 but what we do know is there are mysteries out there that have not been solved! And there are gaps,, and just saying they could have just done it like this etc without testing such things is just a guess.
Would love to see modern people using only the tools provided back then create these things again.. (look how far they got with trying to cut the stone using old methods)
Also other mainstream geologist are coming out and saying that due to weathering a lot of these places are far older than we ever thought.. 🤯
I’m open to all ideas as non of it can be completely proved.. but to say we know confidently how all this is done IMO isn’t correct.
👊

The majority of history is “just a theory”, man. The key is who is doing the theorising. Actual experts have solid “theories” on how these things were built with the tools available, it’s just that nobody wants to listen to them. They prefer mysterious fantasy. I don’t claim to know anything, other than there is literally zero evidence of a super advanced ancient civilisation, which doesn’t mean that there wasn’t one. But I’m also not claiming that the entire academic community is wrong, which is pretty much as arrogant as you can get.
Please check out that Stefan Milo video, I think you’d like it.
Please check out that Stefan Milo video, I think you’d like it.



Downvoted! Gutted haha. Believe me, I don’t like being the skeptic type guy. But it’s hard not to be when you start taking an interest in real life archeology/anthropology.
This is long but well worth a watch, Stefan Milo goes through each episode of Hancock’s Netflix show and explains why he’s wrong in a really nice, non-patronising way. You could watch it, but YouTube has a downvote button too so you could always just do that haha.
https://youtu.be/341Lv8JLLV4?si=o4Tkp5AUG8SD-32D
This is long but well worth a watch, Stefan Milo goes through each episode of Hancock’s Netflix show and explains why he’s wrong in a really nice, non-patronising way. You could watch it, but YouTube has a downvote button too so you could always just do that haha.
https://youtu.be/341Lv8JLLV4?si=o4Tkp5AUG8SD-32D

I love Stefan Milo, he's knowledgeable and also humble admitting where he might lack knowledge or is guessing

Infinite universe= infinite possibilities… can’t rule it out mate?
Also like SMorgan said likely we were way more advanced back then than the ‘take with a pinch of salt’txt books would like us to believe! All that knuckle dragging cave man crap🥸🤭
Also like SMorgan said likely we were way more advanced back then than the ‘take with a pinch of salt’txt books would like us to believe! All that knuckle dragging cave man crap🥸🤭

Any show that has 16 seasons must be true.
Not a true believer, but learned a lot from the show.
Not a true believer, but learned a lot from the show.

AA is craziness with a good amount of thought provoking articles such as the fucking fabulous stonework from the Stone Age.
Some of the presenters/ contributors are regarded as top comedians in our cave. David Childress to name one
Some of the presenters/ contributors are regarded as top comedians in our cave. David Childress to name one

Thought I'd add my own two cents into this.
I respect everyone's own view and opinions on the matter just wanted to make that clear.
I watched a debunk documentary by two men named Michael Hieser and Chis White and it truly blew my mind. It's extremely interesting, factual and I would recommend watching the whole thing. If anyone wants to watch it here's the link:
https://youtu.be/eeO3wm2y2zI
Hope every one is doing well in these trying times also!
I respect everyone's own view and opinions on the matter just wanted to make that clear.
I watched a debunk documentary by two men named Michael Hieser and Chis White and it truly blew my mind. It's extremely interesting, factual and I would recommend watching the whole thing. If anyone wants to watch it here's the link:
https://youtu.be/eeO3wm2y2zI
Hope every one is doing well in these trying times also!

It seems plausible with the stuff that they show on tv, although is that the stuff I was blazing making it out to be??

The evidence has been left all around the world. For what ever reasons it is not taught in schools. Why is that? Hmmmm...
Look at this for an example of evidence ....
https://m.facebook.com/story.php?story_fbid=2884299454934060&id=182073298490036
Look at this for an example of evidence ....
https://m.facebook.com/story.php?story_fbid=2884299454934060&id=182073298490036

Thats just some YouTube video showing some mayan stuff with some creepy music in the background...that is not evidence.

Aliens 👽 are real, here and present they have been around on planet earth for centuries although they haven’t disclosed themselves to the masses… they are beings with souls just like us… I met two white aliens in a lucid dream it was surreal. They said nothing but we’re friendly and made me tea 😂😂

As with aliens in general, it's not impossible and is most likely true but nobody has presented any good evidence so far

1 post
+10 votes
Steven Hawking Says We Have 100 Years Left
Ive done some math and i think i can get it down to 25.

Steven Hawking Says We Have 100 Years Left
War, global warming, AI backlash, add up the odds and Stevie says 100 years or bust.

He's just jealous. But potentially correct. There's a great book called 'Our Final Century' by Martin Rees (a respected academic, not a conspiracist of any sort) that makes a very cogent argument for the same outcome. Along the same lines. It's all quite believable. But then again, anyone could have written the same sort of book hundreds of years ago when things looked darker still... and here we are. Smoking weed. Writing to strangers. On the internet. Big up humans! We'll be alright! They're just might not be so many of us one day...

https://sgs.princeton.edu/00000000
Hundreds of years ago this was a fantasy. It's a miracle we're still alive.
Hundreds of years ago this was a fantasy. It's a miracle we're still alive.

the ocean is quite literally on fire so I'm fairly confident in saying global warming is here and not going anywhere but my money is on us destroying ourselves before it punches our ticket.
the more advanced humanity gets the more likely it be becomes we assure our own destruction. we've had a few near misses in regards to nuclear strikes already.
the most likely outcome at the moment is the US votes in another tyrant with a slightly higher iq than trump, starting the final war.
the more advanced humanity gets the more likely it be becomes we assure our own destruction. we've had a few near misses in regards to nuclear strikes already.
the most likely outcome at the moment is the US votes in another tyrant with a slightly higher iq than trump, starting the final war.

The article says we need to get the ball rolling in 100 years as shits going to get real anywhere from 1000-10,000 years. I can really only worry about the world my kids and grand kids are going to Inherit. They are going to have to figure it out from there. Plus the current world is anxiety inducing enough for the average person and I can only do so much so I’ll leave it to the egg heads to agree on the next steps to mitigate disaster that far in the future. Who does Hawking think he is anyway, Nostradamus? Now where’s my indica?

1 post
+4 votes

on
{cannabis}
Fibromyalgia and Back Pain
Carnivore diet and moderately intense weightlifting.
also fasting and cod liver oil + grassfed butter.

on
{cannabis}
Fibromyalgia and Back Pain
Hi Everyone. I was just wondering if anyone out there has more experience with this? I'm looking for something to help with Fibromyalgia and chronic back pain. Trying to avoid being moved onto morphine so any advice would be appreciated!

From my own experience I learned that it is essential to keep moving. I always hurt a lot more when I do not. It may seem weird but when I hurt a lot, I go for a walk or do something else very gentle. 9 out of 10 times it helps and I improve.

I was in the same position 3 years ago, with the help of cannabis I’ve removed all prescription medication as treatment. The main things for me are regular exercise building up slowly but always pushing your self. Meditation is also very useful. As clean a diet as possible ie No processed food. I use strong indicas in evening for pain and sleep and Sativa or hybrids in day time. The pain never truly goes away but for me cannabis helps far better than any prescribed drugs.

I have fibro and I was in the same boat
I now dont use anything other than natural pain relief. Get yourself some magnesium.chloride flakes for the bath.
You'll thank me later lol
Also the best pain relief ever naturally is pain slayer balm. As a fibro sufferer I know sleep can be awful to and they do sleepy balm which also helps
Hope you get some relief soon x
I now dont use anything other than natural pain relief. Get yourself some magnesium.chloride flakes for the bath.
You'll thank me later lol
Also the best pain relief ever naturally is pain slayer balm. As a fibro sufferer I know sleep can be awful to and they do sleepy balm which also helps
Hope you get some relief soon x

Also have l4.l5 slipped discs and several other issues so hope this gives you some hope x

Hello
Really sorry to hear about your situation. We're happy to send you some of our RSO for free for you to try out, to see if it alleviates and reduces your pain? It should also aid massively with your sleep too.
Our full spectrum RSO is very high quality and we're confident you will have a positive experience. We have patients that are currently using this for similar circumstances. Drop us a message if you have any questions.
Really sorry to hear about your situation. We're happy to send you some of our RSO for free for you to try out, to see if it alleviates and reduces your pain? It should also aid massively with your sleep too.
Our full spectrum RSO is very high quality and we're confident you will have a positive experience. We have patients that are currently using this for similar circumstances. Drop us a message if you have any questions.

Great gesture and I hope they take you up on it 👏👏👏👏 nice to see
@ Cptjck93 if you do keep us updated on how you get on as I’m sure the others in the thread would love to know based on personal experience
@ Cptjck93 if you do keep us updated on how you get on as I’m sure the others in the thread would love to know based on personal experience

Hi Cptjck93
Have tried tried full spectrum cannabis tenturture oil?
My missies has fibro and she says that it helped massively. This is an add on to the advice already given.
Have tried tried full spectrum cannabis tenturture oil?
My missies has fibro and she says that it helped massively. This is an add on to the advice already given.

As dazzler says a nice tincture does well!
Think JJ (Dr Greenthumb) has a 1-1 oil which would do the trick!
I treat people at work with CBD (full spectrum) for things such as fibro and see some great results! so a bit more THC in there as well should be perfecto👍 👌
✌️💚
Think JJ (Dr Greenthumb) has a 1-1 oil which would do the trick!
I treat people at work with CBD (full spectrum) for things such as fibro and see some great results! so a bit more THC in there as well should be perfecto👍 👌
✌️💚

Carnivore diet and moderately intense weightlifting.
also fasting and cod liver oil + grassfed butter.
also fasting and cod liver oil + grassfed butter.

Jordan Peterson mentions meat only based diet something that his daughter was working on cause of problems with inflamation/arthritis I’ve I remember correctly
He’s was on joe rogan talking about it
He’s was on joe rogan talking about it

I feel u man, my brother has fibro and sleeps for like 20 hours at a time. Hes on low doses of lyrica and b12 injections which seem to help atleast a little! Best of luck to u ?

Hey there, I know your pain sincerely. Here’s my story:
2013: I’m 21stone heavy ass mofo that train down the gym 2hours a night 5 days a week. I was a big big fuka! May bank holiday roles in & I’m down with serious chest infection, I’m asthmatic if you are too you know how severe a chest infection can take you down. Week 3 into the infection I have a monumental coughing fit in which all of my lower back ruptured. Apparently I’d coughed so so violently the pressure blew all my lower discs out in my back! I’m bed ridden for 18 months amped up on prescription meds, I won’t list them as I am on 13 different medications because of it. Many many heavy dosage of multiple morphines, nerve agents, anti spasms, anti depressants, multiple sclerosis meds to name a few. I had 2 severely intrusive surgeries to try and fix it
6 months into recovery I come off my bike and break my coccyx, which sets back recovery 7months.
Thought all was well 2 years later, I’ve sort of made a 65-70% recovery and struggling like mad but I’m still on all the same mountain of meds.
2016 rolled up & back starts to play up & deteriorating, I have all the tests again & my lower back has naturally blown out again due to it being highly weakened. I have to go for further more intrusive surgeries to try to fix it. At the same time I’m told that my mom has fibromyalgia & that her form of it (whatever that is?) has been passed onto me hereditary. Great!
My back feels worse than either time it was blown out but I ain’t been back to the specialist cus all they will give is 2 options: 1-fuse half of my spine! Hmm don’t like the sound of that! 2- carry on as is!
So believe me that I know what you may be going through, this is only half of the story cus it’s too long to go in on in one post.
My point is through all this turmoil that I call my life and having to take 12-15 pills 3 times a day, I’m now trying cannabis medication properly to help deal with and combat all of my symptoms. I’ve smoked cannabis for 25+ years but only recreationally now I use it medically in an attempt to try and ween me down from the current dosages from 15 pills down to 10 now so progress is being made and I am seeing so many more benefits to my life now I’m dosing the weed throughout the day. I have a long long long road ahead to get all my prescription meds down as my body physically needs em to even function cus the addiction is now a dependency.
I am heading in a positive direction for the first time over the last few months, and all down to a plant that is on this earth to be used for our needs, and is banned cus some old wrinkly farts are stuck in their 1950 mentality and fear what they do not understand.
I can go more into this and have thought about writing a series of blogs to inform of my events and my findings during a life altering 8 years. I have found that using a strong indica partnered with a strong sativa with some hash or crumble/ shatter added into the joint. This joint combo I’ve found through trial and error to be the best formula for my medical needs. I had also recently started to use a dab rig for all of these lovely new concentrates and wow they help like mad too.
Hope this helps and sorry if it went on too long but this is part of why I am on here now ; )
2013: I’m 21stone heavy ass mofo that train down the gym 2hours a night 5 days a week. I was a big big fuka! May bank holiday roles in & I’m down with serious chest infection, I’m asthmatic if you are too you know how severe a chest infection can take you down. Week 3 into the infection I have a monumental coughing fit in which all of my lower back ruptured. Apparently I’d coughed so so violently the pressure blew all my lower discs out in my back! I’m bed ridden for 18 months amped up on prescription meds, I won’t list them as I am on 13 different medications because of it. Many many heavy dosage of multiple morphines, nerve agents, anti spasms, anti depressants, multiple sclerosis meds to name a few. I had 2 severely intrusive surgeries to try and fix it
6 months into recovery I come off my bike and break my coccyx, which sets back recovery 7months.
Thought all was well 2 years later, I’ve sort of made a 65-70% recovery and struggling like mad but I’m still on all the same mountain of meds.
2016 rolled up & back starts to play up & deteriorating, I have all the tests again & my lower back has naturally blown out again due to it being highly weakened. I have to go for further more intrusive surgeries to try to fix it. At the same time I’m told that my mom has fibromyalgia & that her form of it (whatever that is?) has been passed onto me hereditary. Great!
My back feels worse than either time it was blown out but I ain’t been back to the specialist cus all they will give is 2 options: 1-fuse half of my spine! Hmm don’t like the sound of that! 2- carry on as is!
So believe me that I know what you may be going through, this is only half of the story cus it’s too long to go in on in one post.
My point is through all this turmoil that I call my life and having to take 12-15 pills 3 times a day, I’m now trying cannabis medication properly to help deal with and combat all of my symptoms. I’ve smoked cannabis for 25+ years but only recreationally now I use it medically in an attempt to try and ween me down from the current dosages from 15 pills down to 10 now so progress is being made and I am seeing so many more benefits to my life now I’m dosing the weed throughout the day. I have a long long long road ahead to get all my prescription meds down as my body physically needs em to even function cus the addiction is now a dependency.
I am heading in a positive direction for the first time over the last few months, and all down to a plant that is on this earth to be used for our needs, and is banned cus some old wrinkly farts are stuck in their 1950 mentality and fear what they do not understand.
I can go more into this and have thought about writing a series of blogs to inform of my events and my findings during a life altering 8 years. I have found that using a strong indica partnered with a strong sativa with some hash or crumble/ shatter added into the joint. This joint combo I’ve found through trial and error to be the best formula for my medical needs. I had also recently started to use a dab rig for all of these lovely new concentrates and wow they help like mad too.
Hope this helps and sorry if it went on too long but this is part of why I am on here now ; )

RSO would work if it was indica based something thats got indica that would help with pain sativas are more for depression so you would probably need a high indica ratio

Yes both of those can be effectively treated with THC & CBD bud. If in UK, go for medical - MC. Private, legal since 2018, clinics abound on the web, informational subs on Reddit. Treat pain, Fibro, ADHD ++ a wide range of issues.
Do the research carefully, money has to be spent too.
Bud is variable (same here too!) as are the clinics, but a script means no hassle, can even travel with it!
Do the research carefully, money has to be spent too.
Bud is variable (same here too!) as are the clinics, but a script means no hassle, can even travel with it!

RSO, or Rick Simpson Oil, is a concentrated cannabis oil that has been shown to provide relief for various conditions, including fibromyalgia and back pain. RSO is high in THC, which is the psychoactive component of cannabis that is known to provide pain relief, as well as other therapeutic benefits.
When using RSO for fibromyalgia and back pain, it's important to start with a low dosage and gradually increase it until you find the amount that works best for you. RSO can be taken orally or applied topically, depending on your preference and the type of pain you're experiencing.
It's important to note that while RSO may provide relief for some individuals, it may not be effective for everyone
When using RSO for fibromyalgia and back pain, it's important to start with a low dosage and gradually increase it until you find the amount that works best for you. RSO can be taken orally or applied topically, depending on your preference and the type of pain you're experiencing.
It's important to note that while RSO may provide relief for some individuals, it may not be effective for everyone

2 posts
+5 votes

on
{cannabis}
Cannabis Commercialization is Scary (TED)
Dont worry mate, the schemers wont prosper, soon as its legal everyone will grow their own.
+ 2 more

on
{cannabis}
Cannabis Commercialization is Scary (TED)


This guy is an eye opener, his point is that once cannabis is legal the social justiice issues change radically.

Half of the stuff this guy say's is simply not true. THC is a medicinal part of the plant, research shows THC works in harmony with CBD (Rick Simpson Oil anybody?).
And was Indian Charas 1% THC in the 60's? Like fuck it was.
It's way more likely the governments want to breed the THC out of the plant so it looses it's magical properties to Human Beings.
This dude probably had a major whitey after toking on a zoot at college and is now on a mission to spout some bullshit about THC being a bad thing.
And was Indian Charas 1% THC in the 60's? Like fuck it was.
It's way more likely the governments want to breed the THC out of the plant so it looses it's magical properties to Human Beings.
This dude probably had a major whitey after toking on a zoot at college and is now on a mission to spout some bullshit about THC being a bad thing.

Yeah corporations are evil and they are going to wind up pushing cannabis to where it becomes a negative in society, its the American Way.

corporations arent evil so much as they are amoral. they are a lot like AI, an early version of collective intelligence.


Can you imagine an ai sending us all cannabis while it optimizes it's algos, that's scary.

Dont worry mate, the schemers wont prosper, soon as its legal everyone will grow their own.

1 post
+3 votes

on
Aabuyer
Smoking and working out
Weight lifting sure, wouldent recommend smoking before cardio.

on
Aabuyer
Smoking and working out
Did this on some SS haze and had the best workout since lockdown. 3 week lockdown extension so what’s stopping you giving it a go

https://youtu.be/vUsv4Lb7EQs
Thats me
I smoke two joints before i smoke two joints and then i smoke two more!
Thats me
I smoke two joints before i smoke two joints and then i smoke two more!

Everywhere i go ive got people dropping out, passing up by throwing the towel in..i even turn my grey regularly from smoking so much
Everyday since 2000 maybe earlier...unfortunately i started too early 12/13
Infact ive smoked with people and turned them sober cause it was too much for them Hahaha just not as serious as some of us here
Everyday since 2000 maybe earlier...unfortunately i started too early 12/13
Infact ive smoked with people and turned them sober cause it was too much for them Hahaha just not as serious as some of us here

lol! I often pride myself on telling my friends about the time I once made a rasta whitey. He couldn't handle the G13 I got in the dam from a 2 week trip lol

Haze would would be perfect to...some smoke makes me wana starfish on flat surface
Haze im usually up all night
Haze im usually up all night

I do this all the time. I find it brilliant for those moves you need to concentrate on esp. abdominals. Your pace is more methodical and it just seems to make a workout for effective. I am normally fucked afterwards but it's all irie my friend!

I smoke before every workout. Really beneficial apart from giving me slight anxiety in the gym occasionally lol.
If building muscle is your goal I’d recommend it. Smoking really helps with mind-muscle connection, which is a really important factor along with proper form in making sure you’re working the muscle correctly to get those gainz
If building muscle is your goal I’d recommend it. Smoking really helps with mind-muscle connection, which is a really important factor along with proper form in making sure you’re working the muscle correctly to get those gainz

I love to smoke a bit of hash and go for a run. I run 4 times a week anyways so no biggy, really enjoy running while high though :)

The first thing i'm absolutely craving after lifting weights isn't your typical gym bro 'protein' or some heavily marketed unhealthy post workout chemicals
all i'm reaching for is my gear to skin up, although my dexterity isn't quite there right after a workout especially when i end the session on biceps / forearms, rolling a joint right afterwards is more challenging than the workout itself lol
all i'm reaching for is my gear to skin up, although my dexterity isn't quite there right after a workout especially when i end the session on biceps / forearms, rolling a joint right afterwards is more challenging than the workout itself lol

Hazes and Amnesias rock for weight training and medium cardio (hill walking). Plus banging reggae and hip hop for the gym. Yes!

1 post
+3 votes
What is the best video game plot you have experienced?
Anything from the dragon quest series, elder scrolls oblivion. Dragon age origins.

What is the best video game plot you have experienced?
For me personally its between Bioshock infinte and the last of us.
GTA 4 is up there along with uncharted 4, Halo 1-3, Papers please and God of war 1-4.
GC
X
GTA 4 is up there along with uncharted 4, Halo 1-3, Papers please and God of war 1-4.
GC
X

Shenmue on the Sega Dreamcast, written directed and produced by Japanese genius Yu Suzuki. Beautiful and way ahead of it's time.
A teenth of Afghan black, Ericsson T18 on silent, while i roamed the streets of Japan. Those were the days!
A teenth of Afghan black, Ericsson T18 on silent, while i roamed the streets of Japan. Those were the days!

Have you played the new Shenmue? Shenmue 3 I think? I played a load of the original on Dreamcast back in the day and bought the remastered version for PS4 that had 1&2 on it (wasn't as good as I remembered) intresting to know if 3 is any good.

Old School- I used to love the original Silent Hill on Playstation, thought that was a really clever game. Also MYST.

Silent hill for sure, was Syked for new one coming out with Kojima onboard but alas, it wasn’t to be

Loads of rumors about a reboot for the series but I'm not sure I even want it if Yamaoka isn't onboard. Kojima's take would've been interesting, though. Shame we never got more than a demo.

I assume this is an old post but if you haven’t already check out The Callisto Protocol!!! From the creators of dead space, looks like top tier sci fi horror and is set for release at the end of 2022 (although will probably be delayed until next year, you know how these things go lol)


Bloody loved Silent Hill. Creepy AF. Used the machine's limitations really well by clouding the streets with an eerie fog. I still recall hearing the footsteps of those fucked-up things but not be able to see them. Remember the cut-away sequence when the nurse staggered towards you?

100% the witcher. Managed to get every gwent card aswell even when you could very easily miss a few card through wrong decisions.


Wow! I totally forgot about LSL. I bloody loved all the Sierra adventure games when I was but a young lad.

For me Heavy Rain really stands out, also Shenmue 2 and LA Noir, all so far ahead of their time.

Yeah, it's amazing. So atmospheric. Only problem was, it was supposed to be a two or three part dlc but the creator gave up on it after the first one so it never got finished. As far as I know he gave up on making video games after that. If you can get hold of the first part tho, I'd highly recommend it

There are so many...
Witcher 3 has to be up there with the best along with all 3 bioshock games. Halo 1-3 & the latest god of war. Here hoping cyberpunk 2077 can join them too!
Witcher 3 has to be up there with the best along with all 3 bioshock games. Halo 1-3 & the latest god of war. Here hoping cyberpunk 2077 can join them too!

Metal Gear Solid on the PSone blew my mind, the other MGS got a bit preachy but the PSone version had everything, great game play, great stelf sections, good action sequences etc etc I still think about the bit where Psycho Mantis moves your controller, freaked me out.

GTA 4, more recently Red Dead Redemption 2 and The Last of us was also pretty epic, I’m looking forward to part 2.

Bioshock 1 was drippingly beautiful and draws you in. Dark room, good thumping surround sound cranked up, roll a few fattys. Great replay capability with the good or bad decisions and the array of different weapons and potions. One of the finest pieces of electronic entertainment to this day, including films.
Noteables: Deus ex, last of us, elder scrolls,Halo 1.
Its when you play them as well i think. There are more advanced games now, better ai, graphics etc, but such a wow factor for me at the time when i was a fanatic.
Noteables: Deus ex, last of us, elder scrolls,Halo 1.
Its when you play them as well i think. There are more advanced games now, better ai, graphics etc, but such a wow factor for me at the time when i was a fanatic.

Metro Exodus is pretty intense. I agree, Bioshock Infinite was pretty awesome. Saying that Bioshock 1+2 were pretty raw. Best plot ever, though? Has to be 'The Secret of Monkey Island 2'.

Like many others, 'last of us' will always stay in the mind and I'm eager to play no2.
So many others worthy of note, but I'm also big fan of Horizon on ps4, such an excellent story and characters and possibly my fave of this gen.
Honorable shout out to 'Days Gone' which never got the praise it deserved imo.
So many others worthy of note, but I'm also big fan of Horizon on ps4, such an excellent story and characters and possibly my fave of this gen.
Honorable shout out to 'Days Gone' which never got the praise it deserved imo.

I started playing “Days gone” when it came out on free to play. I would’ve paid for it if I’d have known it was that good! I’m hooked and I never thought I would be.

Max Payne 2: Fall of Max Payne - I like that noiresque atmosphere, the music, the over the top melancholic atmosphere... It harmonised well with my mood back then...

This^ elder scrolls by far the most immersive games. Skyrim is over 10 years old and is still un matched, probably never will be. Well over 100 hours game play or unlimited hours if you don't bother with main quest lines.

Life Is Strange
It really shows how the slightest thing can completely change the reality you get stuck in
It makes you contemplate the cause and effect that lead to living in your current reality and how fragile everything we perceive is
Ain't played the game in years but I still fell so emotionally connected to it
It really shows how the slightest thing can completely change the reality you get stuck in
It makes you contemplate the cause and effect that lead to living in your current reality and how fragile everything we perceive is
Ain't played the game in years but I still fell so emotionally connected to it

Xenoblade Chronicles for me. I love good RPGs and this story was kinda unique and on top of that the Gameplay was really fun too. Sadly the follow up Games were kinda meh...

Got to be final fantasy 9 I remember playing it as a 10 yr old and was super emotional lol

The last of us, for sure. What an emotional journey. Really looking forward to the next one coming out. Can’t wait to dive into that. Really nice to have summat to look forward to in these trying times. Much love.

Metal Gear Solid Series was excellent. Loved God of wars. First Bioshock was awesome. Assassins creed Odyssey was decent enough!

It got shit on constantly but I fucking LOVED Destiny 1 and 2. The story was meh, but the game itself ran so smoothly and in my opinion was one of the best FPS games to come out in years. I did stop playing a few months back though because I just had nothing left to do in it.
Story wise either Last of Us or God of War 5.
Story wise either Last of Us or God of War 5.

D1 and d2 played well but they would, its a bungie shooter. But they felt hollow which is a shame considering the hipe before 1. The lore is really good tho if you can peice it together. But it should be in the game more. D1 tied me over quite nicely between borderlands 2 and 3 lol and I met some awesome people playing it

Literally just bought Shadowkeep like a week ago. Got my Titan to 965 so far. Now for the Warlock and Hunter lol. Forgot how much I enjoyed playing the game

My favourite has got to be
Nier Automata
If you haven't played it I strongly suggest you do
So many twists and turns
The robot characters are named around famous philosophyers
The game touches on robots having emotions etc etc
Fucking fantastic honestly
Nier Automata
If you haven't played it I strongly suggest you do
So many twists and turns
The robot characters are named around famous philosophyers
The game touches on robots having emotions etc etc
Fucking fantastic honestly

Myst - never attempt it stoned!
Bioshock (obvs) but also Bioshock Infinite.
And Wolfenstein: The New Order.
Oh, and Ghouls'n'Ghosts....
Bioshock (obvs) but also Bioshock Infinite.
And Wolfenstein: The New Order.
Oh, and Ghouls'n'Ghosts....


I got hooked on the Sierra adventure games back in the early 90's. That led me on to the epic Broken Sword series by Revolution. Still worth checking out for its humour and storyline. Point and click has never been such fun.

1 post
+2 votes

on
{cannabis}
Roach vs Filter. What you using?
Roach and tightly pack the bottom which acts as a filter its self.
Cotton filters should be illegal as you are basically smoking cotton as the hot sm…

on
{cannabis}
Roach vs Filter. What you using?
Hey LB
Just wondering what your using for Roach?
Love the adaptability of Roach to fit a cone etc. But, my lungs cant take the punishment so work with Rolls69 filters now. Also adaptable air flow by advancement and retraction to cool things.
What you fellow enthusiasts using?? Just a general community question....
Ez Bigaz
BH
Just wondering what your using for Roach?
Love the adaptability of Roach to fit a cone etc. But, my lungs cant take the punishment so work with Rolls69 filters now. Also adaptable air flow by advancement and retraction to cool things.
What you fellow enthusiasts using?? Just a general community question....
Ez Bigaz
BH

i cant resist gving some skins trivia lol, Did YoU KnOW..? RAW and elements and juicy jays are all the same guys company, theres a great video on the history of RAW papers by J the owner/founder, makes you appreciate a guy who has a total passion for the best rolling papers he could possibly make, using 70 yo artisans to do the watermark on RAW papers. getting them made at the oldest rolling paper factory in the world in alcoy i think.

Didn't know this but delighted because I started using Raw Connisseurs (I think thats how you spell it?) about 2 years ago and now I hate rolling with anything else.
The 32 leaf pack comes with 32 perfect sized roaches and they just so the job perfectly in my opinion. Thanks for the trivia mate!
The 32 leaf pack comes with 32 perfect sized roaches and they just so the job perfectly in my opinion. Thanks for the trivia mate!

I find the raw skins dont really roll to a cone, they kinda fold into a cone, end up with a strange 20 sided shape joint lol, but i like a loose pack and a fast burn! So probably not an ideal skin for my rolling style, Zig zag blues or OCB hemps all the way!
FYI when i smoke blues, i fold, lick and tear about 6mm strip off the bottom of the skin, then roll. Ends up basicaly 1 papers thick all around the cone but the roach end, a nicer, less paperier smoke!
Anyone ever find smoking silvers that the paper burns to fast for the cherry, and you end up sucking half air half smoke through the roach, feels like you loosing half your joint? Just me maybe lol
(I can roll joints honest! 20years experience lol, i just like em loosey goosey)
FYI when i smoke blues, i fold, lick and tear about 6mm strip off the bottom of the skin, then roll. Ends up basicaly 1 papers thick all around the cone but the roach end, a nicer, less paperier smoke!
Anyone ever find smoking silvers that the paper burns to fast for the cherry, and you end up sucking half air half smoke through the roach, feels like you loosing half your joint? Just me maybe lol
(I can roll joints honest! 20years experience lol, i just like em loosey goosey)

Running a moist tongue along the edge over from the gummy allows the gummy strip to be torn off. The ragged edge can be bonded to the rolled J and one may enjoy a gum free puff.

Roach and tightly pack the bottom which acts as a filter its self.
Cotton filters should be illegal as you are basically smoking cotton as the hot smoke oxidises it.
On a side not ive recently switched to a small glass water pipe and my lungs have never been better, fuck all this paper man.
Cotton filters should be illegal as you are basically smoking cotton as the hot smoke oxidises it.
On a side not ive recently switched to a small glass water pipe and my lungs have never been better, fuck all this paper man.

Interested in trying out a small glass pipe aint you recommend mate wouldn't mind fucking tobacco off finally and same goes for smoking papers

Charcoal actitube slim filters, so much lighter on lungs, much tastier and hits you the same as normal joint.

I’ve been using those and purize which are similar.
Even the slimmest are fairly thick but they do make the smoke cleaner and tastier and I don’t feel like my lungs are going to collapse the next day!
Even the slimmest are fairly thick but they do make the smoke cleaner and tastier and I don’t feel like my lungs are going to collapse the next day!

Raw roach, I find filters take something away from the smoke.
What papers are you using mate?
What papers are you using mate?

yes but when im done and look at what they took out i'm not thinking that's shit i can't miss out on. as i finally have weed abundance (thanks biggas) i'm not thinking fuck i better make this last like i used to.

Use a variety. Rizla Micron or unbleached(real nice).
Currently using Cannaseurs extra long/ extra slim which have the +/-.
Next to try I have Raw Black
BH
Currently using Cannaseurs extra long/ extra slim which have the +/-.
Next to try I have Raw Black
BH


The best papers you could use, when you burn a paper on its own theres nothing left. I buy a 50 box at a time :)

Hi there, I’m currently using raw roach, someone was nice enough to buy me a shop box last Christmas and I’m still getting through them. I’m also a big fan of Quintessential hemp coated tips, I really like the booklets they make.
I have tried filterd joints out of curiosity but didn’t really enjoy it.
Raw are my go to paper, I like that it now that they so easily available in most UK news agents, definitely a step up from the blue rizla.
I have tried filterd joints out of curiosity but didn’t really enjoy it.
Raw are my go to paper, I like that it now that they so easily available in most UK news agents, definitely a step up from the blue rizla.

Oh yeah, it’s the way forward. These elements papers look nice, will have to give those a try.

For me I suggest forget any joint everyone should have a roor bong it's the only way to smoke! and much better on your lungs ,I personally ain't smoked a j for years, I remember going in the ganja museum and had picture of the human body and it said most healthy way to smoke weed is in a water pipe i.e BONG! Plus a good cherp sorts out the men from the boys! If you wanna invest in a smoking equipment forget vapes spend 300 quid on a proper bong

Deffo a cardboard roach for me, size appropriate to the chunkyness of mix ur putting in, i personally don't like my buds ground up to dust like it still chunky as a find when u get a good blast of a little bud you don't half know abt it, each to there own though

not sure what people mean by filter (an actual filter on a joint? never heard of it)... what I got used to do and find it difficult to do NOT do now is to use the tip of the cigarette (1cm max) as filter itself. He smokes lighter than a roach (smoother on your throat), but it taste better (get oily and if you the last puff is as good as the first)...

Raw roach or splinter Z vape for me bro. Couldn't justify using a filter that would be filtering my THC. You'll lose around 5-10% using those.

usually vape bro, but for blunts I use same shit :D only downside is price lol 10 quid for a pack.

I prefer the raw extra wide tips. I see you gave up tobacco. I was never a cigarette smoker and don't particularly like tobacco. I use a Real leaf herbal mix. Some of my friends can't stand it but I find it's not harsh on the throat like tobacco if you're a non-smoker. Each to their own I guess. Vaporise as well but it's hard to beat tight joint and I enjoy the process of skinning one up

lol same stuff with real leaf :D it's smells nice form the pack or when you smoke it yourself, but when my gf smokes it smells like burning plastic

I've used menthol filters when smoking for a long while. Back in the days I used a roach but that's too harsh for me as I'm getting on a bit. (Oh dear poor little me ha ha). I quite enjoy a J with menthol filters. BUT I hear menthol filters are being outlawed in England?? To stop younger people. Is that true or have I been told a fib?

No mate, only banning flavoured tobacco. Papers and filters are ok but can't be sold with tobacco included. A bit strange mind using them in spliffs haha but each to their own :).

I just throw in a roach of whatever is at hand (usually the skin packet) or the pre-cut stuff you get with skins

1 post
+3 votes
I get stoned to see reality not escape it
Has your fam ever tried cannabis?

I get stoned to see reality not escape it
My fam will say I am escaping "reality" yet as soon as I am stoned I see what so much of their idea of reality is. LOTS OF LITTLE SHIT elevated to the hysteria of survival.
Yeah look at me escaping reality by thinking about the universe I am sitting in instead of standing in line to buy something I saw on TV.
Yeah look at me escaping reality by thinking about the universe I am sitting in instead of standing in line to buy something I saw on TV.

That is the escape, it opens your mind to the bigger picture, you can see who should or shouldn't be in your close circle, you can see what matters easier
I don't get high to escape I get high to open my mind
I don't get high to escape I get high to open my mind

i get almost religious when i think about this but then i remember there are opiate receptors as well.

Yes, psychedelics to expand my perspective, of course!
But I use cannabis to better accept the shit that is pushed on me from all sides since the day I was born. Cannabis just has that power to really upgrade my life in this sense. I guess Id use less of it I there was less stress and city idiotism in my life.
But I use cannabis to better accept the shit that is pushed on me from all sides since the day I was born. Cannabis just has that power to really upgrade my life in this sense. I guess Id use less of it I there was less stress and city idiotism in my life.

that's a cool way of putting it and i wonder maybe a definition of what it means to be conscious? intelligent beings will always expand their reality.

Then I probably wouldn't use the tern 'stoned' to describe this condition. It sounds more like you are elevated

1 post
+1 votes
Isn't "Indiana" Jones a Girl's Name?
Aren't all names just crazy mouth sounds

Isn't "Indiana" Jones a Girl's Name?

It ends in A and look at "Indy" it rhymes with Cindy, Mindy and zero boys names!

It’s like Jody or Jodie, although I do know a bloke called Stacey. Is it spelt differently? Maybe I should have googled before I started writing this...

3 posts
+4 votes

on
jpa6919
How to reach psychedelic heights with edibles?
It cleans out the receptors, also has anti-addction properties.
I agree its not an enjoyable experience.
+ 3 more

on
jpa6919
How to reach psychedelic heights with edibles?
Hi guys,
So I was previously a pretty heavy smoker to the point where I never really felt satisfied by a high. Nothing really gave me the same sense of zoned out bliss I used to get when lighting up. Now I haven't smoked in almost a month, but I've taken edibles a few times instead. On Friday and Saturday I took fairly large doses (200MG on Friday and 300MG in two sittings on Saturday).
Whilst I got a very pleasant high from both doses, I still felt more clear-headed than I wanted to. Like, 300MG is a lot for edibles right? Even for experienced smokers? I did take the two 150MG doses a few hours apart, which I'm sure had an impact. Would you have advised taking it all in one go to really land on another planet? Lots of people suggested being careful and upping my initial amount slowly, so I did. But I can't really afford any more for the time being, so will have to wait a while to up it further.
Anyone have any advice?
So I was previously a pretty heavy smoker to the point where I never really felt satisfied by a high. Nothing really gave me the same sense of zoned out bliss I used to get when lighting up. Now I haven't smoked in almost a month, but I've taken edibles a few times instead. On Friday and Saturday I took fairly large doses (200MG on Friday and 300MG in two sittings on Saturday).
Whilst I got a very pleasant high from both doses, I still felt more clear-headed than I wanted to. Like, 300MG is a lot for edibles right? Even for experienced smokers? I did take the two 150MG doses a few hours apart, which I'm sure had an impact. Would you have advised taking it all in one go to really land on another planet? Lots of people suggested being careful and upping my initial amount slowly, so I did. But I can't really afford any more for the time being, so will have to wait a while to up it further.
Anyone have any advice?

as someone seasoned in psychedelics (DMT, LSD25+50, Psilo., 2-CB) these things i've learned, when I take LSD i always make sure I have a way out, usually diazepam but any benzo will work, LSD lasts 12 hours and if youve ever had a tab, think its shit take a bigger one and the first one starts kicking your ass, that's a bad feeling man, gotta have a way out, mushrooms don't last as long as LSD and they have stronger visuals and won't fuck up your ego too bad. (people think loss of ego is great, but you need an ego) I would always recommend starting with a few grams of liberty caps and if you like it, take LSD but if you think your mentally strong and can handle LSD I wouldnt go above 200 i forget the units either ug or mmg, but microdots are usually 80 and they are crap, need like 3. but if you get a good tab like a hoffman or something then make sure the first one has fully hit you before taking any more! stay safe bros

to expand on the post i feel lsd lasts too long, 4-6 hours would be plenty but 12 hours is tedious man, when it gets to hour 10 you're just like fuckin end already, LSD is overrated.

the best way to get psychedelic trips is to order a Liberty cap growing box with spores in it, then you can grow and harvest the mushrooms yourself. the strongest and best psychedelics grow in uk (liberty caps) you can find them in local park in like september.

The advice is use a drug designed for the purpose, DMT is a wild ride man. Most edible dose I’ve had was 600mg and I was fucked but I was drinking as well, imo spirits plus high dose of weed does give a very trippy high, that was the closest I’ve got from weed to truly tripping out but it wasn’t very pleasant, more nauseous and dizzy so it can kind of be done but I’d rather use a drug made for your goals.

I find edibles hit and miss. The ones i make myself tend to be the best. BUT i have found some wonka bars that absolutely knock the socks off me! Each square is 68mg and 3 squares hit me like a freight train! Chooo Chooooo! :D

They were the new gummy bears from TGT, who seem very reliable - suppose they might've been a weak batch though.

Your receptors are fried mate, youll never reach those heights again but you might be able heal it a little bit.
i suggest smoking salvia divanorium , doing a 30 day water fast and on the 30th day doing shrooms, about 5g dried.
i suggest smoking salvia divanorium , doing a 30 day water fast and on the 30th day doing shrooms, about 5g dried.

It cleans out the receptors, also has anti-addction properties.
I agree its not an enjoyable experience.
I agree its not an enjoyable experience.

What happened man? I'm guessing it was bad but was it more than your average whitey?

Blacked out in my bedroom and came to in the kitchen. Felt like I was stuck to the wall. My mate thought someone was dunking his head under water. It was too intense. I’ve bonged mushrooms before in Dam but this was something else. I ended up under my duvet hiding as I was tripping my nut off!

It wasn’t ideal but quite funny looking back. Felt a bit like Smokey when he smokes angel dust in the film Friday!

You really think? I've never heard of that happening... Also, how do you even do a 30 day water fast?
Apologies if you're just kidding, I don't want to assume either way though.
Apologies if you're just kidding, I don't want to assume either way though.

The salvia cleans out the receptors and theres not much Chrism+Psilocybin cant fix.
https://universaltruthschool.com/syncretism/raising-the-chrism/
https://universaltruthschool.com/syncretism/raising-the-chrism/

1 post
+3 votes

on
RebelTactics
Not happy with vendors on LB!
They have taken a resource that costs nothing to produce and made it worth a small fortune, follow the money.

on
RebelTactics
Not happy with vendors on LB!

Pifft, I ain't got enough money to feed my gluttony, haha. Too many vendors don't deliver where I am either. Sorry for the clickbait title but I'm salivating here. No issue with vendors whatsoever, just needed to get that off my chest. Stay safe everyone

Ha ha ha ha.....I know that feeling man...every time one of the vendors drops a really tasty looking strain when I'm skint I'm like 'ahhhhhh....you fucker' lol
Are you an Emerald Isle man? Feel for those guys...(and you if that's you too) the post checks seem to be very tough in comparison to elsewhere and I have seen so many threads asking for good suppliers...I swear if someone could set up shop there they could make a fortune...
Are you an Emerald Isle man? Feel for those guys...(and you if that's you too) the post checks seem to be very tough in comparison to elsewhere and I have seen so many threads asking for good suppliers...I swear if someone could set up shop there they could make a fortune...

Yea, gonna try and get my reg plug to set up on here but might be a hard sell, haha. You're right on my location. The Catholicism is a hard one to shed hence the over-reaction. Gardaí are usually delighted with themselves for busting someone with two grams, making big deal on facebook like they saved the world, haha

Yeah man... I have spent some time there over the years.. your police are on some mad things brother!! I seen them Gardai turn a blind eye to a fella smashing the fuck out his Mrs but then in the local paper bragging cos they nicked a ‘dealer’ with £100 worth of resin?! Mad things... I feel for you man.
Where I am people get off with warnings and cautions for quite big amounts with weed because the local class a game is madness... feds round here would probably be happier if everyone was just smoking weed...
Where I am people get off with warnings and cautions for quite big amounts with weed because the local class a game is madness... feds round here would probably be happier if everyone was just smoking weed...

Hope you enjoyed your time here. I was just being funny, or at least trying to be, with the Catholicism jibe, but it is hard to think of a good enough reason why they would turn a blind eye to some madness, and go balls to the wall for someone who ultimately just wants to mind their own business.
There's definitely a few who realise that greenery ain't that bad, but few and far between here. Not exactly great timing but need to relocate to somewhere I can enjoy my hobbies with no fear.........from people who are ultimately in fear
I'm getting too old to be hiding from the law, haha
There's definitely a few who realise that greenery ain't that bad, but few and far between here. Not exactly great timing but need to relocate to somewhere I can enjoy my hobbies with no fear.........from people who are ultimately in fear
I'm getting too old to be hiding from the law, haha

They have taken a resource that costs nothing to produce and made it worth a small fortune, follow the money.

Ah sure they have admitted to falsifying numbers, and hints of bribery, and yet the commissioner at the time gets a job promotion. I wish I could turn to my boss, tell em I'm breaking the law and get a promotion, but if they found out I have a little smoke I'd be fired

Ah it was ups and downs to be honest man - I was living in the North for a while...got sent there for something and really didn't have any idea what I was getting into...rocked up and the lads took me round and it was all like 'ay this here is a peace wall'...I'm like no shit...not getting over that fucker to disturb the peace eh!??!
People were top - fucking love you fellas - best craic on earth - never met so many consistently funny, down for laughs fuckers honestly. Sorry to hear that you all have so much trouble getting decent smoke, must be fucking murders sitting on here and seeing all this weed, we need to get some pablo escobar tunnels going over to the Isle!
People were top - fucking love you fellas - best craic on earth - never met so many consistently funny, down for laughs fuckers honestly. Sorry to hear that you all have so much trouble getting decent smoke, must be fucking murders sitting on here and seeing all this weed, we need to get some pablo escobar tunnels going over to the Isle!

Can be a mad place alright, especially if you aren't prepared, haha. That's cool, good to hear. I'm not too bad for the most part, but there is a lot of dirt weed, people don't even cure their buds here sometimes. Hahahha, those tunnels might have to happen

Based in the Emerald Isle, A.K.A. Éire, A.K.A. Ireland. Hey, it's understandable with the way our customs are. Can't blame a vendor for not wanting to take the risk

Can i ask, why such a risk where you are compared to elsewhere? Id ship, but dont do re-ships.

Less population, and less population density, so it is an easier job for customs compared to other countries. They also get a hard on for confiscating weed and bigging it up like it's the deadliest thing in the world.
https://www.thejournal.ie/cannabis-dublin-covid-19-wedding-cake-5082138-Apr2020/
Do they think heroin junkies are taking a break because of the Covid, likely not. I also do not think they can afford to stock up. This article above would be a marketing campaign in a country where it is legal. This is time wasting when the worst that can happen, even if you're a first time user, is a panic attack. They are researching, investigating and contacting the media. Resources better spent elsewhere.
Giving out people aren't taking isolation seriously, and on the other hand furious that some people are happy to be stuck to the couch after a doobie or two, haha. Where are they getting this shite from.
Gardaí are also very corrupt.
https://www.independent.ie/irish-news/courts/garda-selected-for-an-early-westlife-line-up-guilty-of-cocaine-possession-38320317.html
https://www.irishtimes.com/news/crime-and-law/four-garda%C3%AD-suspended-over-kildare-nightclub-cocaine-inquiry-1.3383272
https://www.thejournal.ie/garda-internal-investigation-drug-dealer-5083057-Apr2020/
I have a video of a garda pulling someone over and when the driver acknowledges the cocaine on the gardas nose, the garda quickly changes their tune. They are scum, not because they do drugs, but because they took an oath and have no problem breaking it; zero integrity. At least I'm not living a big fat lie, and duping people every day.
The garda commissioner was caught falsifying numbers and stats and ended up with a promotion, lol. Basically vilify weed as everyone smokes therefore it's easy to bust and report in media to make yourselves look good, distracting people from all the cocaine gardaí are consuming
https://www.thejournal.ie/cannabis-dublin-covid-19-wedding-cake-5082138-Apr2020/
Do they think heroin junkies are taking a break because of the Covid, likely not. I also do not think they can afford to stock up. This article above would be a marketing campaign in a country where it is legal. This is time wasting when the worst that can happen, even if you're a first time user, is a panic attack. They are researching, investigating and contacting the media. Resources better spent elsewhere.
Giving out people aren't taking isolation seriously, and on the other hand furious that some people are happy to be stuck to the couch after a doobie or two, haha. Where are they getting this shite from.
Gardaí are also very corrupt.
https://www.independent.ie/irish-news/courts/garda-selected-for-an-early-westlife-line-up-guilty-of-cocaine-possession-38320317.html
https://www.irishtimes.com/news/crime-and-law/four-garda%C3%AD-suspended-over-kildare-nightclub-cocaine-inquiry-1.3383272
https://www.thejournal.ie/garda-internal-investigation-drug-dealer-5083057-Apr2020/
I have a video of a garda pulling someone over and when the driver acknowledges the cocaine on the gardas nose, the garda quickly changes their tune. They are scum, not because they do drugs, but because they took an oath and have no problem breaking it; zero integrity. At least I'm not living a big fat lie, and duping people every day.
The garda commissioner was caught falsifying numbers and stats and ended up with a promotion, lol. Basically vilify weed as everyone smokes therefore it's easy to bust and report in media to make yourselves look good, distracting people from all the cocaine gardaí are consuming

That sounds like a right ordeal.
They need to stop criminalizing people for a sodding plant, it really rattles my brain.
However, the risk seems to be on the buyers part, not the sellers. If your willing to take the risk, i will post to you.
Good Luck out there, in that wild wild world.
GF
They need to stop criminalizing people for a sodding plant, it really rattles my brain.
However, the risk seems to be on the buyers part, not the sellers. If your willing to take the risk, i will post to you.
Good Luck out there, in that wild wild world.
GF

I'm waiting on two orders at the moment, but will give you a look in next time I'm ordering. I completely understand it is I who is taking the risk, this is part of the game unfortunately, take it or give it up, haha

Ahha, I misunderstood from your post, i thought you were implying the risk was on the vendor. Glad you found someone who will ship your way anyway Rebel. (Y)
GF
GF

Ah not at all. It has nothing to do with the seller, all they can do is their best with stealth and pop it in the post. It sucks, but it's always been the way really, even in real life deals


sounds like you wanna get some gorilla locations scoped out for summer... seed's are legal rite?

Lets be honest and reasonable here though, were all regular tokers so have a definite bias and for most of us the 20%+weed we have a tolerance for. First time I tried it though I was a bit fuckkkkk this is too strong and I slept for the day lol. But what if a younger person gets their hands on this stuff and has a good toke, gets to like it. Are we honestly saying we dont think this is going to effect their physical and mental development in any way? Im not so sure.....Just trying to be open and reasonable yknow :)

Sorry to hear it rebel, my pal has ps2 buddies in the isle pleading for deliveries, Irish post is terrible though. Im not sure its even about stealth-even when sending legitimate items, its like they get redirected through the Bermuda Triangle!

Yeah of course. I must be stoned as I should have seen it worked that out for myself lol.

1 post
+1 votes

on
Dre1838
Hybrids
The high you get from cannabis can vary alot from diffrent strains, maybe theres potential by selective breeding for the weed to evolve.

on
Dre1838
Hybrids
Thanks for the inputs far on my last question.
So Hybrids??
Worth it????
Kind of doesn’t make sense to me unless you experts can tell me otherwise.
Any particular strain to head for?
So Hybrids??
Worth it????
Kind of doesn’t make sense to me unless you experts can tell me otherwise.
Any particular strain to head for?

The high you get from cannabis can vary alot from diffrent strains, maybe theres potential by selective breeding for the weed to evolve.

Some people like the head buzz of sativa, a “cerebral high” but it can be too stimulating and anxiety inducing for some people
These strains I say are highly creative hence the stimulated imagination leading to negative overthinking. You use these strains for day time and social occasions or on personal projects
Some avoid sativas altogether because of paranoia
Indicas are couch lock inducing relaxation that can be crippling when needing to stay active to do things but perfect for those moments when rest is needed the most
There’s some speculation wether it’s as black and white as that well some might swear by the balanced 50/50 hybrids as the best of both worlds...wether that is subjective or depends on variables is unclear to me
My advice is to think about what you want and look up reviews on leafly of the strains you can buy beforehand so you can choose wether the effects suit your needs
These strains I say are highly creative hence the stimulated imagination leading to negative overthinking. You use these strains for day time and social occasions or on personal projects
Some avoid sativas altogether because of paranoia
Indicas are couch lock inducing relaxation that can be crippling when needing to stay active to do things but perfect for those moments when rest is needed the most
There’s some speculation wether it’s as black and white as that well some might swear by the balanced 50/50 hybrids as the best of both worlds...wether that is subjective or depends on variables is unclear to me
My advice is to think about what you want and look up reviews on leafly of the strains you can buy beforehand so you can choose wether the effects suit your needs

Cheers Smee, I really appreciate the detail.
Just got back on the website been off for a while.
Just got a scare with the Border Police for importing Truffles from Holland.
Think there on me now.
Just got back on the website been off for a while.
Just got a scare with the Border Police for importing Truffles from Holland.
Think there on me now.

I am in the Uk and a friend in Holland works for a Magic Mushroom company and sent me over some goodies but customs found them.
Gutted normally they come through fine.
I don’t have any good contacts in the Uk for them.
Gutted normally they come through fine.
I don’t have any good contacts in the Uk for them.

1 post
+1 votes

on
{rap}
Is Lil Peep Rap?
Its mumble rap
"Jared leto is the mumble rap joker."
Straight up bollocks. Big L and Prodigy would be turning in their graves lol. Mumble rap from sound cloud rappers saturating the hiphop market terribly right now. I’m looking forward to that k-dot album drop hopefully sometime very soon

I call it Soundcloud Rap but lots of its also called mumble rap.

Yeah unfortunately it falls into the ever growing rap genre these days lol. I guess it's emo rap or something. Even though he sings over like trap beats. I can't stand it but I did watch the documentary on this dude and I really felt for him so I have a new found respect for him.

There’s only two genres in music. Music that you connect with and music you don’t. If you connect with it who cares if it’s rap, country and western, Bavarian folk trap etc

1 post
+4 votes

on
abbz
T Break ?
Lol sounds like you need a lower dose rather than a tolerance break.

on
abbz
T Break ?
Baked everyday from the 10/04 to around the 07/05
My sess on the 7th resulted in serious heart palpitations and paranoia ... Managed to calm myself down and have been on a break for around a week now
Has anyone else experienced this ? If so, how did you handle it ?
Also, any guidance on how long to t break and anything else done inbetween ?
✌
My sess on the 7th resulted in serious heart palpitations and paranoia ... Managed to calm myself down and have been on a break for around a week now
Has anyone else experienced this ? If so, how did you handle it ?
Also, any guidance on how long to t break and anything else done inbetween ?
✌

If you don't already, try smoking pure without tobacco. I started to get anxious, paranoid and felt like my heart was about to burst out of my chest when I was high from spliffs but that all went when I cut tobacco out completely. If you already do smoke pure, lay off the sativas and go for something more balanced or indicia dominant or something with less thc %.
Exercise helps scrub out residual THC from your body so is a great idea as you're already abstaining at the moment. If you want to smoke up again in the future, take the equivalent of 1 hit of whatever your blazing and wait for the effects to come, if they don't take another hit and wait again. Repeat if necessary, you'll be surprised at how little you'll need to smoke to feel nice and high. Using this method after 2/3 days of not smoking anything is a great way of lowering your tolerance.
Exercise helps scrub out residual THC from your body so is a great idea as you're already abstaining at the moment. If you want to smoke up again in the future, take the equivalent of 1 hit of whatever your blazing and wait for the effects to come, if they don't take another hit and wait again. Repeat if necessary, you'll be surprised at how little you'll need to smoke to feel nice and high. Using this method after 2/3 days of not smoking anything is a great way of lowering your tolerance.

Hi Abbz
I already experienced those heart issues and take it easy ; you might need less thc or something different for your need.
But experiencing such effect looks like a kind of warning, so pay attention to yourself.
Stay safe
I already experienced those heart issues and take it easy ; you might need less thc or something different for your need.
But experiencing such effect looks like a kind of warning, so pay attention to yourself.
Stay safe

Thanks for responding
I read somewhere else that the THC content is a factor
Will purchase a lower percentage next time
I read somewhere else that the THC content is a factor
Will purchase a lower percentage next time

Hey abbz, When you smoke enough you may often experience some unfavourable effects too like dry mouth, anxiety, heart palpitations, and heart palpitations can be made worse by anxiety.. what have you been smoking? My partner sometimes finds sativa a bit too much.
My advice, too much of anything is too much.
My advice, too much of anything is too much.

Been dabbling in a lil bit of both, sativa and indica
Will scale back a lil more and find lower THC strains
Thanks for getting back
Will scale back a lil more and find lower THC strains
Thanks for getting back

Using a vape ( I use the pax2) on a low temp will give you a nice chill without such pronounced psycological stuff. Ive had days where ive had the pax on low /med and not reallyfelt like i got high then when out doing my business i notice how im lifted, happy, positive. Its subtle but its really nice, and the weed lasts way longer as opposed to just blazing the same amount in a bowl.
You can manage your high by starting low and building on that as much as is required in any given moment. It doesnt matter what thc content it is as you can keep it low and only take a few hits without wasting a whole bowl if its really strong.
I use the vape on low as a kinda alternative to a break - I prefer that to a total break, 420 till i die hah! After vaping on low when you a have pipe or bong etc youll have a nice hard hit. Manage it all from there and interchange.
Also, check out some books on the mind and the ego if you havent already. Jiddu Krishnamurti, Eckhart Tolle, Ram Dass, Bruce Lee. That helps put what is happening when you get paranoid into perspective.But be carefull, they will also tell you that you dont need drugs... haha
All the best my friend. Peace!
You can manage your high by starting low and building on that as much as is required in any given moment. It doesnt matter what thc content it is as you can keep it low and only take a few hits without wasting a whole bowl if its really strong.
I use the vape on low as a kinda alternative to a break - I prefer that to a total break, 420 till i die hah! After vaping on low when you a have pipe or bong etc youll have a nice hard hit. Manage it all from there and interchange.
Also, check out some books on the mind and the ego if you havent already. Jiddu Krishnamurti, Eckhart Tolle, Ram Dass, Bruce Lee. That helps put what is happening when you get paranoid into perspective.But be carefull, they will also tell you that you dont need drugs... haha
All the best my friend. Peace!

I would like to add though, that if pronounced a full break is still a good idea! Nothing worse than paranoia, depression etc. The point on exercise is true too. I find getting stoned then exercising gives me a more productive high. I have a vape or smoke right before so i dont have time to get sluggish haha.
Take care Abbz :) Much love
Take care Abbz :) Much love

dabbing sucks IMHO, the high is ephemeral and that makes it addictive. throw in the impurities from production and you and you turn weed into something more toxic on every level.

don't agree with you bro, nobody forces you to dab a massive globs you can micro dab as well or use dabpen. what impurities are you talking about? are we talking about dabbing shatter, distilate, batter, diamonds etc? and we are comparing to smoking weed or vaping weed?

I find sativa can make me very paranoid, a nice hybrid seems not to have the same effect, but still gives me the sativa high that I enjoy.

I stick to indica now never had the heart palpitations but got them all the time with sativas

This happened to me when I had a bad batch of carts once too. Not sure if you’re smoking flower but just something to think about!

1 post
+2 votes
4sure: Weed On Other Planets
Is there life on other planets, and can it get us high? asking the right questions xD

4sure: Weed On Other Planets
Hear me out if theres intelligent life on one of the many other planets like this one they gonna be stoned on something so..
Now imagine if we could get our hands on some of that shit.
Now imagine if we could get our hands on some of that shit.

Is there life on other planets, and can it get us high? asking the right questions xD

1 post
+2 votes
Head transplants are here
Lol the bald guy is such a mad scientist cliche

Head transplants are here
A very big step on the road to post humanism

Very interesting. Would there ever be such a thing as your head is you but we can change any body part we like so it would be a body transplant.

Chill, dude, "Cooling the brain can delay damage for up to an hour—just enough time, perhaps, to transplant a head" :)

1 post
+2 votes
wow
I think it depends on the ratio of oil to plant matter used.

wow
This looks great. Only worry is oil looking for an escape in transit, would it be completely leak proof?. I love the sounds of this, because then i can infuse my baked cookies, or cakes with ease. What would the dosage be though? e.g how much cannabutter to a box of brownie mix?

surely there is a mistake with the listing.. it says approximately 30g of bud has yielded 300mg? That would mean each gram pitched in around 10mg of goodness. I would have expected more like 150-200mg per gram of decarbed bud, assuming thc levels for those strains are at around 15-20%.
What do you reckon UKGrower?
What do you reckon UKGrower?

Yep, if you look on my page, I do 28g of decarbed bud, it's all my bottom buds grinded up in the blender then decarbed.
I add one full ounce of this to 1 full jar of oil in a vac pack and simmer in my sous vide for 3 to 4 hours, then its sits for a few more
Its amazing how little 28g of bud ground up looks.
Oh and Im no posh fucker with my sous vide, I only bought it for my canna making recipes :-D. :-D
I add one full ounce of this to 1 full jar of oil in a vac pack and simmer in my sous vide for 3 to 4 hours, then its sits for a few more
Its amazing how little 28g of bud ground up looks.
Oh and Im no posh fucker with my sous vide, I only bought it for my canna making recipes :-D. :-D

my apologies, it's my mistake. It says 300ml not 300mg. So your're saying there's 300ml of the canna coconut oil, and that fuck knows how strong that stuff is. But from the process described, it could be intergalactic lol
If taken from a dominant sativa I definitely would have interest in some of your decarbed bud, and maybe a pot of this coconut oil too. Feel free to message me any time
If taken from a dominant sativa I definitely would have interest in some of your decarbed bud, and maybe a pot of this coconut oil too. Feel free to message me any time

If it helps I’ve cooked up 7gs of decent bud and infused With coconut oil in the slow cooker about 130g of coconut I think. And that made me 20 blow your head off if you don’t smoke everyday cookies. I gave one to my neighbours and they shared one and one passed out and the other was loving life. I’ve got a mate who smokes once a week blew his head off.
So I’m going to say this would probs be banging but that’s my Experience...I can’t bring myself to cook up an oz In case I ducked it up! :)
So I’m going to say this would probs be banging but that’s my Experience...I can’t bring myself to cook up an oz In case I ducked it up! :)

1 post
+1 votes

on
sensiman
Does speed of smoking affect the high?
I know that when smoking tobacco, quicker puffs have a more stimulating effect and long deeply held puffs tend to be more sedating.
Perhaps the lung …

on
sensiman
Does speed of smoking affect the high?
Random stoned thought....alcohol consumed faster gets you more battered and faster.
I find that when I need to smash a joint down me quick for stealth reasons, I don't feel as high as when I take 15+ mins to smoke it down.... why? Anyone the same or not?
I find that when I need to smash a joint down me quick for stealth reasons, I don't feel as high as when I take 15+ mins to smoke it down.... why? Anyone the same or not?

A scientifically motivated educated guess would be a possible combination of a few things. I reckon the comment about stressing has some stead, cannabinoids are battling for superiority over stress hormones and create less of an effect.
I've learned recently that it seems like the lungs do 99% of their absorption DURING the inhale only, while the lungs are expanding. I found this very interesting but haven't delved too deep into it. But shallow, less relaxed and quicker breathing would nullify the lungs' full ability for absorption even if the breath was held (seemingly rather pointlessly). I'm feeling that this is likely the main answer to this. The lungs are actually fairly useless at even absorbing oxygen considering that's their job. A very small percentage is utilised with each breath so they don't have a flying start anyway. Less available lung space will very quickly hinder their ability. A longer and deeper draw also means a hotter ember and more smoke flooding into the lungs. I believe long, relaxed draws without any need for holding your breath for more than a second will hit you more than a larger joint would if chugged down quickly without full lung expansion on each breath. Try and let me know if it works! Focus on long full breaths after each breath without holding. Keep inhaling until you reach the end of each breath after toking and think about your breathing for just one joint. I really feel like you should feel more smashed and less dizzy.
I've learned recently that it seems like the lungs do 99% of their absorption DURING the inhale only, while the lungs are expanding. I found this very interesting but haven't delved too deep into it. But shallow, less relaxed and quicker breathing would nullify the lungs' full ability for absorption even if the breath was held (seemingly rather pointlessly). I'm feeling that this is likely the main answer to this. The lungs are actually fairly useless at even absorbing oxygen considering that's their job. A very small percentage is utilised with each breath so they don't have a flying start anyway. Less available lung space will very quickly hinder their ability. A longer and deeper draw also means a hotter ember and more smoke flooding into the lungs. I believe long, relaxed draws without any need for holding your breath for more than a second will hit you more than a larger joint would if chugged down quickly without full lung expansion on each breath. Try and let me know if it works! Focus on long full breaths after each breath without holding. Keep inhaling until you reach the end of each breath after toking and think about your breathing for just one joint. I really feel like you should feel more smashed and less dizzy.

I think if you put all the weed from your joint into a bong your question would be answered ;) That would certainly fuck me up more anyway!
I think with the example you've given, the reason why you've had to stealth smoke should be taken into account (ie you're in a rush or the feds are walking over). If you have to bun down a spliff quick, quite often it's in a more stressful situation, which could counteract the effect. When I was younger I remember once coming home from work angry and stressed. Drained a joint in 2-3 mins.... didn't feel anything!
I think with the example you've given, the reason why you've had to stealth smoke should be taken into account (ie you're in a rush or the feds are walking over). If you have to bun down a spliff quick, quite often it's in a more stressful situation, which could counteract the effect. When I was younger I remember once coming home from work angry and stressed. Drained a joint in 2-3 mins.... didn't feel anything!

I know that when smoking tobacco, quicker puffs have a more stimulating effect and long deeply held puffs tend to be more sedating.
Perhaps the lung can only absorb so much in a cretin period, who knows but i also find that rushing a jay doesn't get me as high as taking my time with it.
Perhaps the lung can only absorb so much in a cretin period, who knows but i also find that rushing a jay doesn't get me as high as taking my time with it.

I have no idea if it's true man but it certainly feels that way. I used to have to go for fly smokes out on the balcony and I could never get a real deep high going that way. However, a bong will always get me more stoned than a joint, even if the bong is 0.3g and the joint is 1g, that bong will always hit much harder.

Slightly off topic but any people making the mistake of inhaling too much when they puff. Apart from the extra lung damage they wind up filling their stomachs with air and getting stomach pains.

I'd imagine it's because when you are smoking quickly you aren't inhaling the smoke as deeply or holding it in your lungs as long, consequently, your body absorbs less weed

Holding the smoke in your lungs longer is a misconception, as soon as THC enters your body, it's instantly "absorbed"

But your understanding is a misunderstanding
There is a cut off point that holding it any longer doesn’t make a difference but you still need to inhale it right deep and hold for some time to get the most out of if...I’ve proved this to myself over time
There is a cut off point that holding it any longer doesn’t make a difference but you still need to inhale it right deep and hold for some time to get the most out of if...I’ve proved this to myself over time

When I smash it down quick my tokes are still the same I think, just not much chill time between tokes.
Wish I could get on with bongs/pipes, they have their time and place, as does vaping...I just always end up wanting a j
Wish I could get on with bongs/pipes, they have their time and place, as does vaping...I just always end up wanting a j

2 posts
+4 votes
Anyone here successfully kicked opiates?
Theres nothing better than chrism and psilocybin for repairing the mind.
https://universaltruthschool.com/syncretism/raising-the-chrism/
+ 2 more

Anyone here successfully kicked opiates?
I have been smoking heroin and fent and can not kick the habit. My situation does not allow a lot of support, its critical that I keep things private and i hate most forms of therapy anyway. I as just looking for someone else that maybe used cannabis or anything

Hey captain, I don’t know if I help or not but let me tell ya my story. It’s a little bit like forest gump! Honestly it does but I swear down hand on heart it’s the Gods honest truth, I won’t go fully into it but il just put the bits in that I can relate too.
Just a little background tho to start: I’ve always liked weight training since my uncle got me into it so have always worked out at the gym, I was 22 and half stone 6ft 2” so I was a big guy to say the least! At the beginning of May 2013 I had been training hard during the week and come down with a chest infection, I’m asthmatic too so as any asthmatic will tell you, if you get a chest infection it’s multiplied 10 fold in severity! I had it for 3weeks and I had a mad violent coughing fit that I couldn’t stop and it blew all of my lower back out, 3 discs where, trapped along with nerves, I was bedridden for 9 months and had to have 2 surgeries to try and fix it. It sort of helped but then in 2016, my lower back just naturally blew out again, so had to have a more severe surgery to fix it. It hasn’t fixed it cus I’ve been left with chronic back pain to deal with. The thing is since 2013 I have been on prescription meds which includes loads of opioids, zomorph 10, 30, 60mg, 500ml oramorph, diazepam. I have all those plus another 8-9 different nerve agents, MS treatment, antidepressants etc I’m taking like 8-12 tablets with 20ml or oramorph 3 times a day day every day so now my body has unwittingly become totally dependent upon all of my medications, if I miss out 1 treatment slot with my meds, I get severe withdrawals! And I do mean SEVRE!!! Like get the shakes and shivers, hot/ cold sweats, feeling extremely nauseous plus a whole host of other issues that make your body feel unbelievable I’ll!!!
I been toking on our lovely green erb for over 25 years, mostly recreational but for the past 7 months I have under my doctor’s advice been using it medically. Last year was one of the toughest years of my life, having to deal with multiple family deaths, work issues, financial issues, stress of trying to get our second property sold, health issues deteriorated badly, like real bad, my marriage and relationship with my wifey was falling apart and with my chronic back pain issues I could only work in the office for 3 days and work at home for 2 cus my body was breaking down bit by bit as the year went on. By the end of the year and the first 3-4 months of this year my back was causing so much pain that it was sending me deeper and deeper into severe depression. I was then made redundant in January and with all the crap going on I was going into deeper darker thoughts to the point where I felt suicidal.........,:
Yep! Things were that bad that I couldn’t cope and I wanted it to all end 8( it takes a fukin lot and I do mean a lot to get me wound up, but with all the stress and issues going on with my health, marriage etc I almost broke and cracked open! My thoughts were so so dark I had thought about ways to do it, you probably don’t wanna know all this shit but I’m going somewhere.
I visited a few websites for both the bad way to go and also the way to get support. Thing is during all this time of really bad negative thoughts and thinking bad things got changed.
What do I mean by that? Well it was while I was searching-the web for good and bad things I came across many instances whereby several people had gone through similar symptoms as I and issues.
To try help treat their conditions they where put onto medical cannabis by their doctors. This has drastically changed the now patients for the betterment. Those suffering with chronic pain and depression where helped significantly.
To the point whereby one patient who was in a similar medical and mental situation as me, was prescribed cannabis as a form of treatment. This helped them significantly to the point they could go about and return to a normal way of living.
But for me, I went to my doctor and they gave advice on using cannabis but they said that they couldn’t prescribe the medical cannabis, even though the laws where changed last November or the November before so that doctors could start prescribing weed. My doc gave me advice that I already knew so was let down again by them. So I find a few different sites that sold weed (I can’t get a prescription as yet, as from my research I need to get a referral by the docs and then you go off to a specialist center for treatment). I have been looking at it but it’s a very VERY expensive way to do it, like £2-3500 a month! I can’t afford that so finding LB has been life saving for me.
I now buy my weed on here, yep it’s still the non legal way to do it but I can’t go through that pain of my back blowing out.again. I been using cannabis as a treatment by having 5-6 2gram joints (I toke it pure in a joint, no tobacco) a day, this helps to combat all the negativity in my mind and body, sounds corny but it’s true! Toking certain strains recently has really helped me deal with my chronic back pain and mental issues, I have been able to reduce down some of my opioid medications. I have a long long way to go but I have started now and I’m able to do a hell of a lot more than I could do post surgery. I’m saying that having weed is helping me lower my pain levels and medications too. The other positive is finding the LB community, they have helped out without even knowing it, just being there for support and whatever. If you are struggling with ‘getting off’ then just lower your opioid levels bit by bit day by day whilst steadily increasing your consumption of the cannabis. I have found this to be the best way to lower my opioid dosages whilst staying in control of the pain levels. I will be doing this for a while, as the doctor said you need to go low and slow on your reduction of the opioids this way you can get your levels down and eventually you will be able to stop needing them. This will take a few years I know as I’ve tried before to lower my dosages and it takes ages, but persevere at it and you can do it. You just have to take it day by day and have a good support system, family or friends. Just know you’re not the only one thats suffering and you didn’t need to suffer alone either, the community on here can help you too.
I hope that this helps and not make you think I’m a crack pot!!!
All the best 8)
Just a little background tho to start: I’ve always liked weight training since my uncle got me into it so have always worked out at the gym, I was 22 and half stone 6ft 2” so I was a big guy to say the least! At the beginning of May 2013 I had been training hard during the week and come down with a chest infection, I’m asthmatic too so as any asthmatic will tell you, if you get a chest infection it’s multiplied 10 fold in severity! I had it for 3weeks and I had a mad violent coughing fit that I couldn’t stop and it blew all of my lower back out, 3 discs where, trapped along with nerves, I was bedridden for 9 months and had to have 2 surgeries to try and fix it. It sort of helped but then in 2016, my lower back just naturally blew out again, so had to have a more severe surgery to fix it. It hasn’t fixed it cus I’ve been left with chronic back pain to deal with. The thing is since 2013 I have been on prescription meds which includes loads of opioids, zomorph 10, 30, 60mg, 500ml oramorph, diazepam. I have all those plus another 8-9 different nerve agents, MS treatment, antidepressants etc I’m taking like 8-12 tablets with 20ml or oramorph 3 times a day day every day so now my body has unwittingly become totally dependent upon all of my medications, if I miss out 1 treatment slot with my meds, I get severe withdrawals! And I do mean SEVRE!!! Like get the shakes and shivers, hot/ cold sweats, feeling extremely nauseous plus a whole host of other issues that make your body feel unbelievable I’ll!!!
I been toking on our lovely green erb for over 25 years, mostly recreational but for the past 7 months I have under my doctor’s advice been using it medically. Last year was one of the toughest years of my life, having to deal with multiple family deaths, work issues, financial issues, stress of trying to get our second property sold, health issues deteriorated badly, like real bad, my marriage and relationship with my wifey was falling apart and with my chronic back pain issues I could only work in the office for 3 days and work at home for 2 cus my body was breaking down bit by bit as the year went on. By the end of the year and the first 3-4 months of this year my back was causing so much pain that it was sending me deeper and deeper into severe depression. I was then made redundant in January and with all the crap going on I was going into deeper darker thoughts to the point where I felt suicidal.........,:
Yep! Things were that bad that I couldn’t cope and I wanted it to all end 8( it takes a fukin lot and I do mean a lot to get me wound up, but with all the stress and issues going on with my health, marriage etc I almost broke and cracked open! My thoughts were so so dark I had thought about ways to do it, you probably don’t wanna know all this shit but I’m going somewhere.
I visited a few websites for both the bad way to go and also the way to get support. Thing is during all this time of really bad negative thoughts and thinking bad things got changed.
What do I mean by that? Well it was while I was searching-the web for good and bad things I came across many instances whereby several people had gone through similar symptoms as I and issues.
To try help treat their conditions they where put onto medical cannabis by their doctors. This has drastically changed the now patients for the betterment. Those suffering with chronic pain and depression where helped significantly.
To the point whereby one patient who was in a similar medical and mental situation as me, was prescribed cannabis as a form of treatment. This helped them significantly to the point they could go about and return to a normal way of living.
But for me, I went to my doctor and they gave advice on using cannabis but they said that they couldn’t prescribe the medical cannabis, even though the laws where changed last November or the November before so that doctors could start prescribing weed. My doc gave me advice that I already knew so was let down again by them. So I find a few different sites that sold weed (I can’t get a prescription as yet, as from my research I need to get a referral by the docs and then you go off to a specialist center for treatment). I have been looking at it but it’s a very VERY expensive way to do it, like £2-3500 a month! I can’t afford that so finding LB has been life saving for me.
I now buy my weed on here, yep it’s still the non legal way to do it but I can’t go through that pain of my back blowing out.again. I been using cannabis as a treatment by having 5-6 2gram joints (I toke it pure in a joint, no tobacco) a day, this helps to combat all the negativity in my mind and body, sounds corny but it’s true! Toking certain strains recently has really helped me deal with my chronic back pain and mental issues, I have been able to reduce down some of my opioid medications. I have a long long way to go but I have started now and I’m able to do a hell of a lot more than I could do post surgery. I’m saying that having weed is helping me lower my pain levels and medications too. The other positive is finding the LB community, they have helped out without even knowing it, just being there for support and whatever. If you are struggling with ‘getting off’ then just lower your opioid levels bit by bit day by day whilst steadily increasing your consumption of the cannabis. I have found this to be the best way to lower my opioid dosages whilst staying in control of the pain levels. I will be doing this for a while, as the doctor said you need to go low and slow on your reduction of the opioids this way you can get your levels down and eventually you will be able to stop needing them. This will take a few years I know as I’ve tried before to lower my dosages and it takes ages, but persevere at it and you can do it. You just have to take it day by day and have a good support system, family or friends. Just know you’re not the only one thats suffering and you didn’t need to suffer alone either, the community on here can help you too.
I hope that this helps and not make you think I’m a crack pot!!!
All the best 8)

It has been tough Budlover and it still is, I feel it’s through these life experiences that help us to grow, sometimes you aren’t aware of it but people soon tell you.
Haha! How ironic! I’m just writing this and my reminder has just popped up telling me to take my evening dose! You couldn’t script it!!
Thanks man it’s appreciated 8)
Haha! How ironic! I’m just writing this and my reminder has just popped up telling me to take my evening dose! You couldn’t script it!!
Thanks man it’s appreciated 8)

Cheers mate it’s nice to be able to try and help where I can, with what I’ve been through if my experiences can help in protecting someone else from bad things then I’m all in. I hope my experiences are able to help out 8)

I don't know if this is relevant to you man but I was addicted to dihydrocodeine and pregablin. I was up to 30 dihydrocodeine twice a day and 7-8 pregablin. This all started after I was knocked off my bike and had to give up my job as a zookeeper. I started smoking weed again in 2016 as I was at my wits end and had considered suicide as my life was nothing more than waking up looking to get my fix of pills,slowly I have was able to taper of the opiates and start getting some life back. I am now clean of opiates and I think I owe a great deal to cannabis. Hopefully you have family and friends who can support you mate. PM me man if you need any help or just need to talk.

Personally I think if you’re telling a life experience like what we have gone through, it is really good insight into things like that that can change your whole life around in an instant. I’m glad you are free of them mate it’s hard work! 8)

Thank you captain, I try my best to stay positive cus I know the dark side literally! That dark place isn’t nice and is quite scary in all honesty. It’s a very long road ahead for me that will 99.99% be for the rest of my life as per the consultants opinions. Finding LB has helped in ways that most would not understand 8)

Smoke a bowl of salvia divinorum, it has amazing anti-addiction properties. research it.

I will be looking into that too, would be nice to find something that can help with the addiction, cheers 8)

Theres nothing better than chrism and psilocybin for repairing the mind.
https://universaltruthschool.com/syncretism/raising-the-chrism/
https://universaltruthschool.com/syncretism/raising-the-chrism/

I got seriously hooked on codeine and tramadol since I cracked a rib years ago. I’ve been taking weed for a year now and to me it really helps and I don’t have the fear of overdosing (I used to cold water extract which is very dangerous). Good luck.

1 post
+1 votes

on
UKlashnikov
Partially Paid
The bitcoin address is still valid if you still have it,

on
UKlashnikov
Partially Paid
So i made an order very early in the morning after just waking up. Clearly dreaming of bud lol
I chose my product and selected to pay extra for NDD, but i only sent enough coin for the product and forgot to send enough for the NDD. I have messaged the vendor to see how i can rectify as order is showing as partially paid. This all happened this morning. Is there a way to pay the extra? Anyone else experiance this before?
I chose my product and selected to pay extra for NDD, but i only sent enough coin for the product and forgot to send enough for the NDD. I have messaged the vendor to see how i can rectify as order is showing as partially paid. This all happened this morning. Is there a way to pay the extra? Anyone else experiance this before?

What ended up happening as I've just done something very similair except I sent what was missing right afterwards yet my order still says unpaid. Not even partially paid

I dont know about tip jar. I will check. Its with Radar Breeder. Never had issues before. Prob be ok. Thanks for help

Don't think radar has a tip jar, cut off is 12 midnight so dont think it would go out today anyways. May give you a bit of time to get it sorted. Radar is notoriously busy so i am not sure you will get a quick reply.
Ive never had a short payment but i believe you can just send the missing bit to the same bitcoin address you sent the funds to this morning.
Can another bigga confirm this?
Ive never had a short payment but i believe you can just send the missing bit to the same bitcoin address you sent the funds to this morning.
Can another bigga confirm this?

2 posts
+2 votes
I’m converted, life changing moment!
Cracking thanks mate.
+ 2 more

I’m converted, life changing moment!
So after nearly 30 years of smoking joints, my first Cart arrived from MJC this morning after ordering it yesterday. Luckily my battery also arrived from evilbay this morning at the same time. 4 puffs and I’m experiencing a high that would usually take a whole nights session of smoking joints. I’m now converted, thanks MJC you’ve changed my life.

I've just had a very similar experience, except having never used a battery before I blasted mine like I would the Mighty on my first toke, and that really wasn't the move! My throat is still recovering now, but having had it out again last night I know that if used right there isn't a problem.
For me this vape is a great addition, but I still can't help feeling that well dosed edibles are the pinnacle. When done right those are such a clean high. I'm thinking about baking. But what to use is quite a dilemma. The MJ distillate is definitely calling to me, as is some of the shatter and hash on here..
For me this vape is a great addition, but I still can't help feeling that well dosed edibles are the pinnacle. When done right those are such a clean high. I'm thinking about baking. But what to use is quite a dilemma. The MJ distillate is definitely calling to me, as is some of the shatter and hash on here..

Yes, you need to attach it to a vape battery, MJC has a link to the iMini off eBay for £12.99 below in one of the comments.

2 posts
+4 votes

on
{cannabis}
Who else loves being high but hates the Marijuana taste?
Think it could just be the bit you have that foul tasting?
you could try eating something sweet before smoking
+ 2 more

on
{cannabis}
Who else loves being high but hates the Marijuana taste?
Hi guys,
I'm pretty high right now, so I was wondering who else hates the taste of burning Marijuana.
I like to smoke spliffs (means mixed with tobacco for who doesn't know) because when I smoke a joint, every time I hit the joint, I feel like tickles on my throat and is really annoying, instead I hate the taste of spliffs when they almost finish to burn.
So, what abut you? =)
I'm pretty high right now, so I was wondering who else hates the taste of burning Marijuana.
I like to smoke spliffs (means mixed with tobacco for who doesn't know) because when I smoke a joint, every time I hit the joint, I feel like tickles on my throat and is really annoying, instead I hate the taste of spliffs when they almost finish to burn.
So, what abut you? =)

That’s what’s so good about LB, you don’t need the crappy street stuff anymore... the choice is unbelievable on here lol.. if you tried the strawberry Glue from LUD or any fruity strain from a top vendor you’d like the taste for sure and if you still don’t like them you’re probably better off doing edibles tbh mate.. it did take me at least 2-3 years to actually know what sort of strains I like and what I don’t.. before that I’d take literally anything and be buzzing lol

Although I have to admit that I mix it with tobacco and always use a menthol tip. So who knows exactly what I'm tasting lol.

Very similar, but I don't think they are made from cotton I used to buy the Swan menthol extra slim filter tips. TBH I'm not sure what they are made from. Of course now they can't be bought in the UK, but I still find ways of getting supplies. I've never just had a splif that is just weed with no tobacco either. That must be very strong. I've always smoked weed to mellow down rather than get too high.

I'm concerned about the fact that you use a real filter, do you know that filter is going to filter a lot of the goodies inside the smoke of the weed?
Even if you want to smoke just to mellow I recommend using a made hand tip (or a glass one) this way you'll get your dose with less quantity, ofc for these like us who smokes spliffs, this is bad because we'll gonna inhale also the unfiltered tobacco smoke
Even if you want to smoke just to mellow I recommend using a made hand tip (or a glass one) this way you'll get your dose with less quantity, ofc for these like us who smokes spliffs, this is bad because we'll gonna inhale also the unfiltered tobacco smoke

Flavoured skins are rougher to smoke I find, hemp skins for the win
The less things that’s in the smoke the better eg flavourings
The less things that’s in the smoke the better eg flavourings

Flavoured skins...you taste it on your lips if anything that’s about it
I don’t know what to say apart from I love my spliffs but my long addiction with tobacco is a stinking smelly curse lol
I don’t know what to say apart from I love my spliffs but my long addiction with tobacco is a stinking smelly curse lol

Think it could just be the bit you have that foul tasting?
you could try eating something sweet before smoking
you could try eating something sweet before smoking

Nah, isn't a problem, I'm accommodated with the taste so I just keep puff puff and drink water (or juice) when the taste begins to be really bad (usually towards the end)

I don't consume tobacco at all. It triggers bad headaches and migraine in my case.
I love smell and taste of all parts of the plant though.
Sometimes i even make edibles keeping the plant matter kkk
I never mix my joints unless it is after a loooong break and weed is too strong.
I mix it with dried lavender, rosemary or white sage that i also grow in my back yard.
Cheers,
V.
I love smell and taste of all parts of the plant though.
Sometimes i even make edibles keeping the plant matter kkk
I never mix my joints unless it is after a loooong break and weed is too strong.
I mix it with dried lavender, rosemary or white sage that i also grow in my back yard.
Cheers,
V.

1 post
+6 votes

on
jgas
$102 Dollars for 5 GRAMS.
£20 a gram, what a joke, the stuff literally grows like grass. American dispensaries have $50 ounces.
Just another way were being fucked by the gove…

on
jgas
$102 Dollars for 5 GRAMS.
I mean is thiis guy for real?!? 100 dollars for 5 grams of cannabis.
Incredible, disgusting prices tbh.
Honestly who needs a vendor like that round here ?
Incredible, disgusting prices tbh.
Honestly who needs a vendor like that round here ?

£20 a gram, what a joke, the stuff literally grows like grass. American dispensaries have $50 ounces.
Just another way were being fucked by the government who are the biggest growers of cannabis in the country, connect the dots, follow the money.
Just another way were being fucked by the government who are the biggest growers of cannabis in the country, connect the dots, follow the money.

LUD CANT EVEN GET ON THE WALL NO MORE BECAUSE OF SO MUCH FUCKING SHIT ON THE ITEMS & OVER PRICED WEED, BUT THANKS TO OUR LOYAL CUSTOMERS WE GET ON.
CHECK US FOR CHEAPER DANK, AS WE GROW PRICES GO DOWN, ALSO MONTHLY FLASH SALES (LAST ONE WAS 50 USD PER 7G. MOSTLY 10/10 STUFF FROM UK GROWN
CHECK US FOR CHEAPER DANK, AS WE GROW PRICES GO DOWN, ALSO MONTHLY FLASH SALES (LAST ONE WAS 50 USD PER 7G. MOSTLY 10/10 STUFF FROM UK GROWN

Hi jgas is that green finger your on about
If it was.?
Just seen it. I agree total rip off to be honest ..some prices on here
Are well to pricey..I could understand if it all was grade A+++++
But a lot of average stuff. Or low grade on here..heisen beard agrees
If it was.?
Just seen it. I agree total rip off to be honest ..some prices on here
Are well to pricey..I could understand if it all was grade A+++++
But a lot of average stuff. Or low grade on here..heisen beard agrees

I don't wanna mention any names. It's for all to see. I love this site. I am glad I found it and hugely thankful to all the vendors who have supplied me what I have payed for -Radar, JJ ect and all the other honest sellers. Thank you.
Things are a little sour for me now after being shafted recently by newer vendors. My only advice to new users would be beware of any new sellers and just use the established vendors.
Things are a little sour for me now after being shafted recently by newer vendors. My only advice to new users would be beware of any new sellers and just use the established vendors.

Hi jgas yes of course.there are some good vendors on here...ie TGT...radar breeder..and some others with just average stuff really..no names mentioned...
Sorry here about your experience with a vendor mate..but I feel..my opinion of course..us customers should know of any vendors that have shafted someone..coz it could happen again to someone else?..I'm sorry its happened to you..but we should know mate..:-)
Sorry here about your experience with a vendor mate..but I feel..my opinion of course..us customers should know of any vendors that have shafted someone..coz it could happen again to someone else?..I'm sorry its happened to you..but we should know mate..:-)

Lol where's the other 9 grams to go with it . Just think you would have to pay a fee as well for buying the bitcoin

Ye man for sure. It's gonna have to be some real.dank.
Not some plants grown by an amateur in his spare room.
Not some plants grown by an amateur in his spare room.


Should we not be trying the bud before we make damaging comments like this??
Pic is of PP.
GF
Pic is of PP.
GF

Listen, I didn't mention anyone's name and I only saying anything to help others not get stung like I did!!
Your price is to high imo which I am perfectly entitled too.
Your price is to high imo which I am perfectly entitled too.

You didn’t need to say any names with the title you have there pal.
I understand you got stung. But you haven’t been stung by me, you have never purchased from me. You therefore certainly shouldn’t be warning buyers away from ‘new vendors’ that would imply all of us.
Whilst you are perfectly entitled to your opinion, You should really be more clear with your writing.
GF
I understand you got stung. But you haven’t been stung by me, you have never purchased from me. You therefore certainly shouldn’t be warning buyers away from ‘new vendors’ that would imply all of us.
Whilst you are perfectly entitled to your opinion, You should really be more clear with your writing.
GF

Mate I have looked at your page a few times if your prices were lower I already would have bought from you.
It's simple business - price competitively.
You may well be straight up but it's gonna be difficult for me to take that risk again with anyone new.
Take it easy GF
It's simple business - price competitively.
You may well be straight up but it's gonna be difficult for me to take that risk again with anyone new.
Take it easy GF

Thats fine bud, no one said you have to buy from me. What i did say is.
A. Be clear with your writing before outing someone,
B. Dont write damaging comments about a grower you havent tried.
Ive had at least 2 strains on here @ under $60 an 8th, you must have missed those as they seem to go quite quickly.
GF
A. Be clear with your writing before outing someone,
B. Dont write damaging comments about a grower you havent tried.
Ive had at least 2 strains on here @ under $60 an 8th, you must have missed those as they seem to go quite quickly.
GF

A. I didn't say your name, so I didn't OUT anyone. You came on this thread. Ok.
B. No sorry I must have missed that bargain.
C. Don't lecture me please.
B. No sorry I must have missed that bargain.
C. Don't lecture me please.

Man I even asked for your address so I can send you a sample so you can make an informed decision on what your talking about.
You got upset because I gave you a response.
Never mind. Take it easy.
GF
You got upset because I gave you a response.
Never mind. Take it easy.
GF

I honestly didn't see that I'm only reading the thread.
All I can say is that is true GF has offered me a sample. I don't want it but it does show he is a straight up guy. So big up GF.
Maybe I was wrong, maybe all of your stains are absolute fire and worth that $20 a G. Who knows?! I can't risk it at that price for a new vendor.
It isnt your fault the price of weed has gone mad tho and I do appreciate that.
Fill your boots. Green is gold right now.
All I can say is that is true GF has offered me a sample. I don't want it but it does show he is a straight up guy. So big up GF.
Maybe I was wrong, maybe all of your stains are absolute fire and worth that $20 a G. Who knows?! I can't risk it at that price for a new vendor.
It isnt your fault the price of weed has gone mad tho and I do appreciate that.
Fill your boots. Green is gold right now.

I don't need it bro. But that's a great idea for other people that are thinking of buying.
Free samples for biggas? And not me either. Someone that's been here for ages and can vet you personally. I mean what's it gonna cost you five grams in stash? To send out 10 samples to the community and them we get some real feedback.
Stay safe GF take it easy man.
Free samples for biggas? And not me either. Someone that's been here for ages and can vet you personally. I mean what's it gonna cost you five grams in stash? To send out 10 samples to the community and them we get some real feedback.
Stay safe GF take it easy man.

Does look fire but you can get bud like that for 240 a ounce where Im at looks just as good as any cali

WOWZAAAAAA!
thats unreal what was it for....super duper triple dipple haze hash kush?
F"#! Me
Little Ben
thats unreal what was it for....super duper triple dipple haze hash kush?
F"#! Me
Little Ben

2 posts
+3 votes

on
Kev169066
How long do you wait till accepting Oder ain’t coming!!!
fucking hell you could have grown your own plant by now
+ 2 more

on
Kev169066
How long do you wait till accepting Oder ain’t coming!!!
Hi new to little biggy.Still no sign of an order that was sent 28th April when is it time to accept it ain’t coming and where do I go from there regards disputes etc? The vendor is telling me to just keep waiting it out but I have been getting other orders within days from other vendors no problem

during normal circumstances i allow upto 2 weeks, but during rona times, ive extended it to 4. ive had packages turn up in the 3rd and 4th week. as youre a new user, i wouldnt dispute it, id try and resolve it with the vendor first.. a transaxe dispute may not go in your favor as you havent built your rep up.

Still waiting on order from 29th turning up here.
Was just for a 1g sample so no great loss...still though :(
Ordered 2g sample the next day from same vendor which turned up very next day.
Messaged vendor n got no reply,says no refunds or reships on page so fair dos.
Considering circumstances I'll wait another couple of weeks in the hope it hasn't been pilfered by postman pot!
Was just for a 1g sample so no great loss...still though :(
Ordered 2g sample the next day from same vendor which turned up very next day.
Messaged vendor n got no reply,says no refunds or reships on page so fair dos.
Considering circumstances I'll wait another couple of weeks in the hope it hasn't been pilfered by postman pot!

A few years back I ordered from a Canadian website and had a package in limbo for 2 and a half months....I had given up on it and out of nowhere it arrived, I would give it a little more time but do find it odd so many of us have been waiting on missing orders from that date, I paid for signed delivery so would've thought it could be tracked to some extent, no custom letter yet so there is still hope...there are risks involved in this service but its still a kick in the arse when something like this happens....hope your order comes through pal

Waiting on one for the UK from 19th April, now 27th May. Waiting for another early May, have had around 8 successful deliveries since. Guess we’ve just gotta ride it out brothers

Exactly the same for me. Will be a month from tomorrow. I cant see it coming. Hate to go down to disputes, but what else can you do?

Not sure if anyone is in the EU but I was waiting since the 29th of april, kept on waiting and waiting and asked for an update on tracking. Said it was delivered the 7th of may. All this was lies as when I investigated further they told me that customs had seized the package on the 6th. Never sent me anything and I was just sitting there for weeks waiting like a fool. I am also waiting on another but I think it may be the same story.

Hi mate
I am in Europe and currently missing an oz sent 19th of April.
I just consider as lost and do not investigate except I was kindly offered a 50% reship after exchange with the vendor.
I wait for a letter from custom if it pops up but will not seek for the parcel as this might be risky or trigger issues.
Hope this helps and that you will not receive bad news
I am in Europe and currently missing an oz sent 19th of April.
I just consider as lost and do not investigate except I was kindly offered a 50% reship after exchange with the vendor.
I wait for a letter from custom if it pops up but will not seek for the parcel as this might be risky or trigger issues.
Hope this helps and that you will not receive bad news

My package is gone my friend it has been seized by customs I did not get a letter to tell me I would advise to check the tracking off vendor for your OZ if it said it was delivered then it is gone.

Thanks for answer and advise but I would rather keep the mistery on this one....as far as no cop comes @ home, I am fine.
Good day to you
Good day to you

Sometimes packages get delayed... Especially given these times. Recently i had a package take 3 weeks 2nd class. Its not common but it can happen. It could also be likely that the stealth wasnt up to scratch and the package has been intercepted. Its never guaranteed to turn up but with the more experienced sellers such as green team they tend to have more experience in avoiding any of these types of issues.

1 post
+2 votes

on
tigrrboxer
Just realised I say "these days" a lot -_-
Heres some alternatives so you can mix it up a bit:
-right now
-currently
-at the moment
These days I've been saying “recently” a lot
All we can talk about is these recent corona virus events directly or indirectly
The weather isnt even a topic of conversation no more lol
All we can talk about is these recent corona virus events directly or indirectly
The weather isnt even a topic of conversation no more lol

Heres some alternatives so you can mix it up a bit:
-right now
-currently
-at the moment
-right now
-currently
-at the moment

Hey maybe get ur king boxer to woof woof for ya....that way dog speak will be a good break from ur norm :) xxx

2 posts
+6 votes

Was just curious if there would be any interest in colonized substrates or spawn bags, from which one is able to grow shrooms at home.
I'm currently just colonizing a 45 ltr tub, happened to check online and a tiny plastic tub the size you would get from a takeaway, already colonized and ready to fruit is $35 bucks + delivery. I could do them for far less to the UK if there was a market.
I'm currently just colonizing a 45 ltr tub, happened to check online and a tiny plastic tub the size you would get from a takeaway, already colonized and ready to fruit is $35 bucks + delivery. I could do them for far less to the UK if there was a market.


So, I've got a few tubs on the go, and would be willing to send one to someone as a freebie, just to test viability for posting in future, as well as what sort of success can be achieved, the tubs actually have a couple of tiny shrooms developing, so they will grow.
All I ask is for feedback. I'll DM and see if anyone is game.
Hopefully I'll be sample this batch in a few days, my big tub is shrooming up nicely.
Fuck knows why the pic is upside down ?
All I ask is for feedback. I'll DM and see if anyone is game.
Hopefully I'll be sample this batch in a few days, my big tub is shrooming up nicely.
Fuck knows why the pic is upside down ?

Hey, yeah they have grown well, picked a few that had broken the veil last night and ate them raw, circa 25 Grams. Was a lovely experience, beautiful waves of energy flowing through me, but when I went to bed and stuck some music on (The Doors) things really came to life, I marvelled at how something I've grown could create such an amazing experience. At one point the muscles in my ass cheeks were twitching in time to the beat of the music, madness.

Definitely a market for these I’d try them in an instant. DM away bro I’d happily give a honest review. Either way I want to try them lol. Got well over 100 trip experience. Though smee seems like the master.

The master lol ive lost count on the journeys ive took...easily in the hundreds too
Say about 15 years on n off
Say about 15 years on n off

Happy to give a review for a freebie or happy to pay and still review bro either way I’d loves some shrooms

I think these would go down a treat on this site =) look forward to seeing how things go! its upside down ... just like everyone else will be after they get a few mushies on board haha

Yeah, whole grain cased cakes, wanted to give it a try, had spare grains and plenty little round tubs, but couldn't be arsed running out for another mono to bulk spawn. So stuck them in there with some coir, was hoping the added surface areas would maybe be fruitful. And it's looking like it could be a decent alternative.

You’ll be surprised
I’ve watched a mushroom grow from a few grain left over in a jar
Probably the only thing would be is maintaining moisture levels
Could opt for a mini mono also or a tray type style set up in a SGFC
I’ve watched a mushroom grow from a few grain left over in a jar
Probably the only thing would be is maintaining moisture levels
Could opt for a mini mono also or a tray type style set up in a SGFC

Yes yes and Yes. my mushie supply’s have dried up an I’m in desperate need to replenish. Please let me know when these are available GILLYBOP

There's definitely a market for shroom kits and cured shrooms on here. I would be first in line to buy multiples.

Cured shrooms by far the easiest to get to folk, but nothing better than getting a few flushes yourself for the same price, or more likely cheaper than 7G of dried.
I'll have a look into it over the next couple of weeks and see what I could do to offer folk a cheap way to get a decent amount of product for less $.
Cheers.
I'll have a look into it over the next couple of weeks and see what I could do to offer folk a cheap way to get a decent amount of product for less $.
Cheers.

Right here! Was thinking of ordering online from Holland but I'd much rather keep it domestic if I can help it.

Same here, but even UK sites I found posted from Holland. Customs have a habit of prioritising packages from certain countries.

How sterile is your technique?
You dont want to be deaing with back draft of complaints from contaminated kits
Pure nightmare that would be
You dont want to be deaing with back draft of complaints from contaminated kits
Pure nightmare that would be

Its a possibility something turn sour...can happen even tho a healthy spawn in theory should be contaminate resistant
Do you start from agar just out of curiosity? Are you working from isolate or just multispore
I just recently ventured into growing oyster mushrooms
Do you start from agar just out of curiosity? Are you working from isolate or just multispore
I just recently ventured into growing oyster mushrooms

I started off with a spore vial, colonized literally a shit ton of grain, also ran some BRF cakes, which work great but dont get the big time numbers that a bulk tub does. Grain bags are good as they can keep for months in a cool dark place without pinning, to use whenever you want, and they are huge bags, one bag enough to colonise a full 45 ltr mono with coir and verm.

Can also cut the bag open soak the grains overnight while you pasteurise some coir to case the grains after draining and boom boom...cubes dont even need cased, they’ll pin and grow straight from grain

I tried to grow some of these after buying a spore syringe just before xmas as a little blast from the past - some weird ass looking things grew out of that grow kit and I didn't dare take them! haha
Good luck with it and I will keep an eye out if any come up.
Good luck with it and I will keep an eye out if any come up.

Aye store in a fridge should halt the growth
Bulk even though its the term used it is also kinda of misleading term as it is only acting as water source...yield is dependent on the amount colonised grain firstly then genetics etc but im basically saying adding more and more bulk substrate doesn't mean bulkier yields
When you say 45lt that confuses me a bit cause well obviously first you and i know that doesn't literally translate to 45lt of bulk spawn
You may know this already...but it’s surely good reading for others who are interested
Could you give an estimate of the colonised spawn bag volume and the ratio of the bulk substrate you would use in your 45ltr mono and at what approximate depth would the finally laid substrate be?
Bulk even though its the term used it is also kinda of misleading term as it is only acting as water source...yield is dependent on the amount colonised grain firstly then genetics etc but im basically saying adding more and more bulk substrate doesn't mean bulkier yields
When you say 45lt that confuses me a bit cause well obviously first you and i know that doesn't literally translate to 45lt of bulk spawn
You may know this already...but it’s surely good reading for others who are interested
Could you give an estimate of the colonised spawn bag volume and the ratio of the bulk substrate you would use in your 45ltr mono and at what approximate depth would the finally laid substrate be?

1 post
+4 votes

on
{cannabis}
Cannabis and Covid 19
They been lying about cannabis for years im not inclined to believe them now, chances are cannabis probably cures it.

on
{cannabis}
Cannabis and Covid 19
Most of the articles that I have read say all of us are putting ourselves at more risk. Then I read this last night.
So my question to all of my Lovely Bloody Stoners is how may of us in the community have or have had the virus?
So my question to all of my Lovely Bloody Stoners is how may of us in the community have or have had the virus?

They been lying about cannabis for years im not inclined to believe them now, chances are cannabis probably cures it.

Work in a warehouse with 300 other people, not one confirmed case. Been vaping and using rso through out this pandemic no symptoms of the rona yet...

Nah at least not confirmed. Over 50 self isolated but there was no testing available at the time. Know a few that have been tested now but all came back negative

I'm pretty sure I had it (everyone else in my house did, including my young daughter who doesn't do social distance!) but basically no symptoms for me (like a very mild cold). My bro-in-law got hospitalised though. I smoke more weed than he does (but I'm mostly a vaper) but he only recently gave up cigs... Cannabis is actually a broncho-dilator, so could be seen as beneficial for breathlessness. But then again, smoke irritate/inflames the airways, so could make things worse, depending on your own physiology.

Glad you are good! Glad your bro got thru as well, but I wonder if he had still been smoking if it would have been a different outcome.
Spoken to a few mates and only 1 has had it (that we know of) but about the same in the terms of symptoms as you.
I’m hopping for once I’m actually benefiting my health! LOL
Spoken to a few mates and only 1 has had it (that we know of) but about the same in the terms of symptoms as you.
I’m hopping for once I’m actually benefiting my health! LOL

1 post
+2 votes

on
carverr
Super Silver or Lemon Amnesia? (Photo)
Looks like you got sent only ami mate

on
carverr
Super Silver or Lemon Amnesia? (Photo)

Can you tell by looking whether this is Super Silver or Lemon Amnesia?
I'm no budtender but aren't they pretty close visually? I'll leave it to you connoisseurs to tell me!
This is RB's offering and although a bit dry and quite large bits of stem throughout the affects are nice. On the affect & smell alone I'd say this is Lemon Amnesia?
I'm no budtender but aren't they pretty close visually? I'll leave it to you connoisseurs to tell me!
This is RB's offering and although a bit dry and quite large bits of stem throughout the affects are nice. On the affect & smell alone I'd say this is Lemon Amnesia?

Hard to say without trying it but the terpines look like lemon amnesia.
Silver haze is usualy much light green bud less orange terpines.
lemon amnesia got some silver genetics in her anyways
Silver haze is usualy much light green bud less orange terpines.
lemon amnesia got some silver genetics in her anyways

What up carver, Id say it was the amnesia from experience, I have the silver from RB at the moment and have a little amnesia on the way, but the silver is much lighter than your photo, not as much orange going on! Will upload a picture of both when it arrives buddy, until then, happy toking!

2 posts
+3 votes
Cheesemaster
started topic
+ 2 more
1 post
+1 votes
What can I do to preserve my grandmother before she dies?
Make sure she is properly cured and then put in air tight jar.

What can I do to preserve my grandmother before she dies?
My grandmother has cancer and even if she makes it she doesn't have more than 5 years to live realistaclly. I believe that some kind of immortality or radical life extension is coming but she isn't going to be able to participate so I wonder if there is something I can do to give myself a little hope if nothing else.

My gran died a couple of years ago and one of the biggest regrets I have is that I didn't talk with her about her life. My advice is spend as much time with her as possible, talk to her, learn about her (write things down if you need to) - and then keep her in your memories. Pass on your knowledge of her to the next generation. That is basically as close to immortality most of us get.

Exactly this! My gran died in 2014, one year shy of 100. She had seen a lot in her life, being born during World War One. I cherish the chats that we had. As I get older, I realise how privileged I was to have known her. Not only because of who she was but because she was born in another era and her stories and memories were real life history from a very different world to our own.

Record her talking about her life and memories, oral history vcan be an amazing gateway into the past.

I might be too old fashioned, but since you're talking about your grandma, that might not be a bad thing. Have you asked her how she feels about death? She might not want to be frozen, or otherwise kept from death. I've had to deal with death way too much recently. It's horrible, and my heart goes out to you. But sometimes dying people see loved ones who are already dead. Real, or imagined, I won't know for sure until I take that last trip. I've started to feel very selfish for keeping my sister on life support as long as I did. Personally, I really believe that death is just a transition. Regardless, I think spending as much time with her as you can, and even recording conversations with her would be a good thing. Whatever you choose, I wish you both well.

Plastication may very well be ready within 5 years and it looks not only better than cryonics but also free of any ties to discredited white rappers.

Wait you're gonna go with "plastication" because you think it has less embarrassing analogies than freezing?

It seems like a perfect idea, instead of fighting the long life of plastics we use this to preserve.
I imagine an undertaker could inject some plastics, use a plastic coffin and we could have masses of people preserved inexpensively.
Hard to find much on this though, Gwern's piece is pretty old
I imagine an undertaker could inject some plastics, use a plastic coffin and we could have masses of people preserved inexpensively.
Hard to find much on this though, Gwern's piece is pretty old

Does she want to be preserved? This can be a really big deal for her legacy and may freak out her family, it takes some fortitude to get past that.

this. I have a very hard time even talking with people about this basically they think it's a conceit to even consider it.

2 posts
+2 votes

on
{cannabis}
Painful
Im pretty much in the same boat, makes me really sad sometimes we have to go through all this bullshit and cant just walk into a shop like in america …
+ 2 more

on
{cannabis}
Painful
I'm new to the site and placed my first order last Wednesday, after doing lots of research. I've gone with from what I can see a very reputable vendor. I went with 1st class post which I'm now regretting. Watching the postman come and go every day without my package is painful. I ran out a few days ago and have nothing to smoke for 420! :(
What's everyone currently waiting on 1st class delivery ?
I'm thinking of placing a NDD order but want the first order to come through first.
I may have to go back to a street vendor if the postman doesn't come through soon!
Happy 420 everyone on LB
What's everyone currently waiting on 1st class delivery ?
I'm thinking of placing a NDD order but want the first order to come through first.
I may have to go back to a street vendor if the postman doesn't come through soon!
Happy 420 everyone on LB

At the moment the post is a bit of a lottery as to how long things take to deliver. It's because of the current issues. Normally 1st class post gets stuff to you within a couple of days. I'm waiting too, now 5 days even though my stuff was sent 1st class. The post office are working with reduced staff etc. I would say that NDD stands a much better chance of quick delivery but it's not guaranteed at present. That's my current experience and what I've learnt about what other people have said.
I wonder if it's worth vendors using DHL or similar, as they are delivering parcels very quickly. I got a parcel today from Amsterdam (no it's not what you are thinking!!), with books I ordered on Thursday. I did pay €13 for delivery though.
I wonder if it's worth vendors using DHL or similar, as they are delivering parcels very quickly. I got a parcel today from Amsterdam (no it's not what you are thinking!!), with books I ordered on Thursday. I did pay €13 for delivery though.

Yeah this virus is causing all sorts of problems, I suppose people are dying and I'm moaning about slow post. Puts things in perspective.
Hopefully it comes though soon! First order so just a bit nervous.
I hope you get yours soon as well mate
Hopefully it comes though soon! First order so just a bit nervous.
I hope you get yours soon as well mate

Just had something take 12 days 1st class off another site, NDD the way to go right now if it’s urgent.

My stuff arrived after 8 days. I know it was posted the same day I ordered it, so it's just the postal system at the moment. Everyone's stuff turns up after a short while, but it doesn't stop those thoughts of wondering if your parcel has been intercepted!! Lol. So anyone waiting just hang in there.

as a vendor im no longer offering 1st class due to the amount of waiting around messages I get... I have recently had people waiting over 7 days on first class. 1st class recorded makes A BIG BIG Difference. 1/3 DAYS

100% mate , I never ever get anxiety but when you got a ounce coming through the post for first time it’s scary , there were 3 police cars and 10 officers outside today, never usually on our street ever but couldn’t help but panic but raided a hour near ours. I ordered on Monday first class and now Friday , still hasn’t come but what can we do with this crazy pandemic , I meditate and the anxiety disappears.

A little update, my first class delivery took 8 days, I did another order NDD, took 2 days. If want your order quick go with NDD. Royal Mail have big delays so everything is taking longer

6 days mate, think I need to chill a bit. Seen people waiting longer. Just got no smoke:( defo NDD next order

Im pretty much in the same boat, makes me really sad sometimes we have to go through all this bullshit and cant just walk into a shop like in america or amsterdam.
fuck the uk goverment.
fuck the uk goverment.

Yeah hopefully things will change one day but I think we are a few years off anything happening in the UK. Roll on the day we have UK coffee shops :)
Have a good evening mate
Have a good evening mate

Same boat as you, UncleB. First order on Wednesday, 1st class, no sign of it yet. Have been looking at the RM network status, and things look pretty grim for them. Sure it'll turn up soon. 4/20 and not a crumb to smoke, but things could be worse ;)

They will show up guys! Just so slow atm! NDD is the way to go. I can recommend JJ and RB for this always 1-2 days delivery :)

Had all anyone else's stuff arrived? Please let me know and share your stories so that we all know what's going on, and let us know if 1st class tracked or NDD are in practice very much quicker. Or just share whatever you think is worthy or amusing cos I'm getting a little bored of lockdown. I'm not complaining though, it's for a very good reason and I still have my health. God bless all our fallen friends and god bless all our essential workers.

2 posts
+2 votes

on
{cannabis}
What should I do with my stems?
I hear good things about stalk tea.
+ 2 more

on
{cannabis}
What should I do with my stems?
Hey biggas!
I haven't been on LB much lately but I'm still around.
Anyone have any suggestions on what I should do with my stems? I've been saving them for awhile now and thought 420 day would be a good time to use them somehow. I'm a complete noob when it comes to doing anything with weed other than smoking it. I heard somewhere I could make bubble hash out of my stems but I've never smoked hash before and not sure I understand how to make it or even how to smoke it.
Any good suggestions and instructions on how/what to do with these stems would be greatly appreciated.
Hope you all are staying safe and healthy, and that your 420 day is lit!
I haven't been on LB much lately but I'm still around.
Anyone have any suggestions on what I should do with my stems? I've been saving them for awhile now and thought 420 day would be a good time to use them somehow. I'm a complete noob when it comes to doing anything with weed other than smoking it. I heard somewhere I could make bubble hash out of my stems but I've never smoked hash before and not sure I understand how to make it or even how to smoke it.
Any good suggestions and instructions on how/what to do with these stems would be greatly appreciated.
Hope you all are staying safe and healthy, and that your 420 day is lit!

some lunatics grind and smoke stems...the cellulose content in there will rip the throat off you if you do so....i would use them for butter or edibles but if its only stems you have and no trim...no...i would look at making a tea...or booze fuse ...if you drink alcohol...im no expert...just my experience...peace

Wait, you can collect kief from stems? I imagine if I ground them up it would be harder to distinguish between kief and ground up stems.

Na i put them in the freezer so it will make it brittle so the thc falls of thc from stalks is no different than fron the bud you just need a grinder with a crystal catcher depending on the quality of bud you should get golden kief from the stalks i could easily make rosin out of the kief i collect its good quality everytime

Na they might be some plant matter that gets through the crystal catcher but that would happen with bud so it makes no difference i stick them in the freezer for half an hour try and grind them as fine as possible put it in the grinder with a pound coin and shake but you would need a bagfull of stalks to make it worth it

Holy shit! I put my bag of stems in the freezer for like 4ish hours (forgot about them and ended up taking a nap). After grinding them all up I now have enough kief to smoke a bowl of just that! 420 day is gonna be so lit!
Thanks Rastaman!!!
Thanks Rastaman!!!

I told you its hard to waste when you realize what you can get from them i never waste stalks now

You dont need massive stalks just the ones that come out of the bud when you make a joint or bong i also save the leaves sometimes they are caked in thc

Put them in a bottle of vodka.
Leave it for a week.
Have a shot, good times.
Cheers BB
Leave it for a week.
Have a shot, good times.
Cheers BB

Weed and alcohol is a bad mix, as is mixing any depressants as its proven to cause brain damage.

Tea is another thought I had. I tried to make stem tea with milk about 5 years ago and it ended in a huge mess. Tea does seem like it would probably be the easiest option though.

Grind them up and collect the thc from them i had a bagfull what i saved for ages ended up with a grinder full of thc

Hemp milk or butter are your best bets here most likely - easier than trying to make hash and less likely to end up with unececessary plant matter if you properly strain it.
GC
GC

1 post
+1 votes

on
seagull1983
Weed that gives the feet and body tingles...
You might have had a bit that was spiced up mate.

on
seagull1983
Weed that gives the feet and body tingles...
Hi,
I can’t seem to get this feeling that I have previously got. I love it when lying in bed waiting for sleep. I can’t find my previous orders under my login so if anybody has this type of experience what are you smoking ? Currently using ice cream cake but it’s not doing the business. I’m in to the indicas whilst watching tv. Thanks
I can’t seem to get this feeling that I have previously got. I love it when lying in bed waiting for sleep. I can’t find my previous orders under my login so if anybody has this type of experience what are you smoking ? Currently using ice cream cake but it’s not doing the business. I’m in to the indicas whilst watching tv. Thanks

Its your tolerance mate, check out my latest review and it will give you what your looking for.

4 posts
+12 votes

on
{cannabis}
Reset your tolerance with Science
Its has amazing anti-addiction properties that are well documented in ancient cultures but not well studied in the modern day as of yet.
When you get…
+ 4 more

on
{cannabis}
Reset your tolerance with Science


After failing miserably to take a hard break, I'm going to try this method and see how I get on. Wondering if any biggas have tried anything similar?

Actually managed to take a month off before, first week was shit but then alright. Don’t think I could do it at the moment but will attempt a 48h before 420 :) cheers

Unless you have a link to a scientific study I'm calling bullshit on this one. Thc attaches to the CB1 receptors and salvia attaches to kappa opioid receptors.
The more you use these receptors the more the body will limit thier availability, so you get less of an effect. Stop the weed for a few weeks and the body turns the receptors back on.
The more you use these receptors the more the body will limit thier availability, so you get less of an effect. Stop the weed for a few weeks and the body turns the receptors back on.

I don't have that, so you may call bullshit - and for all I know it could be. Although I think all he said was taking a 48 hour break from smoking weed will lower your tolerance. I'm not so sure this would be worthy of a scientific study.

I'm just saying smoking salvia doesn't reset your tolerance, the only way to is by not using it for a few weeks. Less may work but remember it stays in your system for quite a long time which is why you can fail a roadside swab more than 48hrs after your last smoke.

Ok theres a “place” that “what we are” exists in and this reality is a manifestation or a projection coming out of it
The physical body is like a gateway to the manifestation, you feel yourself half of you in this reality and the other half connected to this other “place”
Words don’t really do it justice its rather quiet confusing to say the least...if there ever was an analogy it would be the matrix
All my trips have that similar insight
Words cant describe it really
The physical body is like a gateway to the manifestation, you feel yourself half of you in this reality and the other half connected to this other “place”
Words don’t really do it justice its rather quiet confusing to say the least...if there ever was an analogy it would be the matrix
All my trips have that similar insight
Words cant describe it really

Im with you bro, however I have recognised it through simple meditation, which has now become a constant. Simple in the sense that all that has to be done is stay in our beingness, and to do that nothing has to be done because that is what we all are. What you describe as the other place I have found is everybodies and everythings essential nature. The essence or source of all manifestation. It is absolutely undescribeable because to describe it would limit its infinitude....yet it is beyond infinity also. It is for each and everyone of us to dis/cover and as such it is the greatest blessing to be here in this human form as this is the greatest opppertunity to transcend it all and realise our essential nature. Shanti shanti shanti

Yes its like the place is us or we are it. Exactly part of this one huge thing but individually poking into this existence/dimension to have a this subject experience looking out
You could say i seen this while looking inward
You could say i seen this while looking inward

Yeah inward is about right haha. I feel its also important to recognise that any identity/attachment with manifestation is the root of all suffering. Eg. if you find yourself in a tight spot then check what you're sticking to and remember your true stance in it all. It is called by some enlightenment to completely disentangle from everything...and nothing ;)

I only ever tried salvia once, x10 I believe. My mate gave me a bong and for about 2 minutes I had the worst paranoid anxiety I have ever felt, but was also laughing manically and couldn't stop till it wore off. Oh I also felt like I was really small. Must have been a good 11 years ago now haha

Its has amazing anti-addiction properties that are well documented in ancient cultures but not well studied in the modern day as of yet.
When you get into the higher concentrations it becomes different gravy, ive had some whopper trips.
When you get into the higher concentrations it becomes different gravy, ive had some whopper trips.

of all the things I have ever done, salvia cooked me the hardest! Even now, still can't believe we bought it from a shop! was either the 60x or 120x, first bong, my whole world turned into a circus styled nightmare, we did finish the purchase over the course of the week but man, that was a complete other level! Im sure in the right settings amazing mental things could be achieved with it, but I was quite young, and it overwhelmed me like a motherfucker!

Theres a place isnt there lol
Tell you vague story, i was dealing with real serious negative thoughts and salvia smacked it outta the park...i did not expect that!
Tell you vague story, i was dealing with real serious negative thoughts and salvia smacked it outta the park...i did not expect that!

1 post
+2.2 votes

on
{cannabis}
Most economical way to consume?
When you eat cannabis it creates 11 hydroxy metabolite in your liver. It's 5 times more psychoactive than THC https://en.wikipedia.org/wiki/11-Hydrox…

on
{cannabis}
Most economical way to consume?
So I prefer to use a glass bong when I smoke, I think it gives you most bang for your buck. Especially compared to a joint, I’ll use probably 0.3g for the bowl and take smaller hits.
I’m hearing good things, in relation to this topic about vaporisers can anyone share some knowledge?
I’m hearing good things, in relation to this topic about vaporisers can anyone share some knowledge?

When you eat cannabis it creates 11 hydroxy metabolite in your liver. It's 5 times more psychoactive than THC https://en.wikipedia.org/wiki/11-Hydroxy-THC
shout out to joe rogan
shout out to joe rogan

I have a volcano vape, it tastes so fucking good I can't explain! It gets u fucked up too. Unfortunately I am used to the manky baccy in spliffs and find it hard to only vape as it's my only source of nicotine. Got a glass percolator bong too, like those hit s lot, quicker effect than vape, but vape is more cleaner feeling and I think lasts longer. Imo, don't get cheap vapes, as the taste won't be there. Volcano is pricey, but with good weed or hash taste is unbeatable and high is immense

If it’s efficiency you’re after then look at a dynavap - not expensive so a good place to start. You can even use it with your bong

2 posts
+6.5 votes

on
{nations}
How Governments Introduce Surveillance Under Veil of Coronavirus Control
How can we further cripple the lower class
+ 2 more

on
{nations}
How Governments Introduce Surveillance Under Veil of Coronavirus Control
If you give a mouse a cookie...

This virus is one big excuse to make us go cashless.
I was in pound land yesterday, Got 9 Quid worth of stuff, gave the till lady a tenner...
She asked me If i have change instead... I said no... she pulled out a pound coin from the endless amounts in her till... got me wondering about this theory.
I was in pound land yesterday, Got 9 Quid worth of stuff, gave the till lady a tenner...
She asked me If i have change instead... I said no... she pulled out a pound coin from the endless amounts in her till... got me wondering about this theory.

They used to create wars to cull and control us, now we are in the information age people aren't stupid enough to kill each other because propaganda tells them to so they have resorted to bio-warfare.

Hopefully it will be a war of words and bitch fighting for attention- like social media for countries. Actually its already started.

Never before have an entire global population been so scared and obedient. The ruling Elite really have outdone themselves this time.

1 post
+1 votes

on
2weeks
Sativa edibles
+1

on
2weeks
Sativa edibles
Good evening fellow lockdown buds :)
I've been enjoying various edibles from MJ, JJ etc all fab but mainly indica bias.
Can anyone point me in the direction for some sativa daytime delights?
I've tried dojo and they were great, anyone else do sativa?
Thanks very much
I've been enjoying various edibles from MJ, JJ etc all fab but mainly indica bias.
Can anyone point me in the direction for some sativa daytime delights?
I've tried dojo and they were great, anyone else do sativa?
Thanks very much

1 post
+3 votes
Mr Robot Beats All Your Shit
The first season was straight fire, clearly ran out of juice after that, what was whiteroses machine suppose to do? what did she show Angela? all kind…

Mr Robot Beats All Your Shit
best series out there if you exclude the 2 middle seasons.

The first season was straight fire, clearly ran out of juice after that, what was whiteroses machine suppose to do? what did she show Angela? all kinda feels like an ass pull tbh.

Defo, the creator esmail found bigger projects and malek won the oscar during seasons 2 and 3 but they came back as champions to finish it off on their own terms in 4. Just skip to 4 if you loved season 1. youll love it.

bigg topics